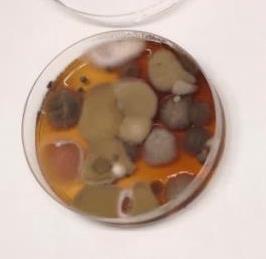
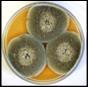

ACTA FACULTATIS XYLOLOGIAE ZVOLEN

VEDECKÝ ČASOPIS SCIENTIFIC JOURNAL



Vedecký časopis Acta Facultatis Xylologiae Zvolen uverejňuje pôvodné recenzované vedecké práce z oblastí: štruktúra a vlastnosti dreva, procesy spracovania, obrábania, sušenia, modifikácie a ochrany dreva, termickej stability, horenia a protipožiarnej ochrany lignocelulózových materiálov, konštrukcie a dizajnu nábytku, drevených stavebných konštrukcií, ekonomiky a manažmentu drevospracujúceho priemyslu. Poskytuje priestor aj na prezentáciu názorov formou správ a recenzií kníh domácich a zahraničných autorov.
Scientific journal Acta Facultatis Xylologiae Zvolen publishes peer-reviewed scientific papers covering the fields of wood: structure and properties, wood processing, machining and drying, wood modification and preservation, thermal stability, burning and fire protection of lignocellulosic materials, furniture design and construction, wooden constructions, economics and management in wood processing industry. The journal is a platform for presenting reports and reviews of books of domestic and foreign authors.
VEDECKÝ ČASOPIS DREVÁRSKEJ FAKULTY, TECHNICKEJ UNIVERZITY
VO ZVOLENE 66 1/2024
SCIENTIFIC JOURNAL OF THE FACULTY OF WOOD SCIENCES AND TECHNOLOGY, TECHNICAL UNIVERSITY IN ZVOLEN 66 1/2024
Redakcia (Publisher and Editor’s Office): Technická univerzity vo Zvolene (Technical university in Zvolen); TUZVO Drevárska fakulta (Faculty of Wood Sciences and Technology)
T. G. Masaryka 2117/24, SK-960 01 Zvolen, Slovakia
Redakčná rada (Editorial Board): Predseda (Chairman): prof. Ing. Ján Sedliačik, PhD, TUZVO (SK)
Vedecký redaktor (Editor-in-Chief): prof. Ing. Ladislav Dzurenda, PhD, TUZVO (SK) Členovia (Members): prof. RNDr. František Kačík, DrSc. TUZVO (SK) prof. RNDr. Danica Kačíková, MSc. PhD., TUZVO (SK) prof. Ing. Ivan Klement, CSc. TUZVO (SK) prof. Ing. Jozef Kúdela, CSc. TUZVO (SK) prof. Ing. Mariana Sedliačiková, PhD. TUZVO (SK) prof. Ing. Jozef Štefko. CSc. TUZVO (SK doc. Ing. Hubert Paluš, PhD. TUZVO (SK)
Jazykový editor (Proofreader): Mgr. Žaneta Balážová, PhD. Technický redaktor (Production Editor): Ing. Michal Dudiak, PhD.
Medzinárodný poradný zbor (International Advisory Editorial Board):
Antov Petar Yordanov (Univ of Forestry, BG), Bekhta Pavlo (Ukrainian Nat Forestry Univ, UA), Deliiski Nencho (Univ of Forestry, BG), Hua Lee Seng (UiTM Cawangan Pahang, MY), Jelačić Denis (Univ Zagreb, HR), Kasal Bohumil (Tech Univ Carolo Wilhelmina Braunschweig, DE), Lubis Muhammad Adly Rahandi (Kyungpook Nat Univ, ID), Marchal Remy (Arts & Metiers ParisTech, FR), Németh Róbert (Univ Sopron, HU), Niemz Peter (Bern Univ Appl Sci, Architecture Wood & Civil Engn, CH), Orlowski Kazimierz A.(Gdansk Univ Technol, PL), Pohleven Franc (Univ Ljubljana, SI), Rogoziński Tomasz (Poznań Univ of Life Sci, PL), Teischinger Alfréd (Univ Nat Res & Life Sci, BOKU, AT), Smardzewski Jerzy (Poznań Univ of Life Sci, PL), Vlosky Richard P. (Louisiana State Univ, USA), Wimmer Rupert (Univ Nat Res & Life Sci, AT).
Vydala (Published by): Technická univerzita vo Zvolene, T. G. Masaryka 2117/24, 960 01 Zvolen, IČO 00397440, 2024
Náklad (Circulation) 80 výtlačkov, Rozsah (Pages) 172 strán, 14,63 AH, 14,76 VH
Tlač (Printed by): Vydavateľstvo Technickej univerzity vo Zvolene
Vydanie I. – jún 2024
Periodikum s periodicitou dvakrát ročne
Evidenčné číslo: 3860/09
Acta Facultatis Xylologiae Zvolen je registrovaný v databázach (Indexed in): Web of Science, SCOPUS, ProQuest, AGRICOLA, Scientific Electronic Library (Russian Federation), China National Knowledge Infrastructure (CNKI)
Za vedeckú úroveň tejto publikácie zodpovedajú autori a recenzenti. Rukopis neprešiel jazykovou úpravou.
Všetky práva vyhradené. Nijaká časť textu ani ilustrácie nemôžu byť použité na ďalšie šírenie akoukoľvek formou bez predchádzajúceho súhlasu autorov alebo vydavateľa.
© Copyright by Technical university in Zvolen, Slovak Republic.
ISSN (print) 1336–3824, ISSN (online): 2730-1176
01. NENCHO DELIISKI – LADISLAV DZURENDA – DIMITAR ANGELSKI – PAVLIN VITCHEV – KRASIMIRA ATANASOVA: CALCULATION OF THE THERMAL ENERGY AND ITS COMPONENTS REQUIRED FOR THAWING LOGS 5
02. VIKTÓRIA SATINOVÁ – SILVIA JÁNOŠÍKOVÁ – NADEŽDA LANGOVÁ – ZUZANA VIDHOLDOVÁ – JÁN IŽDINSKÝ: THE EFFECT OF TYPE OF WOOD-BASED RECYCLATE AND LOWQUALITY TIMBER IN PARTICLEBOARD ON MECHANICAL PROPERTIES OF FURNITURE JOINTS 17
03. DOMINIK HRUŠOVSKÝ – ROMAN RÉH: PROPERTIES OF PARTICLEBOARD MADE FROM RECYCLED MUNICIPAL WASTE AND WOOD PARTICLES ............................................................................ 33
04. SERGEI KAZITSIN – ALEKSEY NAMYATOV – MIKHAIL BAYANDIN – NINA GROTSKAYA: EFFECTS OF HYDRODYNAMIC TREATMENT OF WOOD PARTICLES ON MECHANICAL PROPERTIES OF WOOD-POLYMER COMPOSITES 47
05. SLÁVKA POBUCKÁ – LIBOR KALHOTKA – MONIKA LAICHMANOVÁ – KAREL ŠUHAJDA: MONITORING OF MICROCLIMATIC CONDITIONS AND THE OCCURRENCE OF MICROMYCETES IN CRAWL SPACE ....................................................... 59
06 PATRIK ŠTOMPF – JAROSLAVA ŠTEFKOVÁ: INFLUENCE OF MOISTURE CONTENT OF MHM SOLID WOOD WALL CONSTRUCTION MATERIALS ON THERMAL CONDUCTIVITY
75
07. MARTIN HALADEJ: NUMERICAL SIMULATION OF DYNAMIC MOISTURE SPREAD IN COMPACT FLAT ROOFS 91
08. MILENA HENKE – BARBARA LIS – TOMASZ KRYSTOFIAK: RHEOLOGICAL STUDY OF INDUSTRIAL VARNISHES AT VARIOUS TEMPERATURES 105
09. ANNA VILHANOVÁ – NADEŽDA LANGOVÁ: THE EFFECT OF SELECTED FACTORS ON THE MECHANICAL PROPERTIES OF THE SEAMS FOR UPHOLSTERY COVERS MADE OF SYNTHETIC LEATHER 115
10. ANNA JASIŃSKA – MACIEJ SYDOR – GRAŻYNA NIEDZIELA –LAURA SLEBIODA: TECHNOLOGICAL GOODNESS INDEX FOR FURNITURE DESIGN
11. ĽUDMILA TEREŇOVÁ – DOMINIK ŠPILÁK – KATARÍNA DÚBRAVSKÁ – JAROSLAVA ŠTEFKOVÁ: SIMULATION OF A COMPARTMENT FIRE EFFECT ON A LOAD-BEARING WALL MADE OF STRAW
125
139
12. MAREK TRENČIANSKY – RASTISLAV ŠULEK: AN ECONOMETRIC MODEL OF TIMBER DEMAND IN THE SLOVAK
13. MARTIN HALÁSZ – MARIANA SEDLIAČIKOVÁ – ANDREA JANÁKOVÁ SUJOVÁ – JARMILA SCHMIDTOVÁ: EXTERNAL DETERMINANTS OF FAMILY BUSINESS BEFORE AND DURING CORONACRISIS IN
ACTA FACULTATIS XYLOLOGIAE ZVOLEN, 66(1): 5 16, 2024
Zvolen, Technická univerzita vo Zvolene
DOI: 10.17423/afx.2024.66.1.01
CALCULATION OF THE THERMAL ENERGY AND ITS COMPONENTS REQUIRED FOR THAWING LOGS
Nencho Deliiski – Ladislav Dzurenda – Dimitar Angelski – Pavlin Vitchev –Krasimira Atanasova
ABSTRACT
An approach for calculating the thermal energy and its components required for thawing logs intended for veneer production is proposed. The approach is based on the use of two personal mathematical models. The influence of all combinations between 5 values of the initial wood temperature from −1 °C to −40 °C and 3 values of the wood moisture content above the hygroscopic range (0.4 kg·kg-1, 0.6 kg·kg-1, and 0.8 kg·kg-1) on the thermal energy and its four components required to thaw beech logs with a diameter of 0.4 m at operating temperature of the heating medium of 80 °C was investigated. The obtained results show that this energy changes in the range from 31.66 kWh·m-3 (at −1 °C and 0.4 kg·kg-1) to 95.36 kWh·m-3 (at −40 °C and 0.8 kg·kg-1). The approach could be applied to determine the energy required to thaw various frozen capillary-porous materials in practice.
Keywords: frozen logs; frozen bound water; frozen free water; thawing; thermal energy
INTRODUCTION
For the optimization of different thermal treatment processes, it is required that the distribution of the temperature field in the wood materials and the consumed energy for their heating are known. The intensity of heating and the consumption of energy depend on the dimensions and initial temperature of the wood materials, on the content and aggregate condition of the water in them, on the law of change and the values of the temperature of the heating medium, etc. (Chudinov, 1968; Kollmann and Côté, 1984; Shubin, 1990; Sohor and Kadlec, 1990; Lawniczak, 1995; Trebula and Klement, 2002; Videlov, 2003; Câmpean, 2005; Steinhagen, 2005; Pervan, 2009; Deliiski, 2003, 2004, 2011).
The correct and effective control of the heating process is possible only when its physics and the weight of the influence of each mentioned above and many other factors for the specific wood materials are well understood. The summary of the influence of these factors on the thermal treatment processes of the wood materials is a difficult task and its solution is possible only with the assistance of adequate mathematical models, which have increased complexity in cases where the heated wood contains ice
The development of such temperature-energy models is performed using partial differential equations and requires deep mathematical knowledge. Solving the models without any simplifications, as a rule, is done by developing very complex specialized software packages, using finite difference or finite element methods (Steinhagen, 1986, 1991; Steinhagen et al., 1987; Khattabi and Steinhagen, 1992, 1993, 1995; Deliiski, 2003;
2011, 2013b; Hadjiski, 2005; Deliiski and Dzurenda, 2010; Dzurenda and Deliiski, 2019; Tumbarkova, 2019; Deliiski et al., 2018, 2021; Niemz et al., 2023).
The availability of a simpler and more accessible approach to calculating the energy required for wood thawing would be of particular interest to the development, study, and implementation of science-based energy-saving modes for the thermal treatment of frozen wood materials.
Therefore, the aim of this work is to propose an approach for calculating the thermal energy and its components required for thawing frozen logs intended for the manufacture of veneer. It should offer relatively easy-to-apply (manually or with MS Excel) equations to determine all four types of the individual components of the mentioned energy, namely: for heating the frozen and non-frozen wood itself above the hygroscopic range, for melting the temperature-dependent frozen part of bound water, and for melting all the frozen free water in the wood.
MATERIAL AND METHODS
Material for research
This research was conducted on frozen beech (Fagus sylvatica L.) logs, which are commonly used in veneer production. The calculation of the energy required for thawing frozen logs was carried out for the case of steaming or boiling of such logs in equipment operating at atmospheric pressure and at a temperature of the processing medium of 80 °C
Figure 1 shows the change of the operating temperature tm in the commonly applied modes for heating of frozen wood materials in order to defrost them in equipment operating at atmospheric pressure (Chudinov, 1968; Shubin, 1990; Dzurenda and Deliiski, 2019). These modes consist of two stages, during which tm changes as follows:

Fig. 1 Change of the operating temperature tm in modes for thawing of wood at atmospheric pressure.
▪ During the first stage, in the course of time 0 – τ1, an increase in tm from tm0 to tm1 takes place by fully or partially opening the valve to introduce heat carrier to the thermal treatment equipment;
▪ During the second stage of the modes, in the course of time τ1 – τdefr, dosed introduction of heat carrier into this equipment is carried out in order to maintain a constant technologically permissible value of the operating temperature, equal to tm1 When the temperature at the slowest heating central point of the wood materials reaches 0 °C, this determines the moment of their complete defrosting, τdefr.
The symbols, units, and values of the main parameters of the studied logs, and also of their thawing modes, which were incorporated into the equations of the scientifically validated mathematical models given below, and were used in the computer simulations, are presented in Table 1.
Tab. 1 Main set parameters of frozen beech logs and their thawing modes, which were used during the computer simulations.
Parameter name
1. Diameter of the logs
2. Length of the logs
3. Basic density of the beech wood
4. Density of the ice in the frozen wood
5. Standardized fiber saturation point of the beech wood at 20 oC (i.e. at 293.15 K)
6. Moisture content of the logs (a – at u = 0.4 kg∙kg-1 , b – at u = 0.6
)
,
7. Initial temperature of the logs in the beginning of their thawing process: (d – at tw0 = 1 oC, e – at tw0 = 10 oC, f – at tw0 = 20 oC, g – at tw0 = 30 oC, and h – at tw0 = 40 oC)
8. Temperature of complete melting of the frozen bound water and start of melting of the frozen free water in the wood
9. Temperature of complete melting of the frozen free water in the wood
10.Initial temperature of the modes for logs’ thawing
11.Temperature of stage τ1 τ2 of the thawing modes
fw-end °C 0
12.Time constant for exponential increase of tm from tm0 to tm1 τe s
13.Temperature in the central point of the logs at the end of their complete thawing
Modelling of the 1D unsteady temperature change in frozen logs
When the length of the logs, L, is at least four times their diameter, D, the nonstationary temperature distribution along the radius can be determined using the following experimentally verified 1D model (Deliiski, 2011):
at initial condition
and boundary condition for conductive heat transfer:
Where: cw-eff.1,2,3 are the effective specific heat capacities of the frozen wood during 1st, 2nd , and 3rd temperature ranges of its thawing process, given below, J·kg 1·K 1; w-eff.1,2 effective thermal conductivities in radial direction of the frozen and defrosten wood respectively, W m-1 K-1; ρw – density of the wood, kg m-3; r – coordinate along the log
radius: 0 ≤ r ≤ R, m; R – radius of the log, m; T – temperature, K; Tw0 – initial temperature of the log, K; Tm – operating temperature of the defrosting medium, K; τ – time, s.
The mathematical descriptions of cw-eff.1,2,3, w-eff.1,2, and ρw given in (Deliiski, 2003; 2009, 2011, 2013a; Deliiski, et al., 2018, 2020) were used in solving model (1) − (3).
During the solving of the model (1) – (3), the current average mass temperature of the log, n Tavg , can be calculated according to the following equation (Deliiski, 2011):
The values of Tavg at the moment when the slowest changing temperature in the central point of the logs reaches 0 °C, i.e. values Tavg-end, and this is an indicator of the completion of the log thawing process, are needed below to calculate the energy that was consumed by the logs up to that moment
Mathematical description of the specific heat capacities of wood subjected to thawing
The compresenhive experimental study of the thawing process of logs with an initial temperatureofabout–30 °Cfromdifferentwoodspeciesandvariousmoisturecontentabove the hygroscopic range, which were carried out in (Tumbarkova, 2019; Deliiski et al., 2020b) show that this process can be separated into three ranges. During the first range, the frozen logs are heated at T ≤ 272.15 K (i.e. t ≤ –1 °C) until they reach the state required for starting and gradually melt the temperature-dependent part of frozen bound water in them. During the second range between –1 °C and 0 °C a further heating of the wood occurs until reaching the state needed for starting and melting all the frozen free water in it. During the third range above 0 °C further heating of the wood layers with already fully liquid water in them occurs.
The effective specific heat capacities of the logs during the pointed three ranges of the thawing process of wood above the hygroscopic range, cw-eff.1,2,3, which participate in equation (1) are equal to the following:
Where: cw-fr and cw-nfr are the specific heat capacities of frozen and defrosted (non-frozen) wet wood respectively, J·kg-1·K-1; cice-bw and cice-fw – specific heat capacities of the frozen bound and free water in the wood respectively, J·kg-1·K-1
Mathematical descriptions of the specific heat capacities cw-fr, cw-nfr, cice-bw and cice-fw were given in (Deliiski et al., 2018, 2020a; Tumbarkova, 2019). These descriptions are included below in an appropriate manner in the equations for calculation of the individual components of the energy requred to thaw logs.
Modelling of the energy consumption of frozen logs subjected to thawing
The total specific thermal energy consumption of frozen logs subjected to thawing (in kWh·m-3), Qw-total, can be expressed by the following model (Deliiski, 2013b):
Where: Qw-fr is the thermal energy required for heating of the frozen wood to a condition necessary to melt the frozen bound water in it; Qice-bw – energy required to melt the temperature-dependent amount of frozen bound water in the wood; Qice-fw – energy required
to melt the entire amount of frozen free water in the wood; Qw-nfr – energy required to heat the allready defrosted layers of the wood until reaching 0 oC in the central point of the materials subjected to thawing.
The individual components of the energy required for complete thawing of the frozen logs, Qw-total, can be calculated using the following equations (Deliiski, 2013b):
Where the individual specific capacities cw-fr-avg, cw-nfr-avg, cice-bw-avg and cice-fw-avg are calculated as arithmetic mean values for the respective temperature ranges, which are given in parentheses in the right-hand parts of eqs (6) – (9)
The temperature Tavg-end in eq. (9) is the average mass temperature of the logs at the end of their complet thawing, which is calculated with equation (4) upon reaching 0 °C in the central point of the fully defrosted logs, K.
Solving the models (1) – (3) and (5) – (9)
The numerical solving of the model (1) – (3) in order to determine the duration of the modesforthawing ofthestudied beechlogs, andalso oftheaveragewoodmasstemperature, Tavg, during these modes, is carried out with the help of own software packages in the calculation environment of Visual FORTRAN. An explicit finite-difference scheme was used to transform the individual model equations into a FORTRAN-friendly programming form, which excludes any simplifications of the model (Dorn and McCracken, 1972)
Those specified above in Table 1 were used as basic input data relating to the characteristics of the beech logs subjected to thawing and to the operating temperature parameters of the steaming or boiling modes.
From the obtained change of the temperature field along the radius of the logs, and in particular from the moment of reaching 0 °C in their central point, the durations of the log thawing modes, τdefr, were determined for the investigated three values of the wood moisture content u and five values of the initial wood temperature tw0
The values of the average mass temperature of the logs at τ = τdefr (refer to Fig. 1), Tavgend, calculated with equation (4) were used during the solving of eq. (9).
An Excel program was prepared to solve the eqs (5) – (9) jointly. With the help of this program, the change of all four components of the energy Qw-total required for thawing the investigated logs was calculated
Table 2 gives some of the data obtained for Tavg-end and some of those for the specific heat capacities of the logs, which were used in the calculation of Qw-total and its components. In order to facilitate the analysis of the data in this table, three parameters of the logs, which were previously also indicated in Table 1, are included in it.
Tab. 2 Data on the parameters and thermophysical characteristics of the studied beech logs, which were used in the calculations of the energy Qw-total and its components.
Parameter name
1. Basic density of the beech wood ρb kg∙m-3 560
2. Moisture content of the logs (a – at u = 0.4 kg∙kg-1 , b – at u = 0.6 kg∙kg-1 , c – at u = 0.8 kg∙kg-1) u kg∙
3. Fiber saturation point of the beech wood at 1 °C (i.e. at 272.15 K) ufsp(272.15)
4. Density of the wet beech wood equal to ρb·(1 + u) ρw kg∙m-3
5. Initial temperature of the logs in the beginning of their thawing: (d – at tw0 = 1 °C, e – at tw0 = 10 °C, f – at tw0 = 20 °C, g – at tw0 = 30 °C, and h – at tw0 = 40 °C)
6. Average mass temperature of the logs with u = 0.6 kg∙kg-1 at the end of their complete thawing, depending on tw0 tavg-end °C
7. Average specific heat capacity of log layers containing both frozen bound and free water at u = 0.6 kg∙kg-1 , depending on tw0 cw-fr-avg J·kg-1·K
8. Average specific heat capacity of completely defrosted layers of logs with u = 0.6 kg∙kg-1 , depending on tw0 cw-nfr-avg J·kg-1·K
9. Average specific heat capacity of the frozen bound water in logs with u = 0.6 kg∙kg-1 , depending on tw0
ice-bw-avg J·kg-1·K-1
10. Average specific heat capacity of the frozen free water in logs, depending on u cice-fw-avg J·kg-1·K-1
RESULTS AND DISCUSSION
Figure 2 and Figure 3 present, as an example, the change in the operating temperature, tm, temperature in the central point, twc, and the average mass temperature, tavg,of frozen logs with an initial temperature of –10 oC and –30 °C respectively, calculated with the equations (1) − (4) during logs’ thawing at the three investigated values of the wood moisture content u. Fig.s 4, 5, and 6 show the calculated with eqs. (5) – (9) change in the energy Qw-total and
its components for the cases of log moisture content of 0.4 kg.kg-1, 0.6 kg.kg-1 , and 0.8 kg.kg-1 respectively, depending on tw0.
Beechlogs
tm at tm1=80C
tavgatu=0.4kg/kg
tavgatu=0.6kg/kg
tavgatu=0.8kg/kg
twcat u=0.4kg/kg
twcat u=0.6kg/kg
twcat u=0.8kg/kg
2 Change in tm, twc, and tavg of logs with tw0= −10 oC during their thawing, depending on u.
Beechlogs
tm at tm1=80C
tavgatu=0.4kg/kg
tavgatu=0.6kg/kg
tavgatu=0.8kg/kg
twcat u=0.4kg/kg
twcat u=0.6kg/kg
twcat u=0.8kg/kg
3 Change in tm, twc, and tavg of logs with tw0= −30 oC during their thawing, depending on u.
In Figures 2 and 3 it is seen that complete thawing of the logs occurs as follows:
• for two = –10 °C: after 9.5 h, 12.0 h, and 14.0 h at u = 0.4, 0.6, and 0.8 kg·kg-1 respectively;
• for two = –30 °C: after 11.5 h, 13.5 h, and 15.5 h at u = 0.4, 0.6, and 0.8 kg·kg-1 respectively. At these values of defrosting duration, τdefr, the temperature of the central point of the logs reaches 0 °C, at which the melting of the entire amount of frozen water in the logs was completed. Then, at the end of thawing, the average mass temperature of the relatively most frequently subjected to thermal treatment logs with u = 0.6 kg·kg-1 are equal as follows: tavg-end = 49.7 °C at two = –10 °C and tavg-end = 51.5 °C at two = –30 °C. These and the other values of tavg-end calculated with eq (4) for all studied combinations between two and u were used to calculate the energy Qw-nfr according to eq. (9).
Itcanbenoted,thataspecificalmosthorizontalsectionsofretentionofthetemperature twc for a long period of time in the range from –1 °C to 0 °C in the center of the frozen logs (and also in all calculation points not shown in Fig. 2 and Fig. 3 in the inner layers of the studied logs) was observed. These sections are caused by the extremely small temperature conductivity of these points during the too long melting of the frozen free water in the wood (Deliiski, 2009; Tumbarkova, 2019; Niemz et al., 2023).
Figures 4, 5, and 6 show the change in the energy Qw-total and its components for the cases of log moisture content of 0.4 kg.kg-1, 0.6 kg.kg-1, and 0.8 kg.kg-1 respectively calculated with eq. (5) – (9), depending on tw0.
Beechlogs
=0.4m
m1 =80 oC
=0.4kg.kg-1
Qw-total Qw-nfr
Qice-fw Qw-fr
Qice-bw
Fig. 4 Changes in the energy Qw-total and its components required for thawing of logs with u = 0.4 kg·kg-1 ,depending on tw0.
, kWh.m -3
Beechlogs D =0.4m
tm1 =80 oC
u =0.6kg.kg-1
Qw-total Qw-nfr
Qice-fw Qw-fr
Qice-bw
tw0, oC
Fig. 5. Changes in the energy Qw-total and its components required for thawing of logs with u = 0.6 kg·kg-1 ,depending on tw0.
The analysis of the results presented in Fig. 4 to Fig. 6 allows the following statements to be made about the influence of tw0 and u on the energy Qw-total and each of its components:
• The total energy required for thawing the frozen logs increases with a decrease in the initial temperature of the wood tw0 according to a convex slightly curvilinear dependence Qw-total = f(tw0), as follows:
▪ at u = 0.4 kg·kg-1: from 31.66 kWh·m-3 at tw0 = −1 °C to 58.40 kWh·m-3
at
=
at u = 0.8 kg·kg-1: from 63.39 kWh·m-3 at tw0 = −1 °C to 95.36 kWh·m-3 at tw0 = −40 °C.
;
If the dependences Qw-total = f(tw0) calculated according to Equation (5), are approximated with straight lines, which connect their initial and final points it turns out that
each decrease in tw0 with 1 °C causes an increase in Qw-total with approx. 0.686 kWh·m-3 at u = 0.4 kg kg-1 , 0.751 kWh·m-3 at u = 0.6 kg kg-1, and 0.820 kWh·m-3 at u =0.8 kg kg-1 .
• The energy required to heat frozen wood to a state necessary to start melting the temperature-dependent fraction of bound water in the wood, Qw-fr, increases slightly with an increase in the moisture content u and almost linearly with а decrease in tw0, from 0 kWh·m-3 at tw0 = −1 °C for all u to the following values at tw0 = −40 °C: 16.43 kWh·m-3 at u = 0.4 kg kg-1, 19.33 kWh·m-3 at u = 0.6 kg kg-1, and 22.27 kWh·m-3 at u = 0.8 kg·kg-1 .
Beechlogs D =0.4m
tm1 =80 oC u =0.8kg.kg-1
Qw-total Qw-nfr
Qice-fw Qw-fr
Qice-bw
Fig. 6 Changes in the energy Qw-total and its components required for thawing of logs with u = 0.8 kg· kg-1 ,depending on tw0.
• The energy required to melt the temperature-dependent amount of frozen bound water in the wood, Qice-bw, decreases slightly with an increase in u, and increases according to a convex curved line with a decrease in tw0, from 0 kWh·m-3 at tw0 = −1 °C for all u to the following values at tw0 = −40 °C: 8.21 kWh·m-3 at u = 0.4 kg·kg-1, 7.19 kWh·m-3 at u = 0.6 kg·kg-1, and 6.39 kWh·m-3 at u = 0.8 kg·kg-1
• The energy required to melt the entire amount of frozen free water in the wood, Qice-fw, does not depend on tw0, but increases strongly with an increase in u, reaching the following values: 4.19 kWh·m-3 at u = 0.4 kg·kg-1, 14.30 kWh·m-3 at u = 0.6 kg·kg-1, and 22.27 kWh·m-3 at u = 0.8 kg·kg-1 .
• The energy Qw-nfr required to heat the completely defrosted layers of logs at the moment of reaching 0 °C in the log central point, when the average mass temperature, tavg-end, reaches values around 50±2 °C (see item 6 in Table 2), increases with an increase in u and when tw0 is lowered, as follows:
▪ at u = 0.4 kg·kg-1: from 27.47 kWh·m-3 at tw0 = −1 °C to 29.57 kWh·m-3 at tw0 = −40 °C; ▪ at u = 0.6 kg·kg-1: from 34.28 kWh·m-3 at tw0 = −1 °C to 37.05 kWh·m-3 at tw0 = −40 °C; ▪ at u = 0.8 kg.kg-1: from 41.22 kWh·m-3 at tw0 = −1 °C to 44.53 kWh·m-3 at tw0 = −40 °C
CONCLUSION
The present paper describes an approach for calculating the energy and its components required for thawing logs intended for veneer production. The approach is based on the use oftwopersonalmodels:a1Dunsteadymodelofthetemperaturedistributionalongtheradius
of frozen logs during their thawing, and a stationary model of the energy consumption of the logs subjected to thawing as a sum of its four multifactorial components.
The numerical solving of the 1D model in order to determine the duration of the modes for thawing of the logs, and also their average mass temperature during these modes is carried out with the help of own software packages in the calculation environment of Visual FORTRAN Professional. Using this program together with the own Excel program for solving thestationarymodel,theinfluenceof all combinations between5 values oftheinitial temperature of frozen beech logs (−1°C, −10°C, −20°C, −30°C, and −40 °C) and 3 values of their moisture content (0.4 kg·kg-1, 0.6 kg·kg-1, and 0.8 kg·kg-1) on the total energy and its components required to thaw logs with a diameter of 0.4 m at operating temperature of the heating medium of 80 °C was investigated.
It was found that the total energy changes in the range from 31.66 kWh·m-3 (at −1 °C and 0.4 kg·kg-1) to 95.36 kWh·m-3 (at −40 °C and 0.8 kg·kg-1).
When expressing the individual components of the total energyas a % of it, a decrease in the initial temperature from −1 °C to −40 °C causes the following change in these components at log moisture content of 0.6 kg·kg-1:
▪ the relative share of the energy required to heat the logs to a condition necessary to melt the frozen bound water in them increases from 0% to 24.8%;
▪ the relative share of the energy required to melt the temperature-dependent amount of frozen bound water in the logs increases from 0% to 9.2%;
▪ the relative share of the energy required to melt the entire amount of frozen free water in the logs decreases from 29.4% to 18.4%;
▪ the relative share of energy required to heat the already defrosted layers of the logs at the moment of reaching 0 °C in their central point decreases from 70.6% to 47.6%.
It can be noted that the approach presented in this work could be applied to determine the energy and its components required for thawing of various frozen capillary-porous materials in practice
REFERENCES
Câmpean,M.,2005.HeatTreatmentsofWood.TransilvaniaUniversityofBraşov,Braşov,Romania, 199 pp.
Chudinov, B. S., 1968. Theory of the Thermal Treatment of Wood. Nauka, Moscow, 255 pp.
Deliiski, N., 2003. Modelling and Technologies for Steaming Wood Materials in Autoclaves. Dissertation for DSc., University of Forestry, Sofia, 358 pp.
Deliiski, N., 2004. Modelling and Automatic Control of Heat Energy Consumption Required for Thermal Treatment of Logs. Drvna Industrija, 55(4), 181 199.
Deliiski, N., 2009. Computation of the 2-dimensional Transient Temperature Distribution and Heat Energy Consumption of Frozen and Non-Frozen Logs. Wood Research, 54(3), 67−78.
Deliiski, N., 2011. Transient Heat Conduction in Capillary Porous Bodies. Ahsan A. (ed.) Convection and Conduction Heat Transfer. Tech Publishing House, Rieka, Croatia, 149-176, https://doi.org/10.5772/21424
Deliiski, N.,2013a.Computationof the Wood Thermal Conductivity during Defrosting oftheWood. Wood Research, 58(4), 637 650.
Deliiski, N., 2013b. Modelling of the Energy Needed for Heating of Capillary Porous Bodies in Frozen and Non-Frozen States. Lambert Academic Publishing, Scholars’ Press, Saarbrücken, Germany, 106 pp., http://www.scholars-press.com//system/covergenerator/build/1060
Deliiski, N., Dzurenda, L.,2010. Modelling of the Thermal Processes in the Technologies for Wood Thermal Treatment. Technical University in Zvolen, Slovakia, 224 pp.
Deliiski, N., Dzurenda, L., Angelski, D., Tumbarkova, N., 2018. An Approach to Computing Regimes for Autoclave Steaming of Prisms for Veneer Production with a Limited Power of the
Heat Generator. Acta Facultatis Xylologiae Zvolen, 60(1), 101-112, https://doi.org/10.17423/afx.2018.60.1.11
Deliiski, N., Dzurenda, L., Tumbarkova, N., Angelski, D., 2020a Mathematical description of the latent heat of bound water in wood during freezing and defrosting. Acta Facultatis Xylologiae Zvolen, 62(1), 41-53, https://doi.org/10.17423/afx.2020.62.1.04
Deliiski, N., Dzurenda, L., Tumbarkova, N., 2020b Modelling of the Two-Dimensional Thawing of Logs in an Air Environment. In Valdman J. (ed.). Modelling and Simulation in Engineering –Selected Problems, Intech Open, London, 19 pp.
Deliiski, N., Dzurenda, L., Niemz, P., Angelski, D., Tumbarkova, N., 2021. Computing the 2D Temperature Distribution in Logs Stored for a Long Time in an Open Warehouse in Winter and during Subsequent Autoclave Steaming Acta Facultatis Xylologiae Zvolen, 63(1), 49-62, https://doi.org/10.17423/afx.2021.63.1.05
Dorn, W.S., McCracken, D. D., 1972. Numerical methods with FORTRAN IV: Case Studies, John Willey & Sons Inc., New York
Dzurenda, L., Deliiski, N., 2019. Thermal Processes in the Woodworking Technologies Technical University in Zvolen, Slovakia, 283 pp
Hadjiski, M., 2003. Mathematical models in advanced technological control systems. Automatics & Informatics, 37, 7-12.
Khattabi, A., Steinhagen, H. P., 1992. Numerical Solution to Two-dimensional Heating of Logs. Holz als Roh- und Werkstoff, 50 (7-8), 308-312
Khattabi, A., Steinhagen, H. P., 1993. Analysis of Transient Non-linear Heat Conduction in Wood Using Finite-difference Solutions. Holz als Roh- und Werkstoff, 51 (4), 272-278, https://doi.org/10.1007/BF02629373
Khattabi, A., Steinhagen, H. P., 1995. Update of “Numerical Solution to Two-dimensional Heating of Logs”. Holz als Roh- und Werkstoff, 53(1), 93-94.
Kollmann, F. F. , Côté, W. A. Jr., 1984. Principles of wood science and technology. I. Solid wood. Springer-Verlag, New York, Berlin, Heidelberg, 592 pp.
Lawniczak,M., 1995. Hydrothermal and plasticizingtreatment of wood. Part I. Boilingand steaming of wood. Agricultural Academy, Poznan, 149 pp.
Mörath, E., 1949. Das Dämpfen ubd Kochen in der Furnier- und Sperrholzindustrie. Holztehnik, No. 7.
Niemz, P., Teischinger, A., Sandberg, D. (Eds.), 2023. Springer handbook of wood science and technology. Springer Nature Switzerland AG, Cham, 2069 pp.
Pervan, S., 2009. Technology for Treatment of Wood with Water Steam. University in Zagreb, Zagreb, Croatia.
Shubin, G. S., 1990. Drying and Thermal Treatment of Wood. Lesnaya Promyshlennost, Moscow, 337 pp.
Sohor, M., Kadlec, P., 1990. Hydrothermal treatment of wood for production of veneer. Drevo, № 2.
Steinhagen, H. P., 1986 Computerized Finite-difference Method to Calculate Transient Heat Conduction with Thawing. Wood Fiber Science, 18 (3), 460-467.
Steinhagen, H. P., 1991 Heat Transfer Computation for a Long, Frozen Log Heated in Agitated Water or Steam – A Practical Recipe. Holz als Roh- und Werkstoff, 49 (7-8), 287-290, https://doi.org/10.1007/BF02663790
Steinhagen, H. P., 2005. Veneer block conditioning manual for veneer and plywood production Maderas. Cienciay Tecnología, 7 (1), 49–56.
Steinhagen, H. P., Lee, H. P., Loehnertz, S. P., 1987. LOGHEAT: A Computer Program of Determining Log Heating Times for Frozen and Non-Frozen Logs. Forest Products Journal, 37 (11-12), 60-64.
Trebula, P., Klement, I., 2002. Drying and Hydrothermal Treatment of Wood. Technical University in Zvolen, Slovakia, 449 pp.
Tumbarkova, N., 2019. Modelling of the Logs’ Freezing and Defrosting Processes and their Energy Consumption. PhD Dissertation, University of Forestry, Sofia, Bulgaria, 198 pp.
Videlov, H., 2003. Drying and Thermal Treatment of Wood. University of Forestry, Sofia, 335 pp.
AUTHORS’ ADDRESSES
Prof. Nencho Deliiski, DSc. University of Forestry, Faculty of Forest Industry Kliment Ohridski Blvd. 10 1797 Sofia, Bulgaria deliiski@netbg.com
Prof. Ing. Ladislav Dzurenda, PhD. Technical University in Zvolen Faculty of Wood Science and Technology Department of Woodworking T. G. Masaryka 24 960 01 Zvolen, Slovakia dzurenda@tuzvo.sk
Prof. Dimitar Angelski, PhD. University of Forestry, Faculty of Forest Industry Kliment Ohridski Blvd. 10 1797 Sofia, Bulgaria d.angelski@gmail.com
Assoc. Prof. Pavlin Vitchev, PhD. University of Forestry, Faculty of Forest Industry Kliment Ohridski Blvd. 10 1797 Sofia, Bulgaria p_vitchev@abv.bg
Assist. Prof. Krasimira Atanasova, PhD. University of Forestry, Faculty of Forest Industry Kliment Ohridski Blvd. 10 1797 Sofia, Bulgaria k_atanasova@ltu.bg
ACTA FACULTATIS XYLOLOGIAE ZVOLEN, 66(1): 17 31, 2024
Zvolen, Technická univerzita vo Zvolene
DOI: 10.17423/afx.2024.66.1.02
THE EFFECT OF TYPE OF WOOD-BASED RECYCLATE AND LOW-QUALITY TIMBER IN PARTICLEBOARD ON MECHANICAL PROPERTIES OF FURNITURE JOINTS
Viktória Satinová – Silvia Jánošíková – Nadežda Langová–Zuzana Vidholdová – Ján Iždinský
ABSTRACT
The effect of particleboard (PB) composition made of recycled or lower-quality timber on the mechanical properties of selected furniture joints is determined in the paper. The tested PBs were manufactured using recycled PB or blockboard from old furniture and lowerquality timber with brown or white rot. The laboratory-produced control PB with particle content of 100% sound spruce wood (Picea abies Karst. L.) and commercial PBs were used for comparison of the results The load capacity and stiffness of corner joints with the confirmat (ø5 × 50 mm) and wooden dowel (ø6 × 30 mm) and the withdrawal resistance and stiffness of the screw (ø3.5 × 30 mm) were tested. The corner joints were loaded under compression by bending moment in the angular plane. In terms of load-carrying capacity, control PB was the most suitable in achieving a load-carrying capacity of 7827.61 N∙mm for the confirmat and PB from recycled blockboard 4072.71 N∙mm when using the wooden dowel. As for joint stiffness, the best values achieved were 1316.00 N∙mm/° and 808.58 N∙mm/° for the PB from recycled blockboard using the confirmat and dowel, respectively. PB from recycled blockboard again showed the highest values of screw withdrawal resistance - for the edge withdrawal 416.61 N and for the surface withdrawal 556.44 N. Considering the values found for the investigated mechanical properties, it was assumed that the tested materials can be used as non-load-bearing elements in furniture construction
Keywords: wooden recyclate; particleboard; furniture joints; joint mechanical properties.
INTRODUCTION
Sustainable product initiatives aim to ensure that by 2030, a significant proportion of products available to consumers in the European Union are designed to be durable, energy and resource-efficient, more environmentally friendly, repairable, and recyclable, and preferably use recycled materials in their production. Eco-design, sometimes referred to as Design for the Environment, is an umbrella term describing techniques used to incorporate an environmental component into products and services before they enter the production phase (Directive 2009/125/EC, Act No. 529/2010 Coll. on Environmental Design and Use of Products) It can be performed by adopting various tools and methods, such as those based on the life cycle thinking principle (ISO 14006: 2020). The design of ecomaterials is changing from the single criterion of environmental consciousness to total life-cycle
considerations in the production and use of products. Life-cycle considerations demand checkpoints at three stages of product life: (1) processing stage: from the extraction of resources to the delivery of products; (2) utilization stage: the period during which products are used as intended; and (3) end-of-life stage: recycling or disposal after use (Halada and Yamamoto, 2001). Life cycle thinking is based on core principles of the Life Cycle Assessment (LCA) methodology according to ISO 14044:2020. The LCA techniques showed that particleboards (PBs) have a minimal impact on the environment, except for global warming if they were not landfilled after use (Rivela et al., 2006; Mohd Azman et al.,2021; Santos et al., 2021). According to the results of the study of Çınar (2005), standard PB had an environmental impact lower than standard fiberboard (72% improvement). For surface and edge finishes, a low-density laminate is preferred to a high-density laminate (36% improvement). Silva et al. (2021) investigated the potential of recycled wood and bioresins to make the PBs The iterative testing and LCA of PB resulted in the fact that the developed PBs were environmentally benign alternatives to conventional PB made of synthetic polymers and wood particles, reducing up to 95% of the environmental impacts of human toxicity, abiotic depletion, and other impacts compared to conventional practices.
Furniture is an apparatus needed in human daily life. The design and construction of furniture is an applied art. The requirements for furniture design are not only appealing appearance and current fashion but also sound functionality and structural safety (Wang and Lee, 2014).
In furniture manufacturing various materials, such as wood and wood-based panels are used. Wood-based panels such as medium-density fiberboard and PBs are widely used in manufacturing case-type furniture because the mechanical, physical, and surface qualities of the engineered panels are comparable to those of solid woods (Kasal et al., 2011). Today, PB is widely used in furniture manufacturing because PB is much cheaper than wood, fiberboards, and plywood (Bardak, 2018). In the past, various sources of wood are used for their production, mainly forest assortments, and secondary sources (edges, cuttings and sawdust). Today, the effort is to use old or recycled wood, or various lignocellulosic materials (Guler et al., 2004; Kwon et al., 2013; Kord et al., 2015; Wronka and Kowaluk, 2019; Iždinský et al., 2020; Iždinský et al., 2021; Wronka and Kowaluk, 2022; Vilkovský et al., 2022; Pelc and Kowaluk, 2023). There is still a need to look for other alternative sources of wood replacement in the production of PBs, such as agricultural residues (e.g., poppy husks, walnut, kiwi prunings, cotton seed hulls, rice straw-wood, vine prunings, pine cone, almond shells, wood flour) and non-wood plant fibers (Kucuktuvek et al., 2017).
However, the employment of fiberboard and PB requires a careful approach to the choice of joints connecting construction elements of such furniture (e.g., particular house furniture for sitting). The application of the same connectors and joints as in the case of solid wood may reduce the stiffness and strength of the construction and increase the time of its assembly, e.g., in particular house furniture for sitting (Smardzewski et al., 2015).
Joints fulfil necessary strength, technological, and operational-aesthetic functions in furniture construction. In general, joints are the weakest parts of a given piece of furniture, and furniture durability depends, first and foremost, on their quality (Podskarbi et al., 2016).
Furniture quality is determined by its form, aesthetics, functionality, ergonomy, rigidity, strength, and durability. The strength and durability of furniture are some of the most essential factors determining furniture value (Smardzewski and Majewski, 2013).
Following the analysis of the literature on the mechanical properties of corner joints for furniture purposes, Majewski et al. (2020) stated various aspects regarding corner joint rigidity, namely theinfluenceofmaterial densityas well as stiffness andrigidity offasteners; the effect of number of fasteners on joint stiffness; the influence of fastener/joint geometry
on joint stiffness; presence, type, and adhesives application technique; the effect of narrow surfaces finishing, use of edge banding, as well as its type and thickness; the effect of a fastener grain orientation changes in relation to the grain direction of the specimen on the pulled-out joint strength; the influence of the back panel assembly method on the strength of thecornerjoints;theinfluenceofthefastenersmountingforceonthejointstrength,theeffect of the guide holes diameter for screwed-in connectors on the joint strength.
It is very important that the newly created materials are suitable and compatible with the conditions of the furniture use. The aim of the study by Antov et al. (2020) was to evaluate the potential of using new eco-friendly recycled wood fibreboard bonded with magnesium lignosulfonate in furniture construction. For this purpose, the bending strength of L-shaped corner joints with mechanical fasteners was determined.
The L-type corner joints made from the developed composites demonstrated significantly lower bending capacity (from 2.5 to 6.5 times) compared to the same joints made from MDF panels. Nevertheless, the new eco-friendly composites can be efficiently utilised as a structural material in non-load-bearing applications.
The withdrawal capacity is based on the composite action between the screw thread of thewoodandhenceisdefinedbythewoodpropertiesandgeometricparametersofthe thread (Hoelz et al., 2022) For board materials, the position of the fastener relative to the plane of the plate plays a role. The effect of the thread pitch of confirmats in pine wood was evaluated by Sydor et al. (2015);they determined littleeffect onloading capacityfor confirmats placed perpendicular to the tangential plane. The load-bearing capacity of confirmats in the tangential plane was 15% higher than in the radial plane. Chen et al. (2016) investigated the pullout resistance of bamboo wood screws with higher resistance compared to that of MDF and PB.
In the work of Taj et al. (2009), the axial screw withdrawal resistance of a 4.8 mm diameter screw for beech is 2690 N, hornbeam 3000 N and poplar 1750 N. The pullout force value for a 6 mm diameter bolt for beech is 6111 N, oak 5307 N and pine 2975 N (Efe et al., 2004). The materials often used in furniture are not only commercial materials such as MDF and HDF, but sandwich materials giving the opportunity to improve the properties of the structures or to reduce the price can be used. For example, the three-layer board is made as a combination of PB, as the core, and layers of HDF or MDF as outer layers.
Jivkov et al. (2017) investigated 10 wood-based sandwich materials and two types of screw, 4 × 40 mm universal screw, and 7 × 50 mm, concluding that the type of wood-based materials (especially the effect of density) has a significant impact on the axial screw withdrawal resistance investigated; there is no correlation between the density of materials and screw withdrawal resistance; the highest withdrawal resistance for both types of screws was in beech plywood (4066 N), OSB, cherry veneered MDF and birch plywood. The lowest values were obtained in PB, a three-layer board with a core of PB sheathed with laminated HDF with a total thickness of 18 mm and MDF. According to this work, the lowest load capacity of the universal screw was in PB (920 N).
Although brown and white rot reduce the mechanical properties of wood, it is still a material that can be used in the production of composite materials. These materials are environmentally friendly and pose no health risk to humans. Since we want to verify the suitability of using PB made of recycled PB and lower quality wood in furniture construction, the aim of this paper is to verify and compare the mechanical properties of the corner joints and the screw withdrawal resistance The quality of the joints is also evaluated through the type and extent of damage to the joint.
MATERIALS AND METHODS
Manufacturing of PB
In the laboratory conditions at the Technical University in Zvolen, three-layer PB type P2 was produced for interior use. Four variants of PBs and one variant of control PB were produced (Tab. 1). The PBs contained particles from (a) old laminated PB furniture, (b) old veneered blockboard furniture, (c) lower-quality timber spruce wood (Picea abies, Kart. L.) with inactive brown rot (Famitopisi pinicola /Sw./ P. Karst.), or (d) lower-quality timber spruce wood (Picea abies, Kart. L.) with inactive white rot (Armillaria ostoyae /Romang. /Herink). The quantity of brown and white rot in timer is analyzed in Satinová et al. (2022). Only particles from sound spruce wood species (Picea abies, Kart. L.) were used for manufacturing the control PB
The particles were bonded with urea-formaldehyde (UF) adhesive with hardener and paraffin from KRONOSPAN s.r.o. The adhesive mixture was applied to the particles in a rotary mixing machine. The layered particles were cold-pressed in a low-temperature machine at a pressure of 1 MPa. The pressing was carried out in a CBJ 100-11 press (TOS, Rakovník, Czech Republic) according to a three-stage pressing diagram – maximum pressing plate temperature 240 ºC, maximum specific pressing pressure 5.23 MPa and with a pressing factor of 8 s·mm-1
PBs were subsequently conditioned in an environment with a temperature of 20±2 ºC and a relative humidity of 65±5%. The manufactured boards were 400 × 300 × 16 mm in size. A total of 6 pieces of board were manufactured for each type. The specimens were cut from the parts prepared this way. The control specimen was made in order to compare the production technology in the laboratory and commercial conditions. The commercial PB was supplied by JAF Holz Slovakia, s.r.o. The raw PB FunderMax E1E05 Homogen was type P2 with a density of 719 kg·m-3 (Tab. 1), which is suitable for the interior. An overview of the density of the PB used in the experiment is given in Tab 1. The density was determined following the requirements of the standard STN EN 323.
The test specimens of 50 × 150 × 16 mm were stored in an air-conditioned room at a temperatureof20±2 °Candrelativehumidityof60±5%foronemonth.Themoisturecontent of the specimens was determined following the requirements of standard STN EN 322.
Tab. 1 Density of commercial and laboratory manufactured PB used in the experiment.
Determination of the mechanical properties of the corner joints
When determining the load capacity and stiffness of the corner joint, the following scheme (Fig. 1a) for loading the corner joint subjected to bending moment in the angular plane by compression is used. All geometric parameters for determining the mechanical properties of the corner joints can be derived from loading diagram (Figs. 1a and 2b). The load progression of the corner joints was executed according to force deformation diagram (Fig. 1d). Two types of furniture fasteners were tested: a) confirmat with the dimension of ø5 × 50 mm and b) wooden dowel with the dimension of ø6 × 30 mm. The dowels were glued with Technobond polyvinyl acetate adhesive of resistance class D3. It is a one-
component copolymer adhesive with good moisture resistance and is suitable for furniture from PB



Fig. 1 Specimen for stiffness and load capacity (a) dimensions of the specimens, (b) loading scheme with geometrical characteristics (c) execution of the test and (d) force deformation diagram.
r1, r2 – arms of the joint, the distance of the center of loading force from the pivot point (mm); l – force arm (mm); F – compression loading force (N); a – arm span (mm); c – displacement of the joint arms under load (mm); φp – joint angle before loading (°); φd – joint angle after loading (°)
The strength characteristics were investigated in the range from 10% to 40% of the maximum load of the joint. Based on the recorded forces and their associated displacements, the deformation, stiffness and load capacity were calculated using the following equations:
(a) Joint load capacity:
(b) Joint stiffness:
Where:Mu – load capacity (N∙mm)
Fmax – maximum loading force (N)
l – arm of the force (mm)
t – joint stiffness (N∙mm/°)
Δφ – angular deformation at load from 10% to 40% Fmax (°)
Determination of the withdrawal capacity and stiffness for the screw
When determining the axial screw withdrawal capacity, the methodology of STN EN 26891:1995 was followed. The test procedure requires estimating the maximum Fest load to be determined by experience, calculation, or preliminary tests. The procedure for loading the test body is shown in Fig. 2a. The dimensions of the test specimen for determining the screw withdrawal resistance are w x h x d (mm). The fasteners used in this test were ø3 5 × 30 mm screws. Pre-drilled holes of ø2.5 mm to a depth of 16 mm were drilled at the screw location. The size of the specimens was 50 × 50 mm. The screws were mounted in two directions on the surface and on the edge of the plate as shown in Fig. 2b



The determined strength characteristics are:
Screw withdrawal capacity: ���� =�������� (N)
Deformation at maximum withdrawal capacity: �� =�������� (mm)
Withdrawal stiffness (modulus of displacement) of the screws in the material (when it is pulled out) expresses the amount of force required to induce a unit length deformation (displacement). It is expressed by the steepness of the force-deflection curve. The withdrawal stiffness of the screw is determined by following equation:
Where: T – withdrawal stiffness (N∙mm-1),
ΔF – load capacity difference at 40% and 10% of maximum load (N),
Δu – displacement difference at 40% and 10% of maximum load (mm)
RESULTS AND DISCUSSION
Mechanical properties of the corner joints
The average values of the mechanical properties for corner joints loaded by compressive bending moment for the individual materials and connector types tested, are given in Tab. 2 and 3. The load-carrying capacity Mu (N∙mm) and stiffness of corner joints t (N∙mm/°) were evaluated. Based on the preliminary tests, it was found that for all materials and dimensions of the confirmat tested, the bending moment stress in the angular plane in tension exhibits a higher load-carrying capacity than the bending moment stress in the angular plane. Both the stiffness and the load capacity of the confirmats reach higher values of mechanical properties compared to pin joints, when stressed in the angular plane by compression. The highest values of these mechanical properties were achieved by the joints for PB with recycled block boards. The load capacity of the pin joint is 33% lower compared to the confirmat. The stiffness of the pin joint is 39% lower compared to the confirmat. Comparing the joints forPB with recycled block board with commercial PB, the commercial PB achieves higher values. The values of mechanical properties for the glued pin joint are smaller by 57% and for the confirmat by 35%.
Tab. 2 Mechanical properties of of the corner joint using wooden dowel and confirmat for tested PBs.
Mechanical properties of corner joint
Wooden dowel
PBs type:
Note: Value at parenthesis is coefficient of variance.
Confirmat


(a) (b)
Fig. 3 Force-displacement diagram of stress loading in the angular plane – average value (a) wooden dowel joint, (b) confirmat joint.
Tab. 3 One-way analysis of variance for the load-carrying capacity under compression bending and joint stiffness.
Effect
Note: DOF – Degree of freedom, F – Test value, p – Probability
Tab. 3 shows that at the significance level of 0.05, all investigated factors, i.e., type of fastener (p=0.000) and type of material or density (p=0.000), as well as their interaction (p=0.000), were significant for both the load capacity and stiffness of corner joints. It means that a change in any of the investigated factors will result in a change in the load capacity or the stiffness of the corner joint, respectively.
Withdrawal resistance and stiffness of the screw
The average values of the mechanical properties, the withdrawal resistance F (N) and withdrawal stiffness T (N∙mm-1) for screws ø3 5 × 30 mm loaded by axial force embedded in the tested materials at their surface and edge are given in Tab. 4.
Tab. 4 Mechanical properties of axially loaded screws ø3.5 × 30 mm embedded in the tested materials.
Note: Value at parenthesis is coefficient of variance.
Tab. 5 One-way analysis of variance for withdrawal stiffness and resistance of ø3.5 × 30 mm screws.
Sigma-restricted parameterization
Effective hypothesis decomposition Withdrawal stiffness
Note: DOF – Degree of freedom, F – Test value, p – Probability
Following the one-way analysis of variance (Tab. 5), the effect of selected factors on the withdrawal resistance of the screw ø3 5 × 30 mm was determined. The effect of all factors, density of materials and load direction acting simultaneously was statistically significant at the 5% significance level (p=0.007) when evaluating withdrawal stiffness. The effect of all factors, density of materials and load direction acting simultaneously, was statistically significant at the 5% significance level (p=0.001) when evaluating withdrawal resistance.
Higher withdrawal resistance and withdrawal stiffness was achieved when the screw was embedded in the surface of the specimen (perpendicular to the plane of the plate). The highest values of withdrawal resistance were achieved by the screw embedded in the surface of PB from recycled blockboard at the level of 556.44 N, which is 25.13% higher than for edge embedding with a capacity of 416.61 N. Compared to commercial PB (863.59 N), the withdrawal resistance for PB from recycled blockboard is 35.56% lower for surface embedding and 33.34% lower for edge embedding. The smallest withdrawal resistance values were performed by the brown rot specimen. Compared to the commercial PB, the values for the surface were lower by 60.69% and for the edge were lower by 64.88%. The screw withdrawal stiffness was also the highest for the PB from recycled blockboard compared to other tested materials. Compared to commercial PB, the withdrawal stiffness of PB from recycled blockboard withdrawal resistance for this material was lower, with a difference of 11.40% for surface embedding and 35.31% for edge embedding.
Fig. 4 shows characteristic damage of a glued wooden dowel joint and Fig. 5 shows damage of a confirmat joint.




(a) (b)
Fig. 5 Failure modes in some of the studied cases – confirmat at: (a) commercial PB and (b) PB with recycled blockboard.
The lower quality of the recycled PB and lower-quality timber was also reflected in the extent of damage around the fastener. According to the work (Langová and Jočšák, 2018), the extent of the damage for ø5 × 50 mm confirmat for spruce and beech joints was 10 mm in diameter around the fastener header. This damage was up to 30 mm in diameter for commercial PB and MDF materials. In the case of the materials tested in this study, the damage was manifested through the entire width of the specimen (50 mm). For a glued ø6 × 30 mm wooden dowel, the material was visible to be torn out at a distance of 18 mm from the centre of the dowel. Although the difference in densities between commercial PB and boards made of recyclate or using lower quality timber was negligible, there was a visible difference in damage at the glued joints. In commercial PB, the dowel breaks, while in the tested specimens thematerialaroundthe gluedjoint was tornout. Forthe confirmatdesigned for bonding PB when joining commercial PB, there was a bending of the confirmat, which was typical damage to the joint, in our tested specimens there was a breakage of a part of the structural board. This type of damage is related to the quality of bonding in the production of PB.
Discussion
The density values of the control PB were lower, which may be due to the production technology in laboratory conditions.
The measured and calculated load capacity values of corner joints PB made from recycled material and lower quality timber with commercial PB and solid timber can be compared. According to the work of Langová and Jočšák (2018), the assumption that the mechanical properties are influenced by the density of the material and the bolt dimension but also by the thickness of the material was confirmed. For comparison, the values of the strengthpropertiesofø5 ×50mmcompression-loadedcornerscrewedjointswerepresented
The highest load capacity values were achieved by the PB made from recycled blockboard 6113.94 N∙mm, which is comparable to the load capacity of commercial MDF with 12 mm thickness, ρ = 680 kg m-3 (6890.00 N mm). In the case of our recycled PB, the loading capacity was 3312.32 N∙mm, which is comparable to that of commercial PB with 12 mm thickness (3600.00 N mm) or to that of a joint made from spruce lumber with 12 mm thickness, ρ =392 kg∙m-3 (4580N∙mm).According to theworkof Antov et al. (2020), corner joint with ø7 × 50 mm confirmat made from eco-friendly boards, produced in the laboratory with a density of 720 kg m-3 and 15% magnesium lignosulfonate gluing content, based on the dry fibres, achieved a loading capacity value of 6950 N∙mm.
The effect of the diameter of the fastener and the density of the material to be bonded wasalsoconfirmedinthecaseofbondedjoints.In ourcase,ajointofPBmadefromrecycled blockboard (ρ = 649 kg m-3) with a glued wooden dowel ø6 × 30 mm achieved a loading capacity of 4072.71 N∙mm. In the work of Antov et al. (2020) a joint made of eco-friendly boards (ρ = 726.5 kg m-3) with a glued wooden dowel ø 8 × 30 mm achieved a two times more loading capacity of 8020.00 N∙mm. The highest stiffness values were achieved in the case of the PB made from recycled blockboard 1316.00 N∙mm/°, which is comparable to the stiffness of commercial PB with 12 mm thickness (1279.50 N mm/°) and 12 mm thick commercial MDF, ρ = 680 kg∙m-3 (1805.01 N∙mm/°). For both commercial materials, with 18 mm thickness, the joint stiffness was almost three times higher compared to the PB made from blockboard recyclate, which showed the best strength properties for both types of fasteners among the tested materials.
The axial screw withdrawal resistance is influenced by the density of the material. Higher values were achieved for screws stressed to pull perpendicularly from the surface of the specimen, which is also suitable from a practical point of view when attaching furniture fittings. In terms of the axial screw withdrawal resistance of ø3.5 × 30 mm screw, the best results were achieved by the PB made from recycled blockboard (556.44 N), which is almost 1.5 times less compared to commercial PB. Compared to spruce parallel to the grain in the tangential and radial directions (1117.00 N) and perpendicular to the grain (1034.00 N), it is 2 times less.
In the work of Pereira et al. (2018), panels reinforced fibers reached about 74% of the maximum strength achieved by MDF samples. Panels reinforced with pejibaye showed the worst mechanical performance. However, hybridization between pejibaye and fibers resulted in a performance improvement of approximately 50% in the maximum withdrawal load comparing with panels reinforced only with pejibaye fibers. The results of Yorur et al. (2020) indicated that the average direct screw withdrawal resistance ranged from 695 N to 2076 N for frontal test blocks, while for lateral in MDF it ranged from 79 N to 1634 N. For PB frontal test blocks, the average direct screw withdrawal resistance ranged from 474 N to 1646 N, while for lateral it ranged from 190 N to 1313 N. The results of Sackey et al. (2008) studies indicate that not only the content of fine particles, but also the ratio of all fractions with particle size strongly influences the efficiency and strength of the bond. In three-ply particleboards with a low target density, replacing 20% of the fines content of the total slurry with coarse particles increased the internal joint strength by 40% and the screw adhesion by 18%. Wronka and Kowaluk (2022) reported that the screw withdrawal resistance decreases with subsequent re-milling of the PB to produce the PB out of recovered particles. The progressive milling of the PB leads to achieving a fraction of the fine-size particles of growing bulk density,whichinfluences the density profile ofthepanels produced, especially of the face zone. This local densification allows the surface soundness to be kept high, irrespective of the decrease in other mechanical parameters, such as internal bond and screw withdrawal resistance.
In the event of a decrease in forest resources, it is possible to produce PB from various rawlignocellulosicmaterials. Several studies have dealt with this area.Basedonthefindings ofthesestudies, we can concludethatsources ofagricultural rawmaterials suchas cane stalk (Kord et al., 2015) and lignocellulosic particles of raspberry Rubus idaeus L. (Kowaluk et al., 2019) or rice husks (Kwon et al. 2013) meet the standard and in some cases PB had improved physical and mechanical properties, therefore, they are a suitable material for the production of PB.
CONCLUSION
• Comparing results for tested mechanical properties of this study with other works carried out under the same loading conditions and dimensions of the test bodies, it can be concluded that particleboard made from recycled materials and lower-quality timberachieves significantlylowerstrength properties comparedto commercial PBs. These properties are evaluated through the mechanical resistance of the joints. Therefore, these materials find application in non-load-bearing elements of furniture structures In the case of brown rot, the boards can be used as part of decorative interior elements.
• The influence of the proportion of recycled or reduced quality timber is reflected in the density of the material and subsequently in the strength properties of the joints, with the highest values achieved by the PB made from recycled blockboard. Based on the determined strength characteristics of the joints, producing structural boards by adding recyclate and not by adding timber of lower quality is recommended. When using a proportion of timber with brown and white rot, the strength properties of the joints show the lowest values.
• The extent of damage around the fastener highlights the need to reconsider the spacing of fasteners in structural joints but also the correct choice of fastener. A larger wooden dowel diameter is recommended for bonded joints.
• Asthematerialisrecommendedfornon-load-bearingordecorativeinteriorelements, examining the adhesion of decorative veneers or foils is advisable.
REFERENCES
Antov, P., Jivkov, V., Savov, V., Simeonova, R., Yavorov, N., 2020. Structural application of ecofriendlycompositesfromrecycledwoodfibresbondedwithmagnesium lignosulfonate.Applied Sciences 10(21), 7526. https://doi.org/10.3390/app10217526
Bardak, S., 2018. Predicting the impacts of various factors on failure load of screw joints for particleboard using artificial neural networks. BioResources 13(2), 3868–3879. https://doi.org/10.15376/biores.13.2.3868-3879
Çinar,H., 2005. Eco-designandfurniture: Environmental impactsofwood-based panels, surface and edge finishes. Forest Products Journal, 55(11), 27–33.
Directive 2009/125/EC of the European Parliament and of the Council of 21 October 2009 establishing a framework for the setting of ecodesign requirements for energy-related products. [Access 2023-11-28]. Available: https://eur-lex.europa.eu/eli/dir/2009/125/oj
Efe, H., Erdil, Y.Z., Kasal, A., Imirzi, H.O., 2004. Withdrawal strength and moment resistance of screwed T-type end-to-side grain furniture joints. Forest Products Journal, 54(11), 91–98.
EN ISO 14044:2020. Environmental Management - Life Cycle Assessment - Requirements and Guidelines.
Guler, C., Ozen, R., 2004. Some properties of particleboards made from cottonstalks (gossypium hirsitum l.). Holz roh werkst 62: 40-43.
Halada, K., Yamamoto, R., 2001. The current status of research and development on ecomaterials around the world. MRS bulletin, 26(11), 871–879. https://doi.org/10.1557/mrs2001.227
Hoelz, K., Doerner, P.T., Hohlweg, J., Matthiesen, S., 2022. Influence of thread parameters on the withdrawal capacity of wood screws to optimize the thread geometry. European Journal of Wood and Wood Products 80(3), 529–540. https://doi.org/10.1007/s00107-022-01792-9
Chen, Y., Zhu, S., Guo, Y., Liu, S., Tu, D., Fan, H., 2016. Investigation on withdrawal resistance of screws in reconstituted bamboo lumber. Wood Research 61(5), 799–810.
Iždinský, J., Vidholdová, Z., Reinprecht, L., 2020. Particleboards from recycled wood. Forests, 11(11), 1166.
Iždinský, J., Reinprecht, L., Vidholdová, Z., 2021. Particleboards from recycled pallets. Forests, 12(11), 1597.
Jivkov, V., Kyuchukov, B., Simeonova, R., Marinova, A., 2017. Withdrawal capacity of screws and confirmat into different wood-based panels. in Proceedings of the The XXVIIIth International Conference Research for Furniture Industry, Poznan, Poland, 21–22.
Kasal, A., Yüksel, M.F., Fathollahzadeh, A., Erdil, Y.Z., Yildirim, N., 2011. Ultimate failure load and stiffness of screw jointed furniture cabinets constructed of particleboard and mediumdensity fiberboard. Forest Products Journal 61, 155–160. https://doi.org/10.13073/0015-747361.2.155
Kord, B., Roohani, M., Kord, B., 2015. Characterization and utilization of reedstem as a lignocelulosic resource for particleboard production. Maderas. Ciencia ytecnología 17(3): 517524.
Kowaluk, G., Wronka, A., 2019. Influence of density on selected properties of furniture particleboards made of raspberry rubus idaeus l. Lignocellulosic particles. Annals of warsaw university of life sciences sggw forestry and wood technology, vol. 105, pp. 62-70. https://doi.org/10.5604/01.3001.0013.7719
Kucuktuvek, M., Kasal, A., Kuskun, T., Erdil, Y. Z., 2017. Utilizing poppy husk-based particleboards as an alternative material in case furniture construction. BioResources 12(1), 839–852. https://doi.org/10.15376/biores.12.1.839-852
Kwon, J. H., Ayrilmis, N., Han, T. H., 2013. Enhancement of flexural properties and dimensional stability of rice husk particleboard using wood strands in face layers. Composites Part B: Engineering, 44(1), 728-732.
Langová, N., Joščák, P. 2018. Mechanical properties of screw of furniture constructions. 1st edn. ed. Publishing House of the Technical University, Zvolen (in Slovak)
Majewski, A., Krystofiak, T., Smardzewski, J., 2020. Mechanical properties of corner joints made of honeycomb panels with double arrow-shaped auxetic cores. Materials 13, 4212. https://doi.org/10.3390/ma13184212
Mohd Azman, M.A.H., Ahmad Sobri, S., Norizan, M.N., Ahmad, M.N., Wan Ismail, W.O.A.S., Hambali, K.A., Hairi, M.H., Hermawan, A., Mohamed, M., Teo, P.T., Taharin, M. R., Noor, N.A.M.,2021.Lifecycleassessment (LCA)of particleboard: investigationoftheenvironmental parameters. Polymers 13, 2043. https://doi.org/10.3390/polym13132043
Pelc, O., Kowaluk, G., 2023. Selected physical and mechanical properties of particleboards with variable shares of nettle Urtica dioica L. lignocellulosic particles. Annals of Warsaw University of Life Sciences SGGW Forestry and Wood Technology, vol. 123, pp. 30-40. https://doi.org/10.5604/01.3001.0053.9307
Pereira,A.A.,d'Almeida,J.R.,2018.Mechanicalandphysicalscrewwithdrawalpropertiesbehavior of agglomerated panels reinforced with coir and pejibaye fibers. Wood Material Science & Engineering, 13(5), 286-295.
Podskarbi, M., Smardzewski, J., Moliński, K., Molińska-Glura, M., 2016. Design methodology of new furniture joints. Drvna industrija 67(4), 371–680.
Rivela, B., Hospido, A., Moreira, T., Feijoo, G. 2006. Life cycle inventory of particleboard: A case study in the wood sector. The International Journal of Life Cycle Assessment 11, 106–113. https://doi.org/10.1065/lca2005.05.206
Sackey, E., Semple, K., Won Oh, S., Smith, G.D., 2008. Improving core bond strength of particleboard through particle size redistribution. Wood Fiber Sci 40(2): 214-224. https://wfs.swst.org/index.php/wfs/article/view/752
Santos, A., Carvalho, A., Barbosa-Povoa, A., 2021. An economic and environmental comparison between forest wood products–Uncoated woodfree paper, natural cork stoppers and particle boards. Journal of Cleaner Production 296, 26469. https://doi.org/10.1016/j.jclepro.2021.126469
Satinová, V., Hlaváč, P., Iždinský, J., Reinprecht, L., 2022. Rot evaluation in spruce logs and rot reflection into dimensions of chips for particleboards. Acta Facultatis Xylologiae Zvolen, 64(2), 5-16.
Silva, V.U., Nascimento, M.F., Oliveira, P.R., Panzera, T.H., Rezende, M.O., Silva, D.A.L., de Moura Aquino, V.B., Lahr, F.A.R. and Christoforo, A.L., 2021. Circular vs. linear economy of building materials: A case study for particleboards made of recycled wood and biopolymer vs. conventional particleboards. Construction and Building Materials 285, 122906. https://doi.org/10.1016/j.conbuildmat.2021.122906
Smardzewski, J., İmirzi, H. O., Lange, J., Podskarbi, M., 2015. Assessment method of bench joints made of wood-based composites. Composite Structures 123, 123–131. https://doi.org/10.1016/j.compstruct.2014.12.039
Smardzewski, J., Majewski, A. 2013. Strength and durability of furniture drawers and doors. Materials & Design 51, 61–66. https://doi.org/10.1016/j.matdes.2013.03.101
STN EN 322: 1995. Wood-based panels. Determination of moisture content.
STN EN 323: 1996. Wood-based panels. Determination of density.
STN EN 26891: 1995 Timber structures. Joints made with mechanical fasteners. General principles for the determination of strength and deformation characteristics.
Sydor,M.,Zmyślony,G.,Pinkowski,G.,Szymański,W.,2015.Theinfluenceofpitchontheholding power ofscrewsinscotspinewood. Annalsofwarsawuniversityoflifesciences-sggw.Forestry and wood technology 90, 193–197.
Taj, M. A., Kazemi Najafi, S., Ebrahimi, G , 2009 Withdrawal and lateral resistance of wood screw in beech, hornbeam and poplar. In European Journal of Wood and Wood Products (Vol. 67, Issue 2, pp. 135–140). Springer Science and Business Media LLC. https://doi.org/10.1007/s00107-008-0294-9
The Act No. 529/2010 Coll. on Environmental design and use of products (“Eco-design Act”) [online]. [Access 2023-11-28]. Available: https://www.slov-lex.sk/pravnepredpisy/SK/ZZ/2010/529/
The Act No. 529/2010 Coll. on Environmental design and use of products (“Eco-design Act”) [online]. [Access 2023-11-28]. Available: https://www.slov-lex.sk/pravnepredpisy/SK/ZZ/2010/529/
Vilkovský, P., Vilkovská, T., Klement, I., Čunderlík, I., 2022. The Analysis Effect of Selected Factors on the Shear Strength of Woodbark at Different Wood Species. Forests, 13, 637. https://doi.org/10.3390/f13050637
Wang, Y., Lee, S. H., 2014. Design and analysis on interference fit in the hardwood dowel-glued joint by finite element method. Procedia Engineering 79, 166–172. https://doi.org/10.1016/j.proeng.2014.06.326
Wronka, A.; Kowaluk, G , 2022. The Influence of Multiple Mechanical Recycling of Particleboards on Their Selected Mechanical and Physical Properties Materials 15, 23: 8487. https://doi.org/10.3390/ma15238487
Yorur, H., Birinci, E., Gunay, M. N., Tor, O., 2020. Effects of factors on direct screw withdrawal resistance in medium density fiberboard and particleboard. Maderas. Ciencia y tecnología, 22(3), 375-384.
ACKNOWLEDGMENT
This work was supported by the Scientific Grant Agency of the Ministry of Education, Science, Research, and Sport of the Slovak Republic Grant No. 1/0665/22 (50%) and 1/0264/22 (50%)
AUTHORS’ ADDRESSES
Ing. Viktória Satinová, PhD. Ing. Zuzana Vidholdová, PhD.
Ing. Ján Iždinský, PhD.
Technical University in Zvolen Faculty of Wood Sciences and Technology, Department of Wood Technologies
T. G. Masaryka 24 960 01 Zvolen Slovak Republic xsatinova@is.tuzvo.sk zuzana.vidholdova@tuzvo.sk jan.izdinsky@tuzvo.sk
Ing. Silvia Jánošíková
doc. Ing. Nadežda Langová, PhD. Technical University in Zvolen Faculty of Wood Sciences and Technology, Department of Furniture and Wood Products
T.G. Masaryka 24 960 01 Zvolen Slovak Republic xvanikova@is.tuzvo.sk langova@tuzvo.sk
ACTA FACULTATIS XYLOLOGIAE ZVOLEN, 66(1): 33 46, 2024
Zvolen, Technická univerzita vo Zvolene
DOI: 10.17423/afx.2024.66.1.03
PROPERTIES OF PARTICLEBOARD MADE FROM RECYCLED MUNICIPAL WASTE AND WOOD PARTICLES
Dominik Hrušovský – Roman Réh
ABSTRACT
Particleboard consumption in the furniture industry is high, and the wood raw material costs required for particleboard production are also high. Therefore, the incorporation of cheaper recycled raw materials into the particleboard structure is welcome and the economic costs of their production are reduced. The aim of this research was to find out the possibilities of processing recycled municipal waste in a commonly produced structure and incorporating it into the particleboard in an optimal proportion. Another goal was to determine the effect of the recycled material proportion on the selected particleboard physical and mechanical properties so that boards can be used for common furniture interior applications. Singlelayer particleboard with 10%, 15%, 20%, 25% and 30% of recycled waste were produced, followed by three-layer boards with the proposed optimal 15% recycled waste in their core layer. The following properties of particleboard were tested: flexural strength, swelling, water absorption, density (according to the relevant provisions of EN). The effect of the proportion of recycled waste on board properties was manifested in comparison with the control samples, the reduction of the mechanical values was moderate. The bending strength values of three-layer particleboards with a 15% recycled waste content in their core layer were at an average level of 9.7 N/mm2. The required level of bending strength of 11 N/mm2 was not achieved. It was caused by the recycled elements manufactured shapes which were not slim enough and, in combination with the slim wood particles, worsened the properties of the manufactured particleboard. Adjusting the recycled elements' shape and pressing conditions makes achieving the standard required values of the particleboard properties possible.
Keywords:particleboard;recycledplasticwaste;physicalproperties;mechanicalproperties
INTRODUCTION
Technologies in the woodworking industry are considering a number of innovations and advances in the use of recycled materials, as the conservation of natural resources and recycling become an increasingly important issue. The trend of today is the recycling of man-made waste, which is suitable, even necessary, to be processed and thereby reduce its volume (Irle et al., 2012, Barbu et al., 2014).
Even manufacturers of wood composite boards are influenced by new trends and increasingly strict ecological criteria. In order to reduce the cost of input raw materials, they are forced to process recycled waste, and therefore the technological equipment and tools used in woodworking plants are adapting to this trend, becoming flexible in processing
different input materials (Maloney 1993, Ihnát et al. 2020, Lübke and Ihnát 2018, Adeniran 2021).
The advantage of using recycled waste is the increase in market competitiveness for the production of composite materials. Recycled waste can also be used in particleboard production. This is evidenced by a number of research papers by experts from around the world who have dealt with and are engaged in this idea. The use of alternative raw materials such as agricultural biomass and recycled wood waste and by-products in particleboard production. It is aviable approachto respond to the increasedglobaldemand forwood-based materials, and it is a key circular economy principle as well as discussed extensively by Lee et al. (2022). Nguyen et al. (2023) present and discuss the available studies on the utilization of waste wood resource for wood-based panel production. They indicated that the majority of waste wood research was from Europe. Also, Baharuddin et al. (2023) conducted an extensive study, and they stated that environmentally friendly or green materials are more commonly used in the furniture making industry. The knowledge of the environmental risks including the depletion of natural resources, the impact of pesticides, as well as the amplifier and enforcement criteria of good practice have led to an increase in the practice of recycling waste materials. Particleboard is used mainly in the furniture industry, but they are used in the production of construction and carpentry products, in construction and in other industries as well. Therefore, a large amount of wood raw material is consumed for the production of particleboard. Wood raw material in the production of particleboard can be replaced to a certain extent with recycled waste; however, due to the diversity of recycled waste used in particleboard,it cancausecertain quality problems relatedto its composition andits changed production technology (Faisal et al., 2022, Sommerhuber et al., 2016, Ajayi et al., 2019).
The aim of this research was to find out and describe the effect of different proportions of recycled plastic municipal waste with a certain standard manufactured structure on particleboard production with its adequate density. The intention was to find out the effect of the amount of recycled plastic municipal waste on the physical and mechanical properties of particleboard and to determine the optimal proportion of a specific type of recycled waste in thecoreparticleboardlayerso thatthephysical andmechanical properties ofparticleboard do not deteriorate and that particleboard with a certain proportion of recycled waste in their core layer is usable for furniture purposes (Falemara et al., 2015, Ihnát et al., 2017).
MATERIALS AND METHODS
Two types of particles were used in the production of three-layer particleboard. The fraction of fine particles was determined for the particleboard surface layers which did not change either in the case of the reference particleboard or in the case of the investigated particleboard with a modified core layer. The spruce wood particles for the surface layers of particleboard had dimensions from 0.125 mm to 1.0 mm. The fraction of coarser particles was determined for the particleboard core layer. The spruce wood particles for the core layer had dimensions from 0.25 mm to 2.5 mm. In the case of the reference particleboard, coarser particles were used in the core layer in the amount of 100%, in the case of the investigated particleboard with a modified core layer, the share of core particles was reduced to 85%, depending on the weight share of the added recycled waste recommended by this research. The particles for the core layer were dried to a moisture content of 2% and for the surface layers to a moisture content of 4%.
The recycled waste used for the production of the modified core layer of particleboard was based on sorted municipal waste from the refuse-derived fuel (RDF) category and is
officially referred to as iRDF (i = innovative). RDF is a fuel produced from various types of waste such as municipal solid waste (MSW), industrial waste or commercial waste.
iRDF is created by high-speed grinding of common municipal waste as a by-product. Recyclable and inert components are first sorted out of municipal waste, e.g. metals, mineral components, bio-components suitable for composting, some types of plastic, cardboard, etc. The remaining component mainly contains non-recyclable plastics (up to 70%), paper, wood, textile materials and usually ends up as energy raw material for cement plants and waste incinerators or, in the worst case, only ends up in a landfill, as there are few capacities for ecological waste incineration (Fig. 1) (Internal unpublished company’s materials 2023).

adhesive mixture for the particleboard production.
iRDF as a raw material has the potential for significantly more significant use as a secondary fuel. However, it is necessary to adjust the size of its elements. The result of the innovativehigh-speed grinding process is the new so-called fractalstructure ofgroundwaste elements which enables better compatibility of plastics contained in a heterogeneous matrix (Internal unpublished company’s materials 2023).
The company Castor&Pollux s r.o., Bratislava deals with the processing and use of recycled plastic waste. It also deals with the idea of ecological use and waste recycling by incorporating these raw materials into building materials. After consultations, the use of iRDF as an addition to particleboard was tested as an example of using a certain proportion of iRDF in them and, thus, achieving this waste recycling in structural furniture materials. The company supplied the necessary amount of iRDF raw material in a normally produced structure. It was assumed that despite supposed unsatisfactory shapes, the fractal structure of iRDF after high-speed milling (Fig. 2) could have a good affinity of its plastic elements to the wood particles in the particleboard matrix without the need to increase the amount of applied glue compared to the usual technological procedures of their production (Internal unpublished company’s materials 2023).

Industrial urea-formaldehyde adhesive (UF) was used for the production of experimental particleboard (Pizzi 2018, Dunky 2003, Frihart and Hunt 2010). The adhesive KRONORES PBU 1151 F with dry matter content 68.11%, with viscosity (Ford) 4mm/20°C – 73 s, adhesive pH was 8.45, with the condensation capacity 100°C – 68s was used in the particleboard core layer. In the particleboard surface layers, the adhesive KRONORES PBU 1742 F with dry matter content 69.53%, with viscosity (Ford) 4mm/20°C – 85s, adhesive pH was 8.58, with the condensation capacity 100°C – 46s was used. The adhesive mixture was composed of the adhesive and chemical auxiliary substances (paraffin emulsion and hardener). A hardener (57% aqueous solution of ammonium nitrate) was used in an amount of 4% dry matter per weight of the adhesive used. Paraffin emulsion with a dry weight of 35% in an amount of 0.75%, based on the dry particle weight, was used for the board hydrophobisation.
ThelaboratorypressequipmentCBJ100-11from TOSRakovník,CzechRepublicwas used for particleboard production. Pressing took place according to the usual three-stage pressing diagram for particleboard with a maximum specific pressure of 5.75 MPa and a pressing factor of 8 s/mm of board thickness. The pressing temperature for both types of particleboard was 220 °C (Réh 2017, Réh and Vrtielka 2013, Sellers 1985). The selected pressing parameters used are identical to the pressing parameters used in normal practice in order not to disrupt, prolong or complicate established manufacturing processes in any way.
In thefirst step, asingle-layerparticleboardwith dimensions of36x 26 cm andaboard thicknessof1.5cmwasproducedinthelaboratory.Weassumedthedensityofmanufactured particleboard of ρ = 600 kg.m-3 and their moisture after air conditioning was w = 6%.
Variants of single-layer particleboard were produced with different proportions of iRDF in the entire volume of the board in the amount of 10-30% in increments of 5%. Five sample variants were produced this way. The mass ratio of particles and iRDF was Tsv:R = 100:0; 90:10; 85:15; 80:20; 75:25; 70:30. The adhesive mixture deposit for particles was 11%. Ten boards were made from each variant and subjected to tests: strength in three-point bending (dimensions of test samples 350 x 50 mm), density(dimensions of test samples 50 x 50mm), swelling (dimensions of test samples 50 x 50 mm), absorbency (dimensions of test samples 50 x 50 mm). It was made ten pieces of reference samples by single-layer particleboard without the addition of iRDF.
After finishing the pressing process, the particleboard was placed in a rack to cool down and subsequently it was air-conditioned for 7 days until its final moisture content of 7% was reached. A total of 50 pieces of single-layer particleboard were produced.
Based on the tests of the single-layer particleboard properties and after their evaluation, it was decided that the optimal proportion of recycled material in terms of the most suitable strength properties of the boards for the subsequent production of three-layer particleboard in their core layer will be 15% of recycled material and 85% of core wood particles. We assumed the density of manufactured particleboard ρ = 600 kg.m-3 and their moisture after air conditioning should be w = 6%. The adhesive mixture deposit for the core particles was 7%, the adhesive mixture deposit for the surface particles was 11%. To determine the physical and mechanical properties, ten three-layer particleboard with dimensions of 36 x 36 cm and a thickness of 1.8 cm which is the most commonly used in practice, were produced.
From the point of view of the visual effect of the modified particleboard, recycled material was added only to the core layer, so that the particleboard surface would remain unchanged in color and structure compared to the unmodified particleboard. The addition of recycled material to the particleboard core layer also has a positive effect on their homogenous all-wood surfaces, as the subsequent particleboard surface treatment, most often by lamination or veneering, can take place in the standard mode without considering the presence of plastic substances in their structure.
Both surface layers of the three-layer particleboard consisted of pure spruce fine particles, and the recycled material was added only to the particleboard core layer, and it was not visible in the board surface. Pressing took place according to the commonly used threestage pressing diagram, as in everyday particleboard production in practice. The three-layer particleboard was conditioned to a moisture of 7%. Ten pieces of three-layer particleboard with a proportion of recycled plastic waste of 15% were produced. Eight boards were used to determine their properties. Two particleboards were used for visualization, one particleboard was used as a sample of raw particleboard with a modified core layer with recycled material, and the other particleboard was used for veneering to visually document its possible use in the furniture industry.
The determination of selected properties of particleboard produced using recycled waste and wood particles was carried out according to the valid provisions of technical standards (EN 314-1:2004, EN 310:1993, EN 636:2012+A1:2015, EN 317:1993, EN 319:1993, EN 323:1996, EN 309: 2005, ISO 16983:2003, EN 312: 2010).
The three-point bending strength of single-layer particleboard was determined using the TIRA test 2200 testing machine according to the technical standard EN 319:1993.
RESULTS AND DISCUSSION
The density of single-layer particleboard with 10%, 15%, 20%, 25% and 30% of recycled plastic waste did not change itself essentially due to the addition of recycled material, because the calculated weighting values were correct and the laboratory weighing, and all layering were also carried out correctly; the small deviations were caused only by slight imperfect manual particles layering. The densities of the fifty manufactured particleboards were in the range of 555 – 575 kg/m3 and this is in accordance with the expected calculated values.
Since the density of bulk iRDF (ground plastics, paper, textile) is low compared to wood particles, with the increase of its share in particleboard, it was possible to observe a slight decrease in particleboard density.
The average density of ten three-layer particleboards with a 15% share of recycled material in the core layer reached values in the range of 582 – 597 kg/m3, it was stable, and it was in accordance with the assumed calculated values.
Table 1 shows the average bending strengths of single-layer particleboard with iRDF proportions from 10 to 30%.
Tab. 1 Average three-point bending strength values of single-layer particleboard with 0%, 10%, 15%, 20%, 25% and 30% iRDF. Single-layer
* The standard deviation is given in parentheses
As the proportion of iRDF in single-layer particleboards increased, their bending strength decreased. The highest value of bending strength was achieved by the samples with the smallest added proportion of recycled material of 10%. Particleboard with a recycled content of 15% had almost the same bending strength, there was a minimal difference in strength values. The samples with the highest proportion of 30% of the recycled material achieved the lowest strength. We consider these bending strength results to be understandableandjustified,becausethegroundrecycledmaterialdidnothavesuchelement dimensions that would resemble the particle slenderness, ensuring good bending strength of the boards after they have been pressed. Pressed particles cannot have small and even irregular dimensions, particles are always produced with predetermined dimensions and slenderness. Ground recycled material was far from this requirement. Therefore, the smaller the amount of recycled material added to the particleboard, the more the strength properties of the particleboard will resemble conventional industrially produced particleboard (Ihnát et al., 2020, Adeniran, 2021, Ihnát et al., 2017).
Based on these results, it was decided to press three-layer particleboard with a proportion of 15% recycled material in their core layer, since the bending strength of singlelayer particleboard with the addition of 15% recycled material (5.12 N/mm2) approximately corresponded to the value of the bending strength of single-layer particleboard without the addition of recycled material (5.26 N/mm2). 15% share of recycled material was chosen for the three-layer particleboard also because its bending strength value is almost similar to the more favorable value of 10% share of recycled material, and by increasing the amount of iRDF used in particleboard (from 10% to 15%), its higher utilization and greater saving of wood raw material occurs.
The determination of the three-point bending strength of three-layer particleboard was also performed on the TIRA test 2200 test machine according to the technical standard EN 319:1993. Thebending strength values ofthree-layerparticleboardwith a15%iRDFcontent in their core layer are shown in Table 2.
Tab. 2 Strength values in three-point bending of three-layer particleboard with a share of 15% iRDF in their core layer
* Standard deviation is given in parentheses
** Average value (N/mm2) for 10 test samples
For particleboard of the P2 category (boards for indoor equipment for use in a dry environment, including furniture), the technical standard EN 312: 2010 sets a minimum bending strength value of 11 N/mm2. The reference laboratory board made by us from pure spruce particles achieved an average bending strength value exceeding the required limit and this corresponds to our previous experience (Réh 2017, Réh and Vrtielka 2013) as well as that of other authors (Ihnát et al., 2017, Pędzik et al. 2021). The bending strength values of three-layer particleboards with a 15% iRDF content in their core layer were at an average level of 9.7 N/mm2. The required level of bending strength of 11 N/mm2 was not achieved. The reason is the irregular shape of the recycled material without the necessary slenderness which is common in the case of particles. The particle slenderness ensures sufficient values of particleboard bending strength. In the case of replacing 15% of the thin particles in the core layer with recycled material, the overall strength of the particleboard decreased slightly, understandably.
However, it is not an unsolvable or insurmountable problem. It is possible to slightly increase the amount of applied adhesive mixture (unfortunately, certainly at the expense of production economy) which will ensure the necessary increase in bending strength values above 11 N/mm2. Perhaps intensifying the pressing conditions would be sufficient, e.g. by increasing the specific pressing pressure, higher pressing factor or changing the pressing diagram; all this would need to be verified by further research. With further research, it is possible in any case to verify the amount of added recycled material, naturally downwards or, in particular, to modify the shape of the manufactured recycled elements so that they better meet the needs of their incorporation into particleboard. The fact that some values of particleboard with a 15% recycled content in the core layer were already approaching the limit of 11 N/mm2 (10.59 or 10.80 N/mm2, even 11.01 N/mm2) within the framework of this research, it indicates that most of these proposals will be feasible.
Tests of particleboard thickness swelling and particleboard absorbency after 2 and 24 hours were performed for three-layer particleboard with an iRDF content of 15%.
Determination of the thickness swelling of particleboard with a proportion of recycled material of 15% in their core layer during 2 and 24 hours was carried out according to the provisions of the technical standard EN 317: 1993. Table 3 shows the average swelling values achieved.
Tab. 3 Swelling values after 2 and 24 hours of three-layer particleboard with a proportion of 15% iRDF in their ore layer.
* Standard deviation is given in parentheses
The thickness swelling of particleboard with 15% recycled content in their core layer during 2 and 24 hours is slightly higher than the values of standard spruce particleboard. The reason is the presence of absorbent recycled particles in the particleboard core layer. The swelling values of modified particleboard with recycled material are not significantly higher compared to unmodified particleboard and they are acceptable. By properly and consistently covering the entire surface of the boards with an interior finish (decorative veneers, laminates) incorporated in furniture applications (including edges), slightly increased swelling values of modified particleboard are less significant.
Determination of the water absorption of particleboard with a proportion of 15% recycled material in their core layer during 2 and 24 hours was carried out according to the customary practices, as the technical standard is currently not valid. Table 4 shows the average achieved water absorption values.
Tab. 4 Water absorption values after 2 and 24 hours of three-layer particleboard with a proportion of 15% iRDF in their core layer.
* Standard deviation is given in parentheses
The proportion of recycled material of 15% in the particleboard core layer affected their water absorption which increased significantly; basically, three times compared to standard spruce particleboard. It is again possible to justify this fact by the presence of absorbentrecycledelementsintheparticleboardcorelayer.Thewaterabsorptionofstandard particleboard is always higher, but the modified particleboard core layer using the iRDF component in the proportion of 15% worsened the water absorption even more. The composition of iRDF (ground fine plastics, paper, various textile components, etc.) with disturbed surface homogeneity is an environment that absorbs and retains water. This increases the weight of the examined samples over time and the water absorption increases. The particleboard water absorption is problematic, and older (Maloney 1993, Youngquist 1999, Kamke and Lee 2007) and newer publications (Réh and Vrtielka 2013, Pędzik et al., 2021, Benthien and Ohlmeyer 2013) draw attention to this fact.
The elimination of the particleboard water absorption of with a proportion of 15% iRDF in their core layer can also be considered in connection with the appropriate and consistent closure of the entire surface of the boards with an interior surface treatment (decorative veneers, laminates) incorporated in furniture applications (including edges) and thereby preventing the ingress of water or increased air humidity into them.
Some obvious connections emerge from the evaluation of all performed property tests of modified particleboard with the addition of iRDF. The reference sample of single-layer particleboard had an average density of 605 kg/m3. The densities of the modified singlelayer particleboard were lower, ranging from 555 to 575 kg/m3. The density of bulk iRDF is low compared to wood particles, with the increase of its share in particleboard it was therefore possible to observe a slight decrease in the particleboard density. Recycled plastic waste absorbs the adhesive (applied in the mixture) to a higher degree than wood particles and, in addition, when pressed, it cushions more than wood particles, so that the internal structure of the pressed board is loosened. Therefore, this phenomenon will manifest itself in a small decrease in the board’s density and, understandably, it will also manifest itself in the increased water absorption and swelling of the modified boards.
If recycled material was used in the core layer of three-layer particleboard, it means that the density in the particleboard core layer was lower than in the particleboard surface layers consisting of pure spruce particles without the presence of recycled material. The lower density of the particleboard core layer is a natural thing for all common particleboard types but the presence of recycled material in it reduced its density even more. This could be observed in the fractures in the test bodies after the bending strength test, and it can be verified more precisely by further research when measuring the density profiles of different types of modified particleboard. These observations are consistent with the works of other authorsdealing withsimilarissues(Adeniran2021,Réh2017,Benthien and Ohlmeyer2013, Tudor et al., 2020).
In the thickness swelling of three-layer particleboard with a 15% share of recycled material, it was possible to record a significant increase in the board thickness after 2 hours, up to twice as much. Recycled waste as an additive to particleboard has greater hydrophobic properties compared to wood, and in addition, in pressed particleboard, during the standard process of particleboard production, it creates small gaps in its structure for the possible ingress of water or increased air humidity. We assume that the recycled waste, in addition to insufficient adhesion with the wood particles with the creation of gaps for water penetration, probably also absorbed the paraffin emulsion which was added as a chemical auxiliary substance to the adhesive mixture to increase the particleboard hydrophobicity (Fig. 3). The diverse structure of iRDF which does not help to maintain good physical and mechanical properties of modified particleboard, is evident.
Municipal waste could serve as potential raw materials for particleboard manufacturing. However, every type of municipal waste has its own issue that prevents it to be used effectively. Municipal waste is among the possible materials for particleboard manufacturing as particleboard manufactured from it often displayed satisfactory physical and mechanical properties. Still, in some case, the incorporation of some portion of municipal elements are necessary to further enhance its performance (Lee et al., 2022).
Study of Santos et al. (2021) presents a challenging approach that addresses the efficient management of the organic fraction of municipal solid waste by hydrothermal carbonization for the development of novel sustainable materials. By adjusting the technological parameters of the manufactured boards, they achieve their suitable properties when incorporating municipal waste shares and they conclude that this way of using municipal waste is feasible.
The objective of study of Harshavardhan and Muruganandam (2017) was to use municipal dry waste, plant waste and saw dust collected from various sources to make particle boards with each individual item as well as a combination of these in various ratios. The physical and mechanical properties of these boards were determined by using a series of tests like moisture content test, water absorption properties, thickness swelling, tensile test, compressive test, and flexural strength. The results were compared and most of the samples were found to comply with the IS standards.
These findings are also consistent with the results of the work of Baharuddin et al., (2023).

During the production process of single-layer particleboard at a pressing temperature of220°C,themeltingof somerecycledelementsontheirsurfaceincontact withthepressing plates was observed, and thus impaired handling when removing the boards from the press. This phenomenon worsened as the proportion of recycled material in the particleboard increased. It was necessary to gently separate the boards mechanically from the pressing plates of the press, and this slightly disturbed the boards surface structure. The presence of recycled material in the structure of single-layer particleboard and therefore also on their surface was evident (Fig. 4). In the production of three-layer particleboard without the presence of iRDF in the surface layers, this phenomenon understandably did not occur.

Fig. 4 Recycled iRDF together with wood particles present on the surface of pressed single-layer particleboard.
The surface of one pressed modified three-layer particleboard with veneering was upgraded for demonstration purposes. Its appearance (Fig. 5 left) was excellent, the presence of iRDF in its structure is understandably invisible. The presence of iRDF in the core layer ofthethree-layerparticleboardwasnotvisibleeveninthesurfacelayersof rawparticleboard without surface treatment (Fig. 5 right).

Fig. 5 Modified three-layer particleboard with the presence of 15% iRDF in the core layer surface treated with veneering for demonstration purposes (left) and raw particleboard with the presence of 15% iRDF in the middle layer without surface treatment (right).
CONCLUSION
In the research, attention was paid to determining the influence of the proportion of recycled iRDF plastic waste in single-layer and three-layer particleboard on selected physical and mechanical properties. All produced particleboard with iRDF addition had deteriorated properties compared to unmodified particleboard. In the thickness swelling of three-layer particleboard with a 15% share of recycled material, up to a two-fold increase in thickness was recorded
compared to the reference sample and a several-fold increase compared to the EN 317 standard, which sets the permissible swelling for particleboard to a maximum of 8%. It is assumed that recycled plastic waste is more hydrophobic than wood spruce particles. Moreover, in the particleboard structure, it will create spaces for water to penetrate into them during the production process. And in addition, recycled plastic waste (ground fine plastics, paper, various textile components, etc.) also absorbs the paraffin emulsion added to the adhesive mixture for particleboard pressing.
The bending strength of single-layer particleboard decreased with the increasing proportion of recycled material in the board. Recycled iRDF is produced regardless of its shape; its structure is irregular, without the necessary slenderness and strength which is common in the case of wood particles. The slenderness of the pressed particles during the particleboard production ensures their sufficient values of bending strength. In the case of replacing 15% of the thin particles in the core layer with recycled material, the overall strength of the particleboard decreased slightly, understandably (Samek 1989)
For furniture particleboard type P2, the technical standard EN 312 sets a minimum bending strength value of 11N/mm2.Thebending strength ofthree-layerparticleboards with a 15% iRDF content in their core layer was at an average level of 9.7 N/mm2. Irregular shapes of recycled material without the necessary slenderness, were also reflected in the reduction of the mechanical properties of the produced modified particleboard. However, this deficiency can be solved. It is possible to increase the amount of applied adhesive mixture, intensify the pressing conditions, e.g., by increasing the specific pressing pressure, using ahigherpressing factor,orchanging thepressing diagram. Ofcourse,this will increase the production cost, but the saved funds for wood raw material can balance this item. All this needs to be verified by further research and to be proven by more detailed calculations. With furtherresearch,it is possibletoverifytheamount ofaddedrecycled material, naturally downwards or, in particular, to modify the shape of the produced recycled elements so that they better meet the needs of their incorporation into particleboard.
If the producer of grounded iRDF waste solves the production of its elements in terms of a more homogeneous structure and slenderness of the produced shapes (it has promised), it will be possible to follow up on the previous research and develop a full-fledged threelayer particleboard with the presence of a certain amount of recycled iRDF in its core layer and thus saving the financial resources invested in purchasing wood raw material.
REFERENCES
Adeniran,T.,2021.PropertiesofParticleboardMadefromRecycledPolystyreneandCocos Nucifera Stem Particles. Open Journal of Agricultural Research, 1(1), 1–7. https://doi.org/10.31586/ojar.2021.010101
Ajayi, B., Adeniran, A.T., Falade, O.E., Alade, B.O., 2019. Characterization of Plastic Bonded Composites Reinforced with Delonix Regia Pods. SWST 2019 International Convention. Tenaya Lodge, Yosemite National Park, California, USA. Baharuddin, M.N.M., Norazwani, M.Z., Harun, W.S.W., Roslin, E.N., Ghazali, F.A., Som, S.N.M., 2023. Development and performance of particleboard from various types of organic waste and adhesives: A review. International Journal of Adhesion and Adhesives, Volume 124, 103378, ISSN 0143-7496.
Barbu, M.C., Irle, M., Réh, R., 2014. Wood Based Composites, Chapter 1. Aguilera A., Davim P., Research Developments in Wood Engineering and Technology. IGI Global. Engineering Science Reference. Hershey, PA, 1-45.
Benthien, J.T., Ohlmeyer, M., 2013. Thickness swelling and water absorption of WPC after immersion in cold and boiling water. European Journal Wood Products. 71, 437–442. https://doi.org/10.1007/s00107-013-0695-2
Dunky, M., 2003. Adhesives in the wood industry. Pizzi A, Mittal KL (eds.) Handbook of adhesive technology, 2nd ed. Marcel Dekker Inc., New York, p. 71. https://doi.org/10.1201/9780203912225.ch47
EN 309: 2005 Particleboards - Definition and classification. European Committee for Standardization: Brussels, Belgium, 2005
EN 310: 1993 Wood-Based Panels. Determination of Modulus of Elasticity in Bending and of Bending Strength. European Committee for Standardization: Brussels, Belgium, 1993.
EN 312: 2010 Particleboards – Specifications. European Committee for Standardization: Brussels, Belgium, 2010.
EN 314-1:2004 Plywood Bonding Quality Part 1: Test Methods. European Committee for Standardization: Brussels, Belgium, 2004.
EN 317:1993 Particleboards and fibreboards - Determination of swelling in thickness after immersion in water. European Committee for Standardization: Brussels, Belgium, 1993.
EN 319:1993 Particleboards and fibreboards. Determination of tensile strength perpendicular to the plane of the board. European Committee for Standardization: Brussels, Belgium, 1993.
EN 323:1996 Wood-based panels Determination of density. European Committee for Standardization: Brussels, Belgium, 1996.
EN 636:2012+A1:2015: Plywood - Specifications European Committee for Standardization: Brussels, Belgium, 2012; 2015.
Faisal, I. Ch., Jahidul, I., Subroto, H., Hossain, M. Z., 2022. Recycled wood plastic biocomposites and development of new materials. Editor(s): Md Rezaur Rahman, Muhammad Khusairy Bin Bakri. Woodhead Publishing Series in Composites Science and Engineering, Recycled Plastic Biocomposites, Woodhead Publishing, 119-145, ISBN 9780323886536. https://doi.org/10.1016/B978-0-323-88653-6.00011-0
Falemara, B.C., Ajayi, B., Badejo, S.O., Adelusi, E.A., 2015. Strength and Sorption Properties of Bamboo (BambusaVulgaris) Wood-Plastic Composites. Proceedings of the Forest and Forest Products Conference in Atlanta Georgia, USA, June 2015.
Frihart, C.R., Hunt, C.G., 2010. Adhesives with wood materials, bond formation and performance. Wood Handbook - Wood as an engineering material. General Technical Report FPL- GTR-190. Madison, WI: U.S. Department of Agriculture, Forest Service, Forest Products Lab., Ch. 10. Harshavardhan, A., Muruganandam, L., 2017. Preparation and characteristic study of particle board from solid waste. IOP Conference Series: Materials Science and Engineering. 263. 032005. https://doi.org/10.1088/1757-899X/263/3/032005
Irle, M.A., Barbu, M.C., Réh, R., Bergland, L., Rowell, R.M., 2012. Wood composites. In: Handbook of wood chemistry and wood composites. Boca Raton: CRC Press, 321-411. ISBN 978-1-4398-5380-1.
Ihnát, V., Lübke, H., Russ, A., Borůvka, V., 2017. Waste agglomerated wood materials as a secondary raw material for chipboards and fibreboards Part I. Preparation and characterization of wood chips in terms of their reuse. Wood Research, 62, 45–56.
Ihnát, V., Lübke, H., Balberčák, J., Kuňa, V., 2020. Size reduction downcycling of waste wood. Review. Wood Research, 65, 205–220. Internal unpublished company’s materials Castor&Pollux, s.r.o. Bratislava.
ISO 16983:2003 Wood-based panels Determination of swelling in thickness after immersion in water. EC Technical Committee ISO/TC 89, Brussels, Belgium, 2003.
Kamke, F., Lee, J., 2007. Adhesive penetration in wood - A review. Wood and Fiber Science, 39. 205-220.
Lee, S.H., Lum, W.Ch., Boon, J.G., Krišťák, Ľ., Antov, P., Pędzik, M., Rogoziński, T., Taghiyari, H.R., Lubis, M.A.R., Fatriasari, W., Yadav, S.M., Chotikhun, A., Pizzi, A., 2022. Particleboard from agricultural biomass and recycled wood waste: a review. Journal of Materials Research and Technology, Volume 20, p. 4630-4658. ISSN 2238-7854. https://doi.org/10.1016/j.jmrt.2022.08.166
Lübke, H., Ihnát, V., 2018. Nová technológia spracovania odpadových DTD pre opätovné použitie vo výrobe. [New technology for the waste particleboard treatment of for the reuse in the production]. Wood Researcch, 9 (19), 56-57.
Maloney, T.M., 1993. Modern particleboard and dry-process fiberboard manufacturing. San Francisco: Miller Freeman Inc., 681p. ISBN 0-87930-288-7.
Nguyen, D., Luedtke, J., Nopens, M., Krause, A , 2023. Production of wood-based panel from recycled wood resource: a literature review. Eur. J. Wood Prod. 81, 557–570. https://doi.org/10.1007/s00107-023-01937-4
Pędzik, M., Janiszewska, D., Rogoziński, T., 2021. Alternative lignocellulosic raw materials in particleboard production: A review. Industrial Crops and Products, Volume 174, 114162, ISSN 0926-6690, https://doi.org/10.1016/j.indcrop.2021.114162
Pizzi, A., 2018. Wood Adhesives: Chemistry and Technology. https://doi.org/10.1201/9780203733721.
Réh, R., Vrtielka, J., 2013. Modifikácia stredovej vrstvy trieskových dosiek pazderím a jej vplyv na vlastnosti trieskových dosiek [Modification of the particleboard core layer by the hemp flint and its effect on the particleboard properties]. Acta Facultatis Xylologiae Zvolen 55, No.1, 51-59.
Réh, R., 2017. Modification of the particleboard core layer by non-wood lignocellulosic raw materials. Wood modification research & applications: third COST Action FP1407 International conference, Kuchl, Austria 14-15 September 2017, 52-53. ISBN 978-3-20005255-0.
Samek, J., 1989. Velkoplošné dřevní materiály [Sheet wood materials]. Dřevařská příručka I., SNTL – nakladatelství technické literatury, Kafka, E. ed., Praha, p. 163 – 208. ISBN 80-03-00009-2. Santos, M.M., Diez, M.A., Suárez, M., Centeno, T.A., 2021. Innovative particleboard material from the organic fraction of municipal solid waste. Journal of Building Engineering, Volume 44, 103375.ISSN 2352-7102. https://doi.org/10.1016/j.jobe.2021.103375.
Sellers, T., 1985. Plywood and Adhesive Technology. Boca Raton: CRC Press, ISBN 978-0-82477407-3.
Sommerhuber,P.F.,Tianyi,W.,Krause,A.,2016.Wood–plasticcompositesaspotentialapplications of recycled plastics of electronic waste and recycled particleboard. Journal of Cleaner Production, Volume 121, 176-185. ISSN 0959-6526. https://doi.org/10.1016/j.jclepro.2016.02.036
Tudor, E.M., Barbu, M.C., Petutschnigg, A., Réh, R., Krišťák, Ľ., 2020. Analysis of Larch-Bark Capacity for Formaldehyde Removal in Wood Adhesives. International Journal Environmental Research Public Health, 17, 764.
Youngquist, J.A., 1999. Wood based composites and panel products. In: Wood Handbook -Wood as an Engineering Material, Chapter 10, Forest Product Laboratory, General Technical Report, FPL–GTR:113. Madison.
ACKNOWLEDGMENT
This research was supported by the Slovak Research and Development Agency under contract No. APVV-19-0269andAPVV- 20-0004,andbytheMinistryofEducation,Science,ResearchandSport of the Slovak Republic under the project VEGA 1/0077/24.
AUTHOR’S ADDRESSES
Ing. Dominik Hrušovský prof. Ing. Roman Réh, CSc. Technical University in Zvolen Faculty of Wood Science and Technology Department of Woodworking Technologies T. G. Masaryka 24 960 01 Zvolen Slovakia xhrusovskyd@tuzvo.sk reh@tuzvo.sk
ACTA FACULTATIS XYLOLOGIAE ZVOLEN, 66(1): 47 58, 2024
Zvolen, Technická univerzita vo Zvolene
DOI: 10.17423/afx.2024.66.1.04
EFFECTS OF HYDRODYNAMIC TREATMENT OF WOOD PARTICLES ON MECHANICAL PROPERTIES OF WOODPOLYMER COMPOSITES
Sergei Kazitsin – Aleksey Namyatov – Mikhail Bayandin – Nina Grotskaya
ABSTRACT
This study is aimed to investigate the mechanical properties of wood-polymer composites (WPC) made on the basis of polylactic acid (PLA) with the addition of mechanically activated wood particles (WPs) from larch wood (Larix sibirica) in a mass ratio of 70/30%. WPs were obtained by hydrodynamic treatment that lasted for 5-45 min. Size estimation and distribution of WPs were carried out using the sieve method, and an analytical sieving machine It was found that the size of WPs decreased with increasing hydrodynamic treatment time. WPs with sizes ranging from 100 to 300 μm constituted the majority of the wood pulp. After testing, the SEM method was used to examine the WP surface and WPC samples. The mixing of WPs and PLA was carried out using the melt mixing method. WPC for the study of mechanical properties was obtained by flat pressing in a mold. Tensile tests were conducted in accordance with GOST 11262-2017, bending tests in accordance with GOST 4648-2014. It is shown that the duration of hydrodynamic treatment of WPs for 25 min provides the highest strength parameters of PLA-based WPC This can be explained by the uniform dispersion of fibrillated WPs in the polymer matrix and the formation of their adhesive bond by mechanical engagement.
Keywords: wood-plastic composite; hydrodynamic processing; larch sawdust; mechanical property; tensile strength; bending strength; wood particle size.
INTRODUCTION
Increasing concern for sustainability compels humanity to reduce environmental problems, including those caused by the use of polymers from fossil raw materials (Korhonen et al., 2018, Friedrich, 2020, Accorsi et al., 2014). Synthetic polymers based on petroleum products are very slowly destroyed in the environment, which can take hundreds of years. As a result, numerous plastic waste has already accumulated in the earth, oceans and atmosphere (Panaitescu et al., 2020). Scientific research in recent decades has helped to find a solution to this problem – using environmentally friendly biopolymers, such as polylactic acid (PLA), in everyday life, and creating polymer composites that do not harm the environment and are recyclable (Partanen et al., 2016, Naghdi, 2021, Teymoorzadeh et al., 2015, Petchwattana et al., 2020, Narlıoğlu et al., 2021)
Among biodegradable polymers, PLA is most widely used in the production of packaging materials, consumer goods, biomedicine, etc. (Partanen et al., 2016). PLA is a
biodegradable polymer derived from renewable sources such as cane, corn and other plant materials. It is carbon-neutral, compostable, does not emit hazardous decomposition products, and has high mechanical properties. However, pure PLA is a fragile material and needs modification, for example, with the help of plasticizers and reinforcing particles (Farah et al., 2021).
Natural plant fibers from renewable raw materials have a number of advantages, such as improved biodegradability, low cost, low abrasion, high specific strength, low density, etc. (Friedrich, 2020). The addition of solid dispersed or fibrous natural plant particles into the polymer matrix is carried out in order to change the physical and chemical, mechanical, thermal, frictional and other properties of materials, but the main task is to improve the physical and mechanical properties (Lipatov, 1977, Sánchez-Safont et al., 2018, Özdemir et al., 2022, Akpan et al., 2018, Mahesh et al., 2020)
Wood is widely used as a filler in wood polymer composites (WPC). Such filler can be relatively inexpensive woodworking waste. The wood filler also improves the properties of the composite. The authors Wan et al. (2019, 2018) concluded that wood flour (WF) of 150 μm < particle size < 180 μm executed the optimal improvement to mechanical properties of PLA/WF/PMMA. Tensile strength, flexural modulus and Young's modulus of PLA/WF/PMMA (150-180 μm) were enhanced 10.02%, 37.21% and 32.80% in relation to neat PLA, respectively. Reinforcement of polycaprolactone (PCL) with 0.5 to 15 wt% of WF results in the tensile strengths of PCL/5 wt% WF and PCL/15 wt% WF being 16.0 MPa and 15.0 MPa, respectively. The tensile strength of pure PCL is 13.0 MPa (Cintra et al., 2022)
The shape of the filler particles is one of the most important factors affecting the mechanical properties of the WPC (Murayama et al., 2018). Recent studies reported that WPCs with fibrous surface wood particles obtained by mechanical milling have better mechanical properties (Isa et al., 2014, Isa et al., 2016, Stark and Rowlands, 2003, Salasinska and Ryszkowska, 2015, Tanpichai and Wootthikanokkhan, 2018).
Several studies noted that making WF by wet milling significantly improves the WPC properties. Wet milling of wood can destroy the cell walls with fibril delamination on the surface. This improves WPC mechanical properties such as tensile strength, impact resistance, and fatigue life (Delviawan et al., 2019, Isa et al., 2014, Isa et al., 2016, Haque et al., 2019).
The study (Qiang et al., 2018) of bleached softwood kraft pulp obtained by wet grinding in a ball mill found that the tensile strength of the PLA-based composite is the highest when the grinding time is the longest (reinforcing particle size is the smallest). Gravelsins et al. (1988) studied the wet milling of wood in a roller mill. It was shown that wet milling is more efficient than dry one. For example, milling of pine sawdust-water slurry at 75 kW∙h/t SEC yields 350 μm particle size while milling air-dry and wet sawdust in a gas environment at the same SEC yields 570 and 990 μm particle size, respectively. For example, the SEC required to mill aspen chips down to 400 μm is 100 kW∙h/t while the SEC for dry milling is three times that amount (320 kW∙h/t). Therefore, wet milling is a promising process for making wood fillers used in biopolymer-based composites.
Our previous studies (Ermolin et al., 2019) indicate the production of wood particles dispersed to the state of fibrous material with fibrillated surfaces in the process of hydrodynamic processing. Thus, the purpose of this work is to study the influence of morphological characteristics of wood particles crushed by hydrodynamic method on the mechanical properties of wood-polymer composites.
Materials
MATERIAL AND METHODS
Sawdust from Siberian larch (Larix sibirica), 85 ± 12% moisture content, obtained from sawing logs was investigated. Polylactic acid (PLA) was used as a matrix (NatureWorks Ingeo 4043D).
Wood particles preparation
The sawdust was collected at the Krasles sawmill (Krasnoyarsk Territory, Russia). A lab-grade rotary-pulse hydrodynamic homogenizer was used (Figure 1). We mixed the sawdust with water at 8 to 10 oC (1). The sawdust content in the mixture was 10%. After mixing sawdust with water, the apparatus was switched on and repeated mass processing was carried out by passing through the hydrodynamic homogenizer (3) (rotor and stator). The rotation frequency of the rotor was 2950 rev/min. The treatment lasted for 0, 5, 15, 25, 35, 45 minutes (Delviawan et al., 2020).
After the hydrodynamic treatment, the wood particles (WPs) were frozen in a vacuum and lyophilized in a Lyoph Pride LP10 dryer (ilShin Bio Base Co., Ltd., Korea) to preserve the wood structure close to its original state with maximum swelling and hydration values. The WPs were then ground using a mixer (MMBP 1000; Robert Bosch GmbH; Germany).

Characteristics of wood particles
The WP particle size distribution with a Retsch AS 200 Control analytical sieve shaker (Retsch AS 200 control, Retsch GmbH, Haan, Germany) was estimated. There were three measurements of 10 minutes each. The dry sample weight was 6.655±1.318 g. We used a laboratory balance with an accuracy of 0.001g. We then examined the WP surface with a scanning electron microscope (SEM) (Hitachi TM4000Plus, Japan). The WPs sample was placed on a table (without any additional sample preparation). During the image capturing process accelerating voltage of 15 kV was used.
Wood-Polymer Composite Manufacturing
WPs and PLA granules were pre-dried for 12 hours at 70 ± 2 °C before preparing the composite. We blended the dry PLA/WP at 70/30 wt% (Lima et al., 2020, Khan et al., 2020, Farrokhpayam et al., 2021). The dry PLA/WPs were blended at 170 to 185°C, 13 rpm using a twin-screw micro-compounder (LTE 12-36 12, LabtechEngineeringCo. Ltd., Thailand), and then granulated.
For obtaining the dumbbell-shaped and rectangular samples, the granules were molded and pressed in a LabPro 1000 hydraulic press (FontijnePresses, Netherlands) at 200 °C with a pressure 7.5 MPa for 5 minutes, then cooled to room temperature.
The dimensions of the dumbbell-shaped samples for tensile tests were ~ 80 × 5 × 4 mm as specified in the GOST 11262-2017 standard Type 5 (ISO 527-2:2012). The dimensions of the rectangular samples for bending tests were ~ 80 × 10 × 4 mm according to the GOST 4648-2014 (ISO 178:2019)] standard (Figure 2) The density of the composite samples was 1252 ±23 kg/m3 .

All samples were conditioned at 20 °C and 65% RH for 1 week prior to each test. The moisture content of the WPC samples was ~ 0.5%. The composite samples were labeled W5, W15, W25, W35, and W45 to indicate the duration of WP hydrodynamic treatment of 5, 15, 25, 35, and 45 minutes, respectively.
Mechanical properties of wood-polymer composite
Tensile and bending tests to estimate the WPC mechanical properties were performed. The tensile test procedure was per GOST 11262-2017, and the bending test procedure was per GOST 4648-2014.
A universal testing machine (UTS-110MN-30-0U, Testsystems, Russia) for the tensile strength and 3-point bending strength tests was used Each mechanical test was performed on three samples.
The fracture surfaces of the WPC samples after tensile and bending tests using SEM (Hitachi TM4000Plus, Japan) were examined. No additional sample preparation was carried out. The WPCs were carefully fixed on aluminum stubs. Accelerating voltage was 10kV.
Statistical processing
Microsoft Excel 2010 for Windows 8 was used for statistical processing. Each test was repeated three times. The mean value, standard deviation and confidence intervals were calculated. The significance level was 0.05.
RESULTS AND DISCUSSION
Evaluation of wood particles
Figure 3 shows the WP particle size distribution. WP sizes decrease with an increase in the duration of hydrodynamic treatment. However, the particle size distributions for the 35 and 45-minute treatments are almost identical. The number of particles smaller than 20
μm increases with treatment time. For a 45-minute treatment, the number of particles smaller than 20 μm is double that of a 5-minute treatment. WPs between 100 and 300 μm make up the majority of the wood pulp treated for 10 to 45 minutes. It is supposed to be the most optimal WP dimensions for WPC with the best mechanical properties. (Murayama et al., 2019, Delviawan et al., 2020, Haque et al., 2019).

Fig. 3 WP size distribution vs. hydrodynamic treatment periods.
Hydrodynamic treatment significantly changes the morphological structure of WPs. The SEM images clearly demonstrate such changes. Figure 4 shows the microphotographs of the original WP samples and samples subjected to hydrodynamic treatment in a disperser for different periods. The WP before treatment (Figure 4a, x300 magnification) appears as small fragments of wood tissue with cellular structure. After 5 minutes of treatment, the surface lamination of the particles is clearly visible (Figure 4b). The number of small ribbon-like particles (partially destroyed tracheids with fibrillated surfaces) increases. Longer treatment increases the amount of fibrous elements and increases the fibrillated fine fraction (Figure 4c-e).
After hydrodynamic treatment in a disperser for 45 min (Figure 4f), most of the wood pulp is dispersed into fibers. The x300 magnification images show that individual fibers are fragments of cell walls with a high pore content which determines their high specific surface area.

Fig. 4 The SEM images of wood particles hydrodynamically treated for (a) 0, (b) 5, (c) 15, (d) 25, (e) 35, and (f) 45 min.
Morphological and mechanical studies
SEM was used to examine the effects of hydrodynamic treatment duration on the condition of the composite sample cross-sectional surface after bending and tensile tests. Figure 5 shows the SEM images of the fracture surface filled with PLA wood particles hydrodynamically treated for 5, 15, 25, 35, and 45 min, respectively.
The SEM images show that the wood particles are well dispersed in the matrix, and the composite is homogeneous. Note the wood particles highlighted by the dashed lines. Many of these are fractured near the sample surface, i.e., more particles are fractured than elongated. This fracture pattern is consistent with the results reported in (Shah et al., 2008). The authors indicate an improvement in the mechanical properties of a PLA-based woodpolymer composite when wood particles are added. They claim that the morphology of the composite fracture surface indicates fiber breakage, not elongation. This is a strong indication of good compatibility between the matrix and the wood filler.

The images of the fracture surface (Figure 5) show more clearly the partial delamination of the cell walls along the reinforcing elements (fibrils) due to the anisotropy of the physical and mechanical properties of the wood. The longitudinal strength is much higher than the transverse strength. The results show that the hydrodynamically treated wood particles contribute significantly to the mechanical properties of the composite. They transfer stress to the polymer matrix and reduce stress concentration. This can be explained by the increase of the interphase contact area between the PLA matrix and wood particles as the filler fibrillation occurs during the hydrodynamic treatment. Also, the study (Panaitescu et al., 2020) proposes that hydrophobic lignin present in WPs promotes adhesive interaction with the biopolymer matrix. The proposed process of WP mechanical activation can contribute to better mechanical properties of the resulting WPC.
Figure 6a demonstrates the effect of the hydrodynamic treatment duration on the WPC tensile strength. The results indicate that adding wood particles with a minimum processing time to a composite leads to a more than 40% reduction in the tensile strength compared to the initial PLA. Our previous studies have shown that the specific surface value of wood particles does not change significantly at this treatment time (Ermolin et al., 2019). This determines the small interphase contact area between wood and polymer. If the treatment time is less than 25 minutes, the WPC tensile strength increases with the treatment time. The 25 min treatment time yields the highest tensile strength of the composite, comparable with that of PLA, while the elastic modulus of the composite increases by more than 2.5 times.


(b)
Fig. 6 The effect of the hydrodynamic treatment duration on the WPC (a) tensile and (b) flexural strength.
The SEM image (Figure 5 e, f) above shows that the fracture surface contains fibrous cell wall elements of wood particles exposed to hydrodynamic treatment for 25 min, probably due to the adhesive bond between the WPs and the PLA matrix.
Mechanical locking explains adhesion: the matrix penetrates pores, holes, gaps, or other irregularities in the substrate and is mechanically locked to it. Mechanical locking occurs between the matrix and the rough surface of the natural fiber (Liu et al., 2012). If the surface is rougher, the binding area between the matrix and the WPs increases, as the bond strength at the interface (Mohammed et al., 2022, Gogoi and Manik, 20221).
If the treatment time exceeds 25 minutes, the WPC tensile strength decreases with treatment time. A 45 min. hydrodynamic treatment results in pronounced fibrillar elements with the cellular structure of the wood particle surface (Figure 4f).
The authors Isa et al. (2014) report that WPCs containing fibrillated wood particles have higher strength than WPCs with smooth surface particles.
The tensile strength of a WPC containing wood particles treated for 45 min is lower than that of a WPC containing particles treated for 25 min.
Particles treated for 45 min, compared to 25 min, are characterized by a high degree of destruction of the cell wall wood substance. This contributes to an increase in the adhesive interphase area. In this regard, it can be assumed that the adhesive bond between the WPs and the PLA matrix is stronger for a 45-minute treatment. However, there are clusters of small wood particles on the fracture surface of the WPCs containing particles treated for 45 min. These results indicate that the size of the WPs in the WPC has a greater effect on tensile strength than the fibrillated structure of the WP surface.
Figure 6b shows the effect of hydrodynamic treatment duration on the WPC bending strength.
It demonstrates correlation similar to the WPC tensile strength. A 25 min. treatment time gives the highest bending strength parameters of the WPC.
It is also proved that the bending modulus decreases with the addition of wood particles processed for more than 25 minutes. An explanation for this may be the fact that the increased processing time of WPs leads to the breakdown of many bonds between the supramolecular structures of the components, which causes fibrillation of cell walls. Such particles have a low stiffness and consequently decrease the bending modulus (Gacitua et al., 2010)
CONCLUSION
This study was aimed to investigate the mechanical properties of wood-polymer composites (WPC) made on the basis of polylactic acid (PLA) with the addition of mechanically activated wood particles (WPs). WPs were obtained by hydrodynamic treatment. As a result, it was found that hydrodynamic treatment significantly changes the morphological and anatomic structure of WPs. The mechanical properties of the WPC obtained using PLA depended on the morphological characteristics of the WPs. The duration of the hydrodynamic treatment of WPs for 25 minutes provides the strength parameters of WPC without binders, commensurate with the strength of PLA. This method made it possible to grind WPs to an average size of 100-300 μm and ensure fibrillation of their surface. It increased the interphase contact area between the PLA matrix and wood particles and, ensured their adhesive interaction without binders. A 25-minute treatment demonstrates the formation of WPs between 100 and 300 μm (about 45%), which have a substantial effect on the mechanical properties of WPC.
Furthermore, the effect of the mass ratio of the components on the physical and mechanical properties of WPC containing hydrodynamically treated WPs will be investigated.
REFERENCES
Accorsi, R., Cascini, A., Cholette, S., Manzini, R., Mora, C., 2014. Economic and environmental assessment of reusable plastic containers: A food catering supply chain case study. International Journal of Production Economics, 152, 88-101.
Akpan, E. I., Wetzel, B., Friedrich, K., 2018. A fully biobased tribology material based on acrylic resin and short wood fibres. Tribology International, 120, 381-390.
Cintra, S. C., Braga, N. F., Morgado, G. F. D. M., Montanheiro, T. L. D. A., Marini, J., Passador, F. R., Montagna, L. S. 2022. Development of new biodegradable composites materials from polycaprolactone and wood flour. Wood Material Science & Engineering, 17(6), 586-597.
Delviawan, A., Kojima, Y., Kobori, H., 2020. The influence of wet milling time of wood flour on the water resistance of wood plastic composite. Proceedings of ugsas-gu & bwel joint poster session on agricultural and basin water environmental sciences, 9
Delviawan, A., Kojima, Y., Kobori, H., Suzuki, S., Aoki, K., Ogoe, S., 2019. The effect of wood particle size distribution on the mechanical properties of wood–plastic composite. Journal of Wood Science, 65(1), 1-11.
Ermolin, V.N., Bayandin, M.A., Kazitsin, S.N., Namyatov, A.V., 2019. Structure formation of lowdensity boards from hydrodynamically activated soft wood waste. News of Higher Educational Institutions. Forest Magazine, № 5 (371), pp. 148-157. https://doi.org/10.17238/issn0536-1036.2019.5.148
Farah, S., Anderson, D. G., and Langer, R., 2016. Physical and mechanical properties of PLA, and their functions in widespread applications - A comprehensive review, Adv. DrugDeliv Rev 107, 367-392. https://doi.org/10.1016/j.addr.2016.06.012
Farrokhpayam, S. R., Shahabi, M. A., Sheshkal, B. N., Gargari, R. M., 2021. The morphology, physical, and mechanical properties of poly (lactic acid)-based wood flour and pulp fiber biocomposites. Journal of the Indian Academy of Wood Science, 18, 20-25.
Friedrich, D., 2020. Consumer behaviour towards Wood-Polymer packaging in convenience and shopping goods: A comparative analysis to conventional materials. Resources, Conservation and Recycling, 163, 105097.
Gacitua, W., Bahr, D., Wolcott, M., 2010. Damage of the cell wall during extrusion and injection molding of wood plastic composites. Composites Part A: Applied Science and Manufacturing, 41(10), 1454-1460.
Gogoi, R., Manik, G., 2021. Mechanical properties of wood polymer composites. Wood Polymer Composites: Recent Advancements and Applications, 113-136.
GOST 11262-2017 Plastics. Tensile test method.
GOST 4648-2014 Plastics. Method of static bending test.
Haque, M. M. U., Goda, K., Ito, H., Ogoe, S., Okamot, M., Ema, T., Nogami, H., 2019. Meltviscosity and mechanical behaviour of polypropylene (PP)/wood flour composites: Effect of pulverization of wood flour with and without water. Advanced Industrial and Engineering Polymer Research, 2(1), 42-50.
Isa, A , Minamino, J , Kojima, Y , Suzuki, S , Ito, H , Makise, R , Okamoto, M , Endo, T., 2016 The infuence of dry-milled wood four on the physical properties of wood four/polypropylene composites. J Wood Chem Technol 36(2):105–113
Isa, A , Toyoda, T , Suzuki, S , Kojima, Y , Ito, H , Makise, R , Okamoto, M., 2014 The efects of wet-milled wood four on the mechanical properties of wood four/polypropylene composites. J Wood Chem Technol 34(1):20–30
Khan, M. Z., Srivastava, S. K., Gupta, M. K., 2020. A state-of-the-art review on particulate wood polymer composites: Processing, properties and applications. Polymer Testing, 89, 106721. Korhonen, J., Honkasalo, A., Seppälä, J., 2018. Circular economy: the concept and its limitations. Ecological economics, 143, 37-46.
Lima, D. C., de Melo, R. R., Pimenta, A. S., Pedrosa, T. D., de Souza, M. J. C., de Souza, E. C., 2020. Physical–mechanical properties of wood panel composites produced with Qualea sp. sawdust and recycled polypropylene. Environmental Science and Pollution Research, 27(5), 4858-4865.
Lipatov Yu. S., 1977. Physical chemistry of filled polymers [Text] / Yu.S. Lipatov. - Moscow : Chemistry 304 p.
Liu, D., Song, J., Anderson, D. P., Chang, P. R., Hua, Y., 2012. Bamboo fiber and its reinforced composites: structure and properties. Cellulose, 19, 1449-1480.
Mahesh, D., Kowshigha, K. R., Raju, N. V., Aggarwal, P. K., 2020. Characterization of banana fiber-reinforced polypropylene composites. Journal of the Indian Academy of Wood Science, 17, 1-8.
Mohammed, M. M., Rasidi, M., Mohammed, A. M., Rahman, R. B., Osman, A. F., Adam, T., Dahham, O. S., 2022. Interfacial bonding mechanisms of natural fibre-matrix composites: an overview. BioResources, 17(4), 7031.
Murayama, K., Yamamoto, M., Kobori, H., Kojima, Y., Suzuki, S., Aoki, K., Okamoto, M., 2018. Mechanical and physical properties of wood–plastic composites containing cellulose nanofibers added to wood flour. Forest products journal, 68(4), 398-404.
Murayama, K., Ueno, T., Kobori, H., Kojima, Y., Suzuki, S., Aoki, K., Okamoto, M., 2019. Mechanical properties of wood/plastic composites formed using wood flour produced by wet ball-milling under various milling times and drying methods. Journal of Wood Science, 65(1), 1-10.
Naghdi, R., 2021. Advanced natural fibre-based fully biodegradable and renewable composites and nanocomposites: a comprehensive review. International Wood Products Journal, 12(3), 178193.
Narlıoğlu, N., Salan, T., Alma, M. H., 2021. Properties of 3D-printed wood sawdust-reinforced PLA composites. BioResources, 16(3), 5467.
Özdemir, F., Ayrilmis, N., Yurttaş, E., 2022. Mechanical and thermal properties of biocomposite films produced from hazelnut husk and polylactic acid. Wood Material Science & Engineering, 17(6), 783-789.
Panaitescu, D. M., Nicolae, C. A., Gabor, A. R., Trusca, R., 2020. Thermal and mechanical properties of poly (3-hydroxybutyrate) reinforced with cellulose fibers from wood waste. Industrial cropsand products, 145, 112071.
Partanen, A., Carus, M., 2016. Wood and natural fiber composites current trend in consumer goods and automotive parts. Reinforced Plastics, 60(3), 170-173.
Petchwattana, N., Naknaen, P., Narupai, B., 2020. A circular economy use of waste wood sawdust for wood plastic composite production: Effect of bio-plasticiser on the toughness. International Journal of Sustainable Engineering, 13(5), 398-410.
Qiang, T., Wang, J. W., Wolcott, M. P., 2018. Facile preparation of cellulose/polylactide composite materials with tunable mechanical properties Polymer-Plastics Technol. Eng. 57(13), 12881295. https://doi.org/10.1080/03602559.2017.1381243
R.J. Gravelsins, Studies of Grinding of Wood and Bark-wood Mixtures with the Szego Mill, Doctoral dissertation Toronto University, 1998, https://tspace.library. utoronto.ca/handle/1807/12007(accessed March 30, 2023).
Salasinska, K., Ryszkowska, J., 2015. The effect of filler chemical constitution and morphological properties on the mechanical properties of natural fiber composites. Composite Interfaces, 22(1), 39-50.
Sánchez-Safont, E. L., Aldureid, A., Lagarón, J. M., Gámez-Pérez, J., Cabedo, L., 2018. Biocomposites of different lignocellulosic wastes for sustainable food packaging applications. Composites Part B: Engineering, 145, 215-225.
Shah, B. L., Selke, S. E., Walters, M. B., Heiden, P. A., 2008. Effects of wood flour and chitosan on mechanical, chemical, and thermal properties of polylactide. Polymer Composites, 29(6), 655-663.
Stark, N. M., Rowlands, R. E., 2003. Effects of wood fiber characteristics on mechanical properties of wood/polypropylene composites. Wood and fiber science, 167-174.
Tanpichai, S., and Wootthikanokkhan, J., 2018. Reinforcing abilities of microfibers and nanofibrillated cellulose in poly (lactic acid) composites Sci. Eng. Composite Mater 25(2), 395-401. https://doi.org/10.1515/secm-2016-0113
Teymoorzadeh, H., Rodrigue, D., 2015. Biocomposites of wood flour and polylactic acid: Processing and properties. Journal of Biobased Materials and Bioenergy, 9(2), 252-257.
Wan, L., Zhang, Y. H., 2018. Jointly modified mechanical properties and accelerated hydrolytic degradation of PLA by interface reinforcement of PLA-WF, J. Mechan. Behav Biomed Mater. 88, 223-230. https://doi.org/10.1016/j.jmbbm.2018.08.016
Wan, L., Zhou, S., Zhang, Y., 2019. Parallel advances in improving mechanical properties and accelerating degradation to polylactic acid. International journal of biological macromolecules, 125, 1093-1102.
ACKNOWLEDGMENTS
This research was carried out within the state assignment of the Ministry of Science and Higher Education of the Russian Federation for the implementation of the project “Development of multifunctional smart materials and structures based on modified polymer composite materials capable to function in extreme conditions” (project number FEFE-2020-0015).
This research was partially carried out using the equipment of Krasnoyarsk Regional Center of Research Equipment of Federal Research Center “Krasnoyarsk Science Center SB RAS” (Nemtsev I. V.) and Siberian Federal University (Kiselev E. G.)
AUTHORSʼ ADDRESSES
Sergei Kazitsin
Aleksey Namyatov
Mikhail Bayandin
Nina Grotskaya
Reshetnev Siberian State University of Science and Technology 31 KrasnoyarskyRabochy Av, Krasnoyarsk 660037, Russian Federation sergeikaz060890@yandex.ru namyatov2010@yandex.ru mihailbayandin@yandex.ru grotskayanina@mail.ru
ACTA FACULTATIS XYLOLOGIAE ZVOLEN, 66(1): 59 73, 2024
Zvolen, Technická univerzita vo Zvolene
DOI: 10.17423/afx.2024.66.1.05
MONITORING OF MICROCLIMATIC CONDITIONS AND THE OCCURRENCE OF MICROMYCETES IN CRAWL SPACE
Slávka Pobucká – Libor Kalhotka – Monika Laichmanová – Karel Šuhajda
ABSTRACT
The risk of creating suitable microclimatic conditions for the growth and development of micromycetes in a crawl space is relatively high. Spores of micromycetes can infiltrate the living space through leaks in ceiling construction of the crawl space due to pressure conditions. The study is focused on monitoring microclimatic conditions and the occurrence of micromycetes in the crawl space in the Czech Republic. Samples were taken from the crawl space structures (ceiling structure and foundation walls) using sponges. Additionally, sedimentation methods were used to monitor the indoor microclimate (in the crawl space) and the outdoor microclimate. In the crawl space, spores of micromycetes of the genera Alternaria, Aspergillus, Cladosporium, Didymella, Epicoccum, Sarocladium, Sordaria and Penicillium were detected. The relative humidity in the crawl space ranged from 50% to 95% during the model year. In total, 6,659 hours were spent in the crawl space with a relative humidity of about 75%.
Keywords: airborne fungi; crawl space; relative humidity; micromycetes
INTRODUCTION
Crawl space foundation is based on the foundation of the building above an air cavity. The floor of the first floor is placed over a cavity, which is usually ventilated by outside air. The advantages of the crawl space include easier access to the plumbing and sanitary installations or the possibility to keep timber elements protected from splashing water. Additionally, crawl space also accommodates construction in floodplains (Werther and Winter, 2009) Despite its advantages, crawl space poses potential risks The risks are related to thermal and humidity behaviour of the internal microclimate of the crawl space. The source of moisture can be incoming outdoor air or rising ground moisture in the crawl space (Viitanen et al., 2010). Condensation can occur on the cooler surfaces of the crawl space structure especially during summer months when warmer outdoor air enters the crawl space If the temperature difference between the exterior air and the crawl space (air, surface) is high, the crawl space becomes more problematic in terms of moisture conditions. A time lag is caused by the specific heat capacity of the foundations and soil, as temperatures slowly equalize between the outside and inside air in the crawl space (Matilainen and Kurnitski, 2003; Laukkarinen and Vinha, 2017; Airaksinen et al., 2020).
Crawl space can be ventilated naturally or with a ventilation system. The ventilation system can be depressurised or a pressurised. The pressure difference between the indoor living space and the crawl space is usually up to 10 Pa (Keskikuru et al., 2018; Salo et al ,
2018). The depressurization system is based on the principle of creating a slight depressurization in the crawl space compared to the outside environment. The depressurization of the crawl space causes increased flow of radon, flow of outside air or flow of ground moisture into the crawl space. Crawl space depressurization can reduce indoor radon from 70% to 96%. The pressurization system is based on the principle of drawing outside air into the crawl space. The flow of radon is restricted by pressurising the crawl space There is a risk of air infiltration from the crawl space through leaks in the ceiling structure into the living space with a pressurization system (Henschel, 1992; Keskikuru et al., 2018). Microbial contamination can enter the living space through leaks in the ceiling structure of the crawl space These are, for example, spores of filamentous micromycetes (moulds) that are present in the air, in water, in soil or on the surfaces of animals The study (Airaksinen et al , 2004a) focused on laboratory measurements of the transport ofmould spores throughatimber crawl space floorstructure. The numberofspores in the air is influenced by seasonality, with the highest incidence from May to September. Maximum exposure to fungal spores is observed in the summer and autumn in regions with a moderate climate. Airborne spores of Alternaria, Cladosporium and Helminthosporium are mainly observed in dry and summer days. Conidia of ascomycetes or basidiospores are released after rain and at night (Malíř and Ostrý, 2003) Aspergillus, Alternaria, Cladosporium, Epicoccum, Penicillium, Mucor, Rhizopus and Syncephalastrum are commonly observed genera in the air (Yates et al., 2016)
Air infiltration from the crawl space into the living space is influenced by the pressure conditions of the crawl and living spaces, the outdoor climatic conditions (wind speed, outdoor air temperature), and the airtightness of the ceiling structure. If the living space is ventilated by a mechanical unbalanced system (exhaust air is greater than supply air), a higher positive pressure differential across the crawl space ceiling structure can occur, i.e., depressurization of the living space takes place. The implication is an increased flow of microbial contaminants into the living space (Domhagen et al., 2021). The pressure difference can be high, from 5 to 10 Pa. The pressure difference between the living space and the crawl space is not as high (from 0 to 2 Pa) when the living space is ventilated with a mechanical balanced system (Airaksinen et al., 2004b). The issue of infiltration of contaminated air was discussed in a recent study (Domhagen et al , 2021), that investigated the concentration of microbial contaminants in school classrooms. The concentration of contaminants was highest in the class with low outside winds and moderate outside temperatures.
Some micromycetes can have a negative impact on human health, causing mycotic infections (mycoses), allergic reactions (mycoallergies), or mycotoxicosis. Mycotoxins, produced by certain fungi, can lead to a range of adverse health effects and pose a serious health risk (Kraft et al., 2021). Respiratory illnesses, conjunctivitis, or asthma can occur in humans in a mould contaminated environment (Kalhotka, 2014). Respiratory tract problems are often referred to as Sick Building Syndrome (SBS) (Crook and Burton, 2010). Volatile organic compounds (VOCs) can be produced by the decomposition of moulds VOC serves as an indicator of mould activity and growth. Aspergillus, Cladosporium and Penicillium are strong VOC producers. High concentrations of VOCs (250 µg/m3) can cause irritation of mucous membranes, eyes, ears, or headaches in humans. These substances can act as allergens. In addition to affecting human health, the presence of mould in the indoor environment also has a negative impact on building structures Moulds can be involved in the biocorrosion of materials. Moulds also produce organic acids (e.g. oxalic acid, acetic acid, etc.) which can then react with the components of the building material and decompose them (Mihinová and Piecková, 2007; Kalhotka, 2014)
Theinfiltration of fungal spores depends on thepressuredifference between thecrawl space and the living space, on the size of the spores, and the degree of disturbance of the ceiling structure. The spore size of microscopic fungi ranges from 1 µm to 100 µm and depends on the species (Keskikuru et al., 2018). According to Johansson et al., (2005), in terms of risk for indoor environment contamination when pressurization of the crawl space occurs, this is classified in the range between medium and high category. All ventilation systems are included in this category (medium and high risk) because pressure conditions can be affected by wind.
The occurrence and development of microorganisms and the subsequent production of mycotoxins are influenced by environmental conditions such as humidity, temperature, substrate material, oxygen availability, sporulation and microbial interactions. Water is the main factor that influences mould growth. The factor that takes into account the availability of water for the growth of mould in the building material is called water activity aw (Malíř and Ostrý,2003; Yates et al.,2016).Thewater activitycanbeexpressed as equivalent to the equilibrium relative humidity (Yates et al., 2016), (1)
Equilibrium Relative Humidity (ERH), represents the equilibrium between the relative humidity of the surrounding air and the moisture content (MC) of a given material (Pasanen et al., 2000). Pasanen et al. (2000) found in their study that mould, yeasts, and bacteria require an ERH of at least 90-95% for germination and growth. Regarding microorganism growth, wood is at risk when its moisture content (MC) exceeds 20%, and (ERH) is between 80-85% (Pasanen et al., 2000) Malíř and Ostrý (2003) found that for optimal mould growth, the water activity (aw) of the material should be in the range of 0.6 to 0.99, and the relative humidity should be maintained between 80-100%. The ideal air temperature for mould growth falls within the range of 18-28°C. Some moulds can grow even at temperatures ranging from 0°C to 60°C.
Thestudy (Viitanen et al.,2010)determined,that thecritical ambient relativehumidity for mould is 75% at temperatures between 0°C and 50°C. The critical relative humidity is 75-80% for wood and wood based materials. The critical relative humidity is 90-95% for concrete (Johansson et al , 2005) Mould spore germination can take place at a relative humidity of 60%. Nevertheless, active growth is observed at relative humidity of 75-80%, accompanied by the production of CO2. Peak mould growth occurs at relative humidity approaching 100%. However, growth typically decreases at a relative humidity of 100% due to the formation of a thin layer of water on the material surface, restricting the entry of oxygen, which is essential for mould growth (Balík, 2008)
Importance of Microclimate Stability
The duration of exposure to critical conditions is crucial (Sedlbauer, 2002; Isaksson et al., 2010). Even a brief period of wetting is adequate for mould development and the release of spores. The microclimate layer aids mould in surviving low relative humidity conditionsduringhumidityfluctuationsThismicroclimatelayerislocatedin closeproximity to the construction's surface. A stable level of relative humidity is essential for mould development and growth. Mould growth on the surfaces of a structure occurs only when the relativehumidityoftheairandthe relativehumidityofthematerialarein equilibrium (Balík, 2008) The dew point temperature is an important factor in the moisture content of the building material. The dew point temperature can be determined from the Mollier
Hx diagram or by mathematical equations. There are several mathematical equations, for example equation (2) (Lawrence, 2005)
Where, RH is air relative humidity, factor A1 = 17.625, B1 = 243.04°C. Condensation occurs on the surface of a structure when the air temperature falls below the dew point temperature.
MATERIALS AND METHODS
In October 2022, surface and indoor microclimate monitoring of a crawl space was conductedonatimberhouselocatedintheCzechRepublic.Thehouseisadetachedstructure with a rectangular plan, measuring 10.680 × 6.740 meters. The crawl space is constructed using concrete blocks (breeze blocks) supported by foundation strips, with a 0.115 W/(m²K) U-value (heat thermal transmittance value) of the ceiling structure The crawl space is divided into two tracts, namely a small tract with a floor area of 23.6 m² and a large tract with a floor area of 36 4 m². Both tracts have a height of 1.2 meters, and the bottom of the crawl space is situated approximately 750 mm below ground level. The bottom of the crawl space is covered with geotextiles and a layer of aggregate (size 16/32 mm). The layer of aggregate is 150 mm thick. Natural ventilation is provided to the crawl space through ventilation holes in the foundation walls, each hole measuring 500 × 250 mm.
Monitoring Parameters
Various parameters were continuously monitored at 15-minute intervals, including air temperature, relative humidity, airflow velocity, the surface temperature of the ceiling structure, and surface temperature of the crawl space bottom (approximately 50 mm below the bottom surface). For these measurements, Omega PLTH temperature and humidity sensors, as well as Omega PLTT temperature Almemo FVAD 35 hot-wire thermoanemometers, were employed in the crawl space. The outdoor climatic conditions were measured at approximately 700 m aerial distance from the monitored house by Mobile Alerts sensors. The outdoor temperature and humidity sensor was placed 1.25 m above the ground. Around the sensor was natural terrain - grass. The sensor was not exposed to direct sunlight. Small variations in outdoor conditions are expected, due to the location
Microbial Analysis of Crawl Space Microclimate
The sedimentation method was used for the qualitative and quantitative determination of airborne microorganisms in the crawl space. This technique is based on the natural tendency of microorganisms to settle (sediment) on solid surfaces (Klánová, 2001; Klánová and Vrkoslavová, 2021). Petri dishes containing Plate Count Agar (PCA BIOKAR Diagnostics, France) and Chloramphenicol Glucose Agar (BIOKAR Diagnostics, France) were strategically placed within the crawl space tracts, ensuring a minimum distance of 100 mm and a maximum of 300 mm between the dishes Fig. 1. In the crawl space, the petri dishes were placed in the centre of the small tract (sample SP1) and in the centre of the large tract (sample SP2). Outdoors, the Petri dishes were placed approximately 2 m from the monitored house (sample EX). The duration of exposure in the absence of human presence was set at 1 × 30 minutes Sampling was carried out on 10 October 2022. All
samples were placed inside a refrigerated box and transported to a laboratory (within 24 hours), maintaining a temperature range of 1-8°C. Petri dishes with PCA were incubated at 30°C for 72 hours. Petri dishes with Chloramphenicol Glucose Agar were incubated at 25°C for 5 days. The growth of microorganisms in the crawl space and in the outdoor environment was then visually compared.

Microbial Analysis of Crawl Space Structures
Chloramphenicol Glucose Agar
Plate Count Agar (PCA)
The investigation of crawl space surfaces was carried out in accordance with ČSN EN ISO 18593 (2019). A systematic sampling network was established within the crawl space, with each sampling point covering an area of 100 cm². Six samples were collected on the crawl space ceiling structuremade from fibreboard (samples b1 to b6) andonesampleon the foundation concrete wall (sample c1). Sampling was performed using sponges moistened with a buffered peptone water solution (BIOING, SR18-10BPW-G) Fig. 2 to enhance adhesion to the surfaces to be analysed and to ensure optimal conditions for microbial detection Samples were also taken on 10 October 2022.



These sponges were handled aseptically when removed from their protective packaging. The surface was sampled horizontally and vertically simultaneously with alternating sides of the sponge. Surface sampling was conducted by applying moderate pressure, and to prevent contamination, the protective bags were securely sealed. All samples were placed inside a refrigerated box and transported to a laboratory (within 24 hours), maintaining a temperature range of 1-8 °C
The swab sponges were shaken on a STOMACHER homogeniser in sterile polyethylene bags with 40 ml sterile saline solution for 1 minute. Subsequently, 1 ml and 0.1 ml were inoculated onto the surface of Chloramphenicol Glucose Agar for the selective detection ofyeasts and moulds andPCAfortheenumerationoflive, culturableheterotrophic microorganisms including bacteria, yeasts and moulds. Petri dishes with a diameter of 9 cm were inoculated in two replicates and then incubated at 30 °C for 72 h (Plate Count Agar) and at 25°C for 5 days (Chloramphenicol Glucose Agar). The number of microorganisms was expressed as colony forming units per 100 cm2 (CFU/100 cm2). For identification, morphologically distinguishablecolonies offilamentous fungiwereisolated andsubcultured on Chloramphenicol Glucose Agar at 25°C to obtain an axenic culture.
Identification of fungal isolates
Representatives of visually distinct groups of filamentous fungi were selected for identification. Determination to the genus level was based upon macroscopic and microscopic morphological characteristics. Micromorphology was examined using the slide culture technique (Riddell, 1950) from seven-day-old cultures grown on Malt Extract Agar (MEA, OxoidTM) in the dark at 25 °C. Lactic acid was used as an observation medium. The microscopic slides were examined with an Olympus BX 53 light microscope and microphotographs were taken with an Olympus DP74 digital camera. Non-sporulating isolates producing only mycelium were cultivated on Soil Extract Agar, SEA (Crous, 2009) at 20°C, 12 h under near-UV light and 12 h in the dark for two weeks to stimulated sporulation. Macromorphology, which encompasses colony texture and pigmentation, type of aerial mycelium and presence of fungal structures such as ascomata, pycnidia, sclerotia or sporodochia, was assessed on seven-day-old cultures growing on Sabouraud Dextrose Agar (OxoidTM) at 25°C in the dark. A scheme of microbial analyses is shown in Fig. 3






Fig. 3 Chart of microbial analysis of crawl space environment.
RESULTS AND DISCUSSION
A total of six sensors were employed to monitor temperature and relative humidity throughout the model year, spanning from April 2022 to April 2023, within the crawl space. The sensors were located on the ceiling structure of the crawl space. These sensors were
strategically placed on the ceiling structure of the crawl space, with sensors labeled 11, 12, and 13 situated in the small tract, and sensors 14, 15, and 16 positioned in the large tract. 24-hour averages of temperature and relative humidity were determined. 24-hour average temperatureandrelative humidityvalueswerecomputedforeach tract, revealingdifferences between the two. The following table, Tab. 1, presents the average values of air temperature and relative humidity within the crawl space during the model year where it is clear that the average temperature was lower in the small tract in contrast to the relative humidity which was higher.
Tab. 1 Avarage temperature a relative humidity in the crawl space for the model year.
Air temperatures within both the small tract (sensors 11, 12, 13) and the large tract (sensors 14, 15, 16) exhibited minimal variance, as shown in Fig. 4. Across all sensors, the standard deviation of air temperature remained within 0.4 °C. Throughout the model year, the average air temperature was 10.5 °C (average value determined from all sensors).

Fig. 4 Temperature in the crawl space, (24-hour average).
In contrast, relative humidity showed considerable fluctuations between the small and large tracts, as depicted in Fig. 5. Despite these variations, the standard deviation of relative humidity acrossall sensorsremained within4%. Sensors12and 15were compared,showing a standard deviation of 5%. The relative humidity averaged 74.5% (average value determined from all sensors) within the crawl space.

Fig. 5 Relative humidity in the crawl space, (24-hour average).
A comprehensive study conducted by Laukkarinen and Vinha (2017) focused on eleven temperature-related indicators describing microclimatic conditions in crawl spaces. These indicators included data such as the number of hours during which relative humidity exceeded 80% or 90% in the crawl space and the annual average temperature difference between outdoor air and crawl space air. The data from these indicators are summarized in Tab. 2 It is important to note that, as indicated by (Viitanen et al., 2010) a critical threshold for mould growth is a relative humidity of 75%. Therefore, this value was taken into account and assessed. In total, 6,659 hours were spent in the crawl space with a relative humidity of about 75%. This was assessed using data from central sensors 12 and 15. Additionally, during the model year, the average crawl space temperature was 0.9°C higher than the average outdoor temperature
2 Microclimatic indicators and relative humidity in the crawl space during the model year.
These findings underscore the significant influence of relative humidity on crawl space conditions. Specifically, the crawl space frequently experienced relative humidity levels above 75%, providing favorable conditions for mould growth, as suggested by (Viitanen et al., 2010). An interesting study by Risberger and Westerlund (2020) looked at monitoring the microclimate in a subarctic climate using a dehumidifier. There was no risk of mould growth when using a dehumidifier.
Dewpoint Temperature and Condensation Risk
The dewpoint temperature was calculated according to equation (2) and compared with the surface temperature of the crawl space ceiling structure, as illustrated in Fig. 6. While the dewpoint temperature remained below the surface temperature of the ceiling structure, it's important to note that these measurements were conducted in the large tract of the crawl space. Variations may exist in the smaller tract. Of particular concern was the month of January 2023, during which the air temperature was typically higher than the
dewpoint temperature in most measurements across the entire crawl space. Only one day in October 2022 and January 2023 witnessed the dewpoint temperature being higher than the air temperature in the crawl space, indicating a potential risk of condensation.

Fig. 6 Dewpoint outdoor temperature and surface temperature of the board sensor.
Microbial Analyses of Crawl Space Environment
Thesedimentation method was employed to collect mould spores from thecrawl space environment. Both the outdoor microclimate (EX) and the microclimate of the crawl space (SP1, SP2) showed a notable occurrence of mould spores (Fig. 7), which can be attributed to the crawl space's ventilation with untreated outside air. Consequently, the occurrence of mould spores in the exterior microclimate was comparable to that within the crawl space. No visible growth of filamentous micromycetes was observed on the surfaces of the walls and ceiling structure of the crawl space. The number of moulds on the ceiling structure (fibreboard) was lower than on the concrete wall constructed from breeze blocks (sample c1). The greater porosity of concrete blocks, relative to fibreboards, provides a higher likelihood of spore entrapment. The highest number of mould spores was found in the corners of the crawl space ceiling, as shown in samples b1 and b6 (Fig. 7).
The enumeration results of the microorganisms from the swabs of crawl space (Tab. 3) show that the highest number of microorganisms was found in sample b6, specifically 818 CFU/100 cm2. The highest mould count of 109 CFU/100 cm2 was found in samples b1 and b6, both of which located in the corners of the crawl space. It was also found that, the mould occurrence was higher in the small tract than in the large tract. No yeasts were detected in any sample.
Tab. 3 Numbers of colony forming units (CFU/100 cm2) of bacteria and moulds isolated from the crawl spaces swabs cultivated on Plate Count Agar.
Marking of sampling points in the crawl space
cm2

Fig. 7 Results of isolation of fungal community from the crawl space environment, medium Chloramphenicol Glucose Agar.
A total of 19 isolates of microscopic fungi visually representing different groups, were selected for identification. Of these, 17 isolates of filamentous micromycetes were successfully identified in eight genera (Fig. 8) Two isolates could not be assigned to any genus due to the lack of morphological characters. Penicillium, Alternaria, and Aspergillus appeared as dominant genera both in the microclimate crawl space and in the outdoor environment (Fig. 9) The genus Penicillium was observed on the ceiling structure of the crawl space and also on the concrete wall.

8 Results of identification of selected isolates.



The genus Penicillium is a typical representative of the moulds that occur in crawl spaces Additionally, genera such as Aspergillus or Cladosporium are present Penicillium and Aspergillus produce smaller spores that are more easily released into the air than Cladosporium. This is one of the reasons why Penicillium is the most common indoor contaminant (Airaksinen et al , 2004b) The occurrence of the genus Penicillium is also reported in a study (Bok et al., 2009), in which 212 crawl spaces were analysed for microorganisms. The dominant genus in these spaces was Penicillium corylophilum Another study (Airaksinen et al., 2004b) investigated the contamination of the indoor environment caused by mechanical ventilation of the interior. Species of the genera Penicillium, Aspergillus, Cladosporium and Acremonium were most frequently identified Thehighest concentrationofmould spores was observed in summer (Airaksinen et al., 2004, b) The study (Hyvärinen et al , 2002) investigated the occurrence of mould on various materials, e.g. fibreboards, wooden boards, plasterboards, ceramic tiles and concrete elements. Penicillium was the dominant genus on the observed materials (Hyvärinen et al., 2002)
In this study, the high prevalence of Penicillium and Aspergillus in the crawl space was remarkable. Many species of the genera mentioned are marginally xerophilic or xerophilic, allowing them to thrive in drier conditions Together with the ability to reproduce rapidly asexually they are more competitive in this environment (Pitt, 1999; Bok et al , 2009) The presence of these moulds can be attributed to the relatively dry conditions in the crawl space and the limited competition from other mould species (Bok et al., 2009). Cladosporium and Alternaria, on the other hand, tend to occur on damp cellar walls (Kalhotka, 2014) The ability of moulds to reproduce plays an important role in their spread and colonisation of different substrates, as not all spores released survive and germinate under unfavourable conditions. Some fungi avoid this risk by only producing spores when they have optimal conditions for germination and reproduction. However, other fungi, such as Penicillium and Aspergillus, produce dormant spores that germinate immediately when environmental conditions become favourable. Increase water availability is often sufficient for the transition of dormant spores to the metabolically active state (Mysyakina et al., 2016; Zabel and Morrell, 2020).
Moulds require suitable conditions for their growth and development, with relative humidity and air temperature being crucial factors. Typically, active mould growth occurs at a relative humidity of 75-80%, with an optimal air temperature range of 18-28°C (Malíř and Ostrý, 2003; Balík, 2008). The air temperature at the time of sampling was 8.8°C and relative humidity was 87.2%. Due to the lower-than-optimal temperature, no visible mould growth was observed on the crawl space structures, although mould appeared in the form of spores from various genera. These genera of saprotrophic fungi are commonly found in the air and soil
Crawl space microclimatic conditions vary considerably throughout the year, impacting mould growth and development. The stability of relative humidity is important for mould production, as growth occurs when equilibrium between the air and material's relativehumidity isachieved(Balík,2008).Mouldspores caninfiltrateliving spaces through windows during ventilation. Changes in pressure conditions within the crawl space, such as overpressure, pose a potential risk of contaminated air entering living spaces. Pressure conditions can be altered by wind flow around the house (Johansson et al., 2005). Visible mould growth indicates a higher concentration of spores in the air, potentially increasing the risk of contamination in living spaces.
CONCLUSION
In this study, the occurrence of moulds in the crawl space was closely monitored during the month of October in the Czech Republic. Additionally, the microclimatic conditions both outdoors and in the crawl space were thoroughly documented. Over 474 hours were recorded with relative humidity exceeding 90% in the crawl space. The relative humidity above 75% persisted for a total of 6,659 hours within the crawl space during the measurements. The dewpoint temperature remained lower than the surface temperature of the crawl space ceiling structure, especially in the larger tract.
Mould spores of various genera, including Alternaria, Aspergillus, Cladosporium, Didymella, Epicoccum, Sarocladium, Sordaria and Penicillium were identified on the surfaces of the crawl space. The genus Penicillium was found on both the ceiling structure (fibreboard) and the foundation wall (concrete blocks). No visible mould growth was observed on the surfaces of the walls and ceiling structure in the crawl spaces. Penicillium, Aspergillus, Alternaria, and Cladosporium were particularly dominant in the crawl space and outdoorenvironment,with Penicillium and Aspergillus being moreabundant dueto their smaller spores and adaptability to dry conditions. The results of this study highlight the importance of controlling relative humidity in crawl spaces to prevent mould growth and the potential health risks associated with it.
REFERENCES
Airaksinen, M., Kurnitski, J., Pasanen, P., Seppänen, O., 2004a. Fungal spore transport through a building structure. Indoor air, 14(2), pp.92-104.
Airaksinen, M., Pasanen, P., Kurnitski, J., Seppänen, O., 2004b. Microbial contamination of indoor air due to leakages from crawl space: a field study. Indoor air, 14(1), pp.55-64.
Airaksinen, M., Olsson, L., Kurnitski, J., Hvidberg, S., 2020. Highly insulated crawl spaces with controlled minimal ventilation - Proof of concept by field measurements. E3S Web of Conferences, 172, p.7004.
ČSN EN ISO 18593 Mikrobiologie potravinového řetězce - Horizontální metody specifikující technikyvzorkovánízpovrchů[Microbiologyofthefoodchain-Horizontalmethodsspecifying sampling techniques from surfaces]
Balík, M., 2008. Odvlhčování staveb 2 [Dehumidification of buildings 2], přeprac. vyd., Praha: Grada.
Bok, G., Hallenberg, N., Åberg, O., 2009. Mass occurrence of Penicillium corylophilum in crawl spaces, south Sweden. Building and environment, 44(12), pp.2413-2417.
Crook, B., Burton, N., 2010. Indoor moulds, Sick Building Syndrome and building related illness. Fungal biology reviews, 24(3), pp.106-113.
Crous, P., 2009. Fungal biodiversity, Utrecht: CBS-KNAW Fungal Biodiversity Centre Utrecht. Domhagen, F., Wahlgren, P., Hagentoft, C., 2021. Impact of weather conditions and building design on contaminant infiltration from crawl spaces in Swedish schools Numerical modeling using Monte Carlo method. Building simulation, In Press.
Henschel, D., 1992. Indoor Radon Reduction in Crawl-space Houses: A Review of Alternative Approaches. Indoor air, 2(4), pp.272-287.
Hyvärinen, A., Meklin, T., Vepsäläinen, A., Nevalainen, A., 2002. Fungi and actinobacteria in moisture-damaged building materials – concentrations and diversity. International biodeterioration & biodegradation, 49(1), pp.27-37.
Isaksson, T., Thelandersson, S., Ekstrand-tobin, A., Johansson, P., 2010. Critical conditions for onset of mould growth under varying climate conditions. Building and environment, 45(7), pp.17121721.
Johansson, P., Samuelson, I., Ekstrand-Tobin, A., Mjörnell, K., Sandberg, P.I., Sikander, E., 2005.
Microbiological growth on building materials – critical moisture levels. State of the art. , p.16. https://bwk.kuleuven.be/bwf/projects/annex41/protected/data/SP%20Oct%202005%20Paper% 20A41-T4-S-05-3.pdf [Accessed 2023-03-02].
Kalhotka, L., 2014. Mikromycety v prostředí člověka: vláknité mikromycety (plísně) a kvasinky [Micromycetes in the human environment: filamentous micromycetes (molds) and yeasts], Brno: Mendelova univerzita.
Keskikuru, T., Salo, J., Huttunen, P., Kokotti, H., Hyttinen, M., Halonen, R., Vinha, J., 2018. Radon, fungal spores and MVOCs reduction in crawl space house: A case study and crawl space development by hygrothermal modelling. Building and environment, 138, pp.1-10.
Klánová, K., 2001. Standardní operační postupy pro vyšetřování mikroorganismů v ovzduší a pro hodnocení mikrobiologického znečištění ovzduší ve vnitřním prostředí, Praha: Státní zdravotní ústav v Praze [Standard operating procedures for the investigation of microorganisms in the air and for the assessment of microbiological air pollution in the indoor environment, Prague: State Health Institute in Prague.].
Klánová,K.,Vrkoslavová,J.,2021.Standardníoperační postupyprovyšetřovánívnitřníhoprostředí, Státní zdravotní ústav[Standard Operating Proceduresfor Indoor Environmental Investigations, State Health Institute] http://www.szu.cz/uploads/documents/knihovna_SVI/pdf/2021/AHEM_4_2021.pdf [Accessed 2022-08-22].
Kraft, S., Buchenauer, L., Polte, T., 2021. Mold, mycotoxins and a dysregulated immune system: A combination of concern?. International journal of molecular sciences, 22(22), p.12269.
Laukkarinen,A.,Vinha,J.,2017.Temperatureandrelativehumiditymeasurementsanddataanalysis of five crawl spaces. Energy Procedia, 132, pp.711-716.
Lawrence, M., 2005. The Relationship between Relative Humidity and the Dewpoint Temperature in Moist Air. Bulletin of the American Meteorological Society, 86(2), pp.225-233. http://climate.envsci.rutgers.edu/pdf/LawrenceRHdewpointBAMS.pdf [Accessed 2023-07-04].
Malíř, F., Ostrý, V., 2003. Vláknité mikromycety (plísně), mykotoxiny a zdraví člověka Vyd. 1., Brno: Národní centrum ošetřovatelství a nelékařských zdravotnických oborů [Filamentous micromycetes (molds), mycotoxins and human health Ed. 1., Brno: National Center for Nursing and Non-Medical Health Professions]
Matilainen, M., Kurnitski, J., 2003. Moisture conditions in highly insulated outdoor ventilated crawl spaces in cold climates. Energy and buildings, 35(2), pp.175-187.
Mihinová, D., Piecková, E., 2007. Syndróm chorých budov – nešpecifické zdravotné ťažkosti obyvateľov problémových budov a ich príčiny. Verejné zdravotníctvo [Syndrome of sick buildings - non-specific health problems of residents of problem buildings and their causes. Public health], VII(3), p.7. http://verejnezdravotnictvo.szu.sk/SK/2010/3/Mihinova.pdf [Accessed 2023-11-08].
Mysyakina, I., Kochkina, G.A., Ivanushkina, N.E., Bokareva, D.A., Feofilova, E.P., 2016. Germinationofsporesofmycelialfungiinrelationtoexogenousdormancy.Microbiology(New York), 85(3), pp.290-294.
Pasanen, A., Kasanen, J.-pekka, Rautiala, S., Ikäheimo, M., Rantamäki, J., Kääriäinen, H., Kalliokoski, P., 2000. Fungal growth and survival in building materials under fluctuating moisture and temperature conditions. International biodeterioration & biodegradation, 46(2), pp.117-127.
Pitt, J., Robinson, R. ed., 1999. Penicillium | Introduction. Encyclopedia of Food Microbiology. Elsevier, pp. 1647-1655.
Riddell, R., 1950. Permanent Stained Mycological Preparations Obtained by Slide Culture. Mycologia, 42(2), p.265.
Risberg, M., Westerlund, L., 2020. Experimental investigation of a crawl space located in a subarctic climate. Results in Engineering, 7, p.100158.
Salo, J., Huttunen, P., Vinha, J., Keskikuru, T., 2018. Numerical study of time-dependent hygrothermal conditions in depressurized crawl space. Building Simulation, 11(6), p.1067.
Sedlbauer, K., 2002. Prediction of Mould Growth by Hygrothermal Calculation. Journal of building
physics, 25(4), pp.321-336.
Viitanen, H., Vinha, J., Salminen, K., Ojanen, T., Peuhkuri, R., Paajanen, L., Lähdesmäki, K., 2010. Moisture and Bio-deterioration Risk of Building Materials and Structures. Journal of building physics, 33(3), pp.201-224.
Werther, N., Winter, S., 2009. Klimatische Verhältnisse in Kriechkellern unter gedämmten Holzbodenplatten. Bauphysik, 31(2), pp.59-64.
Yates, M., Nakatsu, C.H., Miller, R.V., Pillai, S.D., 2016. Manual of Environmental Microbiology (4th Edition) 4 ed., Washington, DC: American Society for Microbiology (ASM).
Zabel, R., Morrell, J., 2020. The characteristics and classification of fungi and bacteria. Wood Microbiology. United States: Elsevier Science & Technology.
ACKNOWLEDGMENT
ThepaperwassupportedbytheBrnoUniversityofTechnology,FacultyofCivilEngineering -Junior Specific Research No. FAST-J-23-8251 - Foundation of wooden buildings by crawl space system: continuation of microclimate analysis. Thanks for the cooperation to Mendel University in Brno and Masaryk University in Brno.
AUTHORS’ ADDRESSES
Ing. Slávka Pobucká
Faculty of Civil Engineering, Brno University of Technology Veveří 331/95 602 00 Brno, Czech Republic Slavka.Pobucka1@vutbr.cz
doc. Ing. Libor Kalhotka, Ph.D.
Department of Food Technology, Faculty of AgriSciences, Mendel University in Brno Zemědělská 1665/1, 613 00 Brno, Czech Republic libor.kalhotka@mendelu.cz
Ing. Monika Laichmanová, Ph.D.
Department of Experimental Biology, Czech Collection of Microorganisms, Faculty of Science, Masaryk University, Kamenice 5, 625 00 Brno, Czech Republic monikadr@sci.muni.cz
doc. Ing. Karel Šuhajda, Ph.D.
Faculty of Civil Engineering, Brno University of Technology Veveří 331/95, 602 00 Brno, Czech Republic suhajda.k@fce.vutbr.cz
ACTA FACULTATIS XYLOLOGIAE ZVOLEN, 66(1): 75 89, 2024
Zvolen, Technická univerzita vo Zvolene
DOI: 10.17423/afx.2024.66.1.06
INFLUENCE OF MOISTURE CONTENT OF MHM SOLID WOOD WALL CONSTRUCTION MATERIALS ON THERMAL CONDUCTIVITY
Patrik Štompf – Jaroslava Štefková
ABSTRACT
The moisture content of materials in building structures is a factor that affects the amount of heatlossesthroughthebuildingenvelope.Inthecontextofthecurrentdemandsforincreased thermal protection, the moisture content of materials becomes an important indicator of thermal and technical properties. The paper is devoted to the theoretical and experimental analyses of the moisture condition of the construction materials of panel exterior walls made from solid MHM (Massiv-Holz-Mauer) panels. The theoretical analyses of the moisture status of materials through the WUFI 2D simulation program were supplemented by experimental measurements of moisture in built-in structures. The measurements took place in a research building simulating the creation of residential climate conditions. The research quantified the influence of the operating moisture status of MHM and blown thermal insulations (wood fibres and disintegrated straw) on their thermal conductivity. The research results show that the moisture content of MHM panels influences their thermal conductivity in natural conditions. However, in the case of wood-fibre insulation, no significant influence ofmoisturestatus onthecoefficientofthermalconductivity was demonstrated.Themoisture content of disintegrated straw indicates that in natural conditions, it acquires 46% higher thermal conductivity values than the ones declared by the manufacturer.
Keywords: moisture status of materials; thermal conductivity; MHM solid-wood panels; wood-fibre insulation; straw insulation
INTRODUCTION
The thermal, hygroscopic, and moisture properties of timber constructions within the current trends in building construction represent an important factor related to the amount of heat losses through transition and the overall operational consumption of energy for heating.
In addition to thetypeoftimberstructure,its designplaysasignificant role.Thedesign is strongly affected by the load-bearing system and the type of construction depending on which structure of the building envelope and the material composition are chosen. The chosen materials affect the thermal and moisture properties of the structure. Due to the significant portion of wooden structural elements and various wood-based materials in timber structures, the assessment of energy efficiency and heat losses of timber structures depends on the thermal and hygroscopic properties of these materials.
The thermal conductivity of construction materials strongly depends on the moisture content and density of the given construction materials (Asdrubali et al., 2016). The results
of the research conducted by Wang et al. (2019) point to the influence of moisture on the thermal conductivity of construction materials. Research into the basic thermophysical properties of spruce wood and wood composites under normal conditions was carried out by Regináč and Babiak (1977), Krišťák et al. (2019) and Božiková et al. (2021). Hrčka (2010) conducted research dealing with thermal properties of beech wood depending on humidity and density. The influence of moisture content in standard conditions was investigated when the moisture content of materials was around 12%.
Natural wood-base insulation materials have interesting moisture properties because of their high moisture capacity. Geving and Holme (2012), Geving et al. (2015), and Bunkholt et al. (2021) investigated the moisture properties of wooden panel constructions with wood-fibre thermal insulations. The results from the research of Geving et al. (2015) show that wall compositions with wood-fibre insulation behave similarly to those using mineral wool concerning relative humidity values on the outside of the structure. Laboratory tests have shown that wood-fibre insulation has interesting physical properties related to moisture absorption and transport. According to the study by Volf et al. (2015), natural-based insulation materials absorb more atmospheric humidity into their structure than, for example, mineral wool, which is due to their more complex organic structure.
With the growing interest in sustainable buildings that can reduce energy consumption and environmental impacts, the variability of straw-based constructions and their moisture properties are increasingly being investigated. Concerns about using straw in structures are mainly caused by the susceptibility of straw to the development of rot after being incorporated into the structure. Research conducted by Robinson et al. (2017), Carfrae (2009), and Cascone et al. (2018) dealt with assessing the influence of atmospheric conditions on the resulting moisture content of straw bales. Using straw as an insulating material in the construction of building envelopes significantly impacts the overall operational energy consumption in addition to an indisputably lower environmental burden. According to research by Volf et al. (2015), the heat transfer coefficient of straw compared to other natural-based insulating materials is the highest. However, the volumetric heat capacity of natural insulations and mineral wool is higher by 11% and 78%, respectively.
Based on the research, the values on the thermal conductivity of straw show a wider range than those of mineral insulations. This variability is due to the structure, type of straw insulation, moisture content, density, size, and air voids within the insulation and fibre orientation (Cascone et al. 2019).
Research conducted by Platt et al. (2022) points to different values of thermal conductivity of straw insulation also depending on the regulated orientation of the stalks –parallel and perpendicular to the heat flow. The use of straw processed by new production processes (chopping, drying, sorting, and cleaning) and a new method of its application in buildings – blowing, represents an area that has not been explored in practice so far from the point of view of its thermal and moisture behaviour in natural conditions.
The aim of the paper is to determine the effect of the moisture content of built-in construction materials of panel walls based on wood – solid MHMpanels and blown thermal insulations (wood fibres STEICO zell and disintegrated straw TEPORE) on their thermal conductivity coefficient The research was conducted by comparing the simulation in the WUFI 2D program and experimental measurements of the moisture status.
MATERIALS AND METHODS
A representative structural composition of an exterior panel wall made of wooden panels was designed to investigate thermal and moisture properties. The load-bearing structure consists of solid wood nail-laminated MHM panels. The thermal insulation envelope comprises lightweight ladder beams (LLB) (Fig. 1), which hold the insulation material and external siding. MHM panels are similar to CLT panels. In these cross-layered solid-wood parts, aluminium nails ensure the connection of the individual layers without using glue. The investigated structural compositions contain nature-based blown insulation materials that are not yet standard for this type of supporting system. To investigate moisture properties, two variants of structure composition with two types of thermal insulations were created: wood fibres STEICO zell (Fig. 2a) and disintegrated straw TEPORE (Fig 2b).



The basic physical parameters of the investigated insulation materials which we used as a basis for the research are listed in
Tab. 1 Physical parameters of investigated insulating materials – wood fibres and disintegrated straw
Coefficient of thermal conductivity λ [W/(m.K)]
S.n. Material
capacity c [J/(kg·K)] Diffusion resistance coefficient [1] proposal declared
Comments:
(1) Application density of insulating material – application by blowing. All technical parameters listed in the table are available in the technical data sheets of the manufacturers.
The composition of the installed fragments of the structures is shown in Fig. 3 (a description of the composition is below Fig. 3).

Fig. 3 Composition of exterior wall constructions from MHM and lightweight ladder beams.
Composition of the exterior wall constructions MHM_VN: (according to Fig. 3)
1. Plasterboard – GKF
2. Solid-wood nailed structural elements – MHM (5 layers)
3. Lightweight ladder beam 6283 + natural-based blown thermal insulation (wood-fibre insulation STEICO zell or disintegrated straw TEPORE)
4. Wood-fibre facade thermal insulation
mm
mm
5. Adhesive mortar for wood-fibre insulation + reinforcing mesh 3 mm
6. Mineral facade plaster 3 mm
The assessed structural compositions were a direct part of the exterior walls on the south side of the research structure, simulating the standard climate of residential structures (Fig. 4).
MHM system
Placement of research samples

Fig. 4 Prototype research structure use of different load-bearing systems based on wood.
Control holes were made in the built-in constructions (one control hole for each type of structure), which were used for the installation of sensors and insertion of material samples for determining the moisture content. Polyvinylchloride (PVC) pipes with a diameter of 120 mm and length of 280 mm were embedded in the places of control holes in the area of thermal insulation. These were used to store net bags with blown thermal insulation materials and separate them from the surrounding insulation. The holes were also used to install sensors for measuring temperature and relative humidity developments Thermal insulation was divided into three equally thick parts (93 mm thick), creating three separate samples for further research of the thermal insulation moisture properties.
Sensors and measuring technology
To determine temperature development on the structure's outer and inner surfaces, separate thermocouple sensors θx were placed in the fragments (NiCr-Ni thermocouple sensors with range of -10 to +105 °C from AHLBORN company)
Digital sensors from AHLBORN company θb, x (Tb, x) were used to measure temperature, relative humidity, and air pressures. An exterior digital sensor from AHLBORN company with a protective cover was used to measure exterior climate parameters.
The measuring sensors were built into the constructions of the southern exterior wall of the research structure through control holes (Fig. 5). Measurements were recorded at hourly intervals throughout the research. The data were recorded using the ALMEMO measuring centre.

Temperatures and relative humidity of the air outdoors, indoors, and inside the fragments of walls were measured by the mentioned measuring devices.
Disposition of sensors
Fig. 6 shows a cross-section within fragments of the investigated structures with a schematic representation of the location of the sensors in the individual structural layers.

6 Built-in sensors (θx, Tb, x) for measuring temperature and relative humidity in the structures.
Indoor environment parameters were maintained in the research structure by the air temperature adjustment unit and a separate humidification system during the research. The values of the moisture state of the investigated construction materials in the fragments were determined by the gravimetric method which is precisely described in STN EN 322. The samples of the construction materials were weighed on laboratory scales (RADWAG PS 3500.R2.M) at weekly intervals during the entire period. The mass measurements were made with an accuracy of 0.01 g. The drying process of samples to an oven-drystatewasperformedinthelaboratorykilnat103±2 °C. Thesampleswereweighed until reaching the steady state, when a mass difference lower than 0.1% was reached after three successive weights in 24 h, the equilibrium was considered to be reached
The influence of the actual moisture status of construction materials on their thermal conductivity was assessed by an analysis with the WUFI 2D program The calculation program has an extensive library of materials within which the dependence of thermal conductivity λ on the moisture content of materials is assigned. The calculation program also considers the sorption properties of materials and the possible redistribution of moisture into their structure. The influence of the actual moisture status of materials on the change in the coefficient of thermal conductivity was assessed in pursuance of the data from experimental measurements.
RESULTS AND DISCUSSION
Fig. 7 shows the relative humidity and air temperature trends in the research structure during the entire period of the measurements. The values were measured by a digital sensor Tb, x placed in the interior of research structure The values of relative humidity fluctuated in the range from 22.8% to 61.10% (average value was 36.9%). The average indoor air temperature during the measured period was 20 91°C.
Measured values Measurement period
Fig. 7 Interior temperature and relative air humidity in the research structure during the whole period of measurements.
The development of temperature and relative humidity in the exterior during the research period is shown in Fig. 8. The values were measured by digital sensor Tb, x designed for exterior use.

Fig. 8 Exterior temperature and relative air humidity during the whole period of measurements.
According to the measured data (Fig. 8), the average outdoor relative humidity was at the level of 87 16%, which reached its maximum of 100% several times in the period from December 2022 to January 2023. The lowest measured outdoor temperature was -16.73°C (2/7/2023 at 8:00 a.m.).
Fig. 9 shows the development of the moisture content of solid-wood MHM panels in the research fragments. The moisture content of the MHM samples was determined by the gravimetric method.
Moisture content [%]
Measured period
Fig. 10 represents the dependence of thermal conductivity (λ) on the moisture content of soft coniferous structural wood referring to bound water according to the available data from the WUFI 2D program. The graph does not include free water in the material. Under standard conditions, the moisture content of the built-in MHM samples in the structure does not exceed 12% which excludes any presence of free water during its use
Thermal conductivity [W/m.K]
softwood (coniferous): spruce/ fir (ρ = 400 kg/m3)
Moisture content of material [%]
Fig. 10 Dependence of thermal conductivity (λ) on moisture content (w) of soft coniferous wood –spruce/ fir (WUFI 2D).
The data in Fig. 9 show that the moisture content of solid-wood MHM samples ranged from 8.81% to 11.93%. The results of WUFI 2D program show that the values of relative humidity ranged from 9.50-10.60%. The coefficient of thermal conductivity for calculations of thermal properties was considered at the level of λ = 0 13 W/(m.K) according to STN EN ISO 10456. Based on the dependence of thermal conductivity on the moisture content of soft coniferous wood (Fig. 10), the moisture content for this value is 33 25%. the measured data show that the moisture content of the MHM samples was at a significantly lower level, and the calculated value of the thermal conductivity coefficient is overestimated in favour of the safety of its use. The coefficient of thermal conductivity could be considered at the level of λ = 0.105 W/(m.K), which corresponds to a moisture content of material approximately 12% below which the measured humidity values ranged. The heat flow through the MHM samples in the exterior wall was in the perpendicular direction (predominantly in the tangential direction of plates).
Theoretical calculations are based on the standards (STN 73 0540 and STN EN ISO 10456) for the soft coniferous wood (spruce/fir), which state a higher coefficient of thermal conductivity lambda in favour of safety for theoretical calculations of thermal properties. According to the measured data and a theoretical comparison, it is clear that the thermal conductivity of MHM panels in perpendicular direction ranged from λ = 0.102-0.105 W/(m.K). This corresponds to the value declared by the manufacturer for λ = 0 11 W/(m.K). These data indicate that the theoretical design value of thermal conductivity for calculations of thermal-technical properties of walls according to STN EN ISO 10456 is significantly in favour of safety, and it could be reduced by an average of 20 4% assuming an optimal moisture condition, which in the construction occurs without design and structural defects. The experimental measurements made by Kotoulek et al. (2018) show that the thermal conductivity of soft coniferous wood samples perpendicular to the fibres is in the range of λ = 0.103 - 0.108 W/(m.K) (depending on the direction). Tab. 2 shows the results from the research of Kotoulek et al. (2018)
Tab. 2 Thermal conductivity of soft coniferous wood at a laboratory temperature of 20°C (adapted from Kotoulek et al. 2018)
Samples/ direction of fibres
The results of the research conducted by Flity et al. (2024) state that the thermal conductivity of spruce perpendicular to the fibres at equilibrium moisture content and y = 0 0012x + 0 09
Coefficient of thermal conductivity –λ [W/(m.K)]. Arithmetic mean. Relative deviation [%]
temperature of 20 °C ranges from λ = 0 111-0 114 ± 0 06 W/(m.K). The authors demonstrated the dependence of thermal conductivity on the density of material which meansthatthermalconductivityisalsoaffectedbytheoccurrenceofdefects inwood–knots, cracks.
As part of further research, the thermal conductivity could be adjusted based on the density of the material in addition to the moisture.
Fig. 11 shows the moisture course of three parts of blown wood-fibre thermal insulation (STEICO zell). The moisture content of the STEICO zell samples was determined by the gravimetric method. Fig. 12 represents the dependence of thermal conductivity (λ) on moisture content for STEICO zell taken from the WUFI 2D program
Moisture content [%]
Measured period
Fig. 11 The course of moisture content of three parts of blown thermal insulation STEICO zell (MHM_VN DV).
Thermal conductivity [W/m.K]
Wood-fibre thermal insulation - STEICO zell
y = 1E-05x + 0.04
Moisture content of material [%]
Fig. 12 Dependence of thermal conductivity (λ) on moisture content (w) of STEICO zell (WUFI 2D).
The moisture content of STEICO zell ranged from 6 45% to 10 13% (Fig. 11). The insulation acquires the highest moisture content in the layers on the exterior side and the lowest on the interior side. The expected moisture content of the STEICO zell according to the WUFI 2D program was in the range: 4 40-6 00% on the interior side; 4 30-5 95% in the middlesection; and 4.20-5.98%ontheexteriorsideofthestructure. Thedifferences between the exterior and interior sides and theoretical simulation and real values are caused by the convection of moist air from the exterior into the structure.
The results from the experimental measurements of the moisture content of STEICO zell (Fig.11) show that the moisture content in actual conditions did not exceed a level that would affect the design thermal conductivity of the material (declared by the manufacturer).
According to the data in Fig. 12, the coefficient of thermal conductivity, depending on the moisture content, almost does not change The influence of moisture content is minimal in thisrange.Accordingtotheavailabledata,thethermalconductivity λ wouldchangeby0.001 W/(m.K) up to 103% moisture content. This value represents an amount of water of approximately 41 2 kg/m3 of material at an average density of 40 kg/m3 blown insulation In actual conditions, a moisture content that would significantly affect the thermal conductivity of the STEICO zell was not reached In the study of Gullbrekkena et al. (2019), the coefficient of thermal conductivity of wood-fibre insulation deteriorated in the complete moisture saturation by only 0.001 W/(m.K) compared to the original value. The research demonstrated that the thermal conductivity is not affected by moisture content on the hygroscopic area of this material.
The course of the moisture content of TEPORE disintegrated straw insulation is illustrated in Fig. 13 The moisture content of the disintegrated straw TEPORE samples was determined by the gravimetric method. Fig. 14 represents the dependence of thermal conductivity (λ) on moisture content for straw thermal insulation according to the WUFI 2D program.
Thermal conductivity [W/m.K]
Straw thermal insulation
y = 0.0022x + 0.057
Moisture content of material [%]
14 Dependence of thermal conductivity (λ) on moisture content (w) of straw thermal insulation (WUFI 2D).
According to the data in Fig. 13, the moisture content of straw thermal insulation ranges from 6.58% to 10.09%. The moisture content is higher on the exterior side of the thermal insulation layer and decreases towards the interior. The expected moisture content of the straw thermal insulation TEPORE according to the theoretical simulation in the WUFI 2D program was in the range: 4 85-6 05% on the interior side; 4 80-6 05 % in the middle section; and 4.70-6.00% on the exterior side of the structure. The differences between
theoretical simulation and measured values are caused by the convection of moist air from the exterior into the structure in real conditions
The coefficient of thermal conductivity of the material changes significantly even at lower moisture values. According to the measured data (Fig. 14), the thermal conductivity coefficient is λ = 0 0698 – 0 0828 W/(m.K) at 6-12% moisture content These facts indicate that the calculated value of the coefficient of thermal conductivity λ = 0.055 W/(m.K) (mentioned by the manufacturer's technical datasheet) is not correct and should be increased to the level of at least λ = 0.083 W/(m.K). This coefficient would correspond to the highest measured moisture content in the straw thermal insulation layer. The coefficient of thermal conductivity declared by a manufacturer should be increased by at least 46% when calculating the influence of moisture content up to 12%.
The available data from research on the thermal conductivity of straw mention a broader range than, for example, mineral thermal insulation. The variability in properties is caused by the structure and type of straw insulation, moisture content, density, size, and the number of air voids within the insulation material and fibre orientation (Cascone et al , 2019).Therefore,accordingtoCascone et al.(2019),inthethermal andtechnicalassessment of structures using straw insulations, it is difficult to identify suitable values that would subsequently be used for simulation programs in the calculation of the thermal and moisture behaviour of structures. In the study, the authors demonstrated that the thermal conductivity of dry straw or straw bales is at the level of λ = 0 0573 W/(m.K) in perpendicular direction According to their study, for the calculation of thermal technical properties, the value should be increased by at least 20% to λ = 0.07 W/(m.K). In the research of Teslík (2016), the average (declared) value of thermal conductivity of disintegrated straw was determined by experimental tests at λ = 0.053 W/(m.K) at density of 90-110 kg/m3 . Teslík (2016), however, did not monitor the influence of moisture content on thermal conductivity. Tab. 3 presents data about the thermal conductivity and density of straw in different forms.
Tab. 3 Thermal conductivity λ and density ρ of straw bales by different authors (adapted from Cascone et al. 2019).
Authors
Based on the data from Tab. 3, we can state that the coefficient of thermal conductivity of straw, whether in the form of compact straw bales or disintegrated particles, acquires a wide range of values due to various factors as we have already mentioned. According to the results from our research, we can say the coefficient of thermal conductivity of disintegrated straw λ = 0.0698-0.0828 W/(m.K) at the material moisture 6-12% is within the range and corresponds with the results of studies by mentioned authors in Tab. 3.
CONCLUSION
The paper deals with theoretical and experimental research focusing on the moisture status of construction materials of exterior panel walls from MHM solid-wood and lightweight ladder beams using natural-blown thermal insulations. The research quantified the influence of standard moisture content on the thermal conductivity of the supporting structure and the main insulating materials in operating conditions This effect was insignificant in the case of wood-fibre insulation STEICO zell. However, even the lower operational moisture content of disintegrated straw insulation TEPORE inside the structure significantly affects its thermal conductivity.
Provided the envelope structures are correctly implemented, the moisture level of blown wood-fibre insulation STEICO zell does not significantly affect its thermal conductivity. The material would have to reach up to 103% moisture content, should the coefficient of thermal conductivity change by 0 001 W/(m.K).
The results from the research of disintegrated straw insulation TEPORE showed that the manufacturer-declared value of the coefficient of thermal conductivity λ was significantly influenced by the moisture range w = 6-12%. According to the results, the coefficient of thermal conductivity should be increased by at least 46% (from 0.057 to 0.083 W/(m.K)) for this type of insulation. An increase in the coefficient of thermal conductivity degrades the heat transfer and increases the heat loss through building envelope. The results should be considered when calculating the thermal properties of peripheral constructions of buildings (such as exterior walls) using an increased coefficient of thermal conductivity λ
Theresearch on themoisturestatus ofwood-based materials has shownthat theirusual value of thermal conductivity according to STN EN ISO 10456 and STN 73 0540 is highly overestimated. In real atmospheric conditions within the exterior walls, the moisture status of wood-based materials (MHM) reached lower values than the data in STN EN ISO 10456 and STN 73 0540, by 20.4% and 57.5%, respectively The value of the coefficient of thermal conductivity forMHMpanels, whichwas determined,also corresponds to thevaluedeclared by the manufacturer (λ = 0.11 W/(m.K)).
The comparison of theoretical and experimental results of the moisture content in thermal insulations STEICO zell and disintegrated straw TEPORE in the WUFI 2D program showed significant differences between the theoretical simulations and real results from the measurements of the built-in materials in the structure.
REFERENCES
Asdrubali, F., Ferracuti, B., Lombardi,L., Guattari, C., Evangelisti, L., Grazieschi, G., 2016. A review of structural, thermo-physical, acoustical, and environmental properties of wooden materials for building applications. Building and Environment, 114. ELSEVIER Ltd. p. 317319. https://doi.org/10.1016/j.buildenv.2016.12.033
Božiková, M., Kotoulek, P., Bilčík, M., Kubík, Ľ., Hlaváčová, Z., Hlaváč, P., 2021. Thermal properties of wood and wood composites made from wood waste. International Agrophysics, 35(3). p. 251-256. https://doi.org/10.31545/intagr/142472
Bunkholt, S., N., Ruther, P., Gullbrekken, L., Geving, S., 2021. Effect of forced convection on the hygrothermal performance of a wood frame wall with wood fibre insulation. Building and Environment, 195. 107748. ELSEVIER Ltd. https://doi.org/10.1016/j.buildenv.2021.107748
Carfrae, J., 2009. Long-term evaluation of the performance of a straw bale house built in a temperate maritime climate. Doctoral research workshop – Sustainability in the Built Environment November 16, 2009, University of Plymouth, UK.
Cascone, S., Evola, G., Gagliano, A., Sciuto, G., Baroetto Parisi, CH., 2019. Laboratory and in-situ measurements for thermal and acoustic performance of straw bales. Sustainability 11, 5592. https://doi.org/10.3390/su11205592
Cascone, S., Catania, F., Gagliano, A., Sciuto, G., 2018. Energy performance and environmental and economic assessment of the platform frame system with compressed straw. Energy Build. 166, 83–92. https://doi.org/10.1016/j.enbuild.2018.01.035
Flity, H., Jannot, Y., Terrei, L., Lardet, P., Schick, V., Acem, Z., Parent G., 2024. Thermal conductivity parallel and perpendicular to fibres direction and heat capacity measurements of eight wood species up to 160 °C. In. international Journal of Thermal Sciences 195. https://doi.org/10.1016/j.ijthermalsci.2023.108661
Gallegos-Ortega, R., Magaña-Guzmán, T., Reyes-López, J.A., Romero-Hernández, M. S., 2017. Thermal behaviour of a straw bale building from data obtained in situ. A case in Northwestern México. Build. Environ. p.124, 336–341. https://doi.org/10.1016/j.buildenv.2017.08.015
Geving, S., Holme, J., 2012. Vapour retarders in wood frame walls and their effect on the drying capability. In. Frontiers of Architectural Research, 2 (1). s. 42-49. https://doi.org/10.1016/j.foar.2012.12.003
Geving, S., Lunde, E., Holme, J., 2015. Laboratory investigations of moisture conditions in wood frame walls with wood-fibre insulations. 6th International Building Physics Conference, IBPC 2015. Energy Procedia, 78. ELEVIER Ltd. p. 1455-1460. https://doi.org/10.1016/j.egypro.2015.11.170
Goodhew, S., Griffiths, R., 2005. Sustainable earth walls to meet the building regulations. Energy Build. 37, p. 451–459. https://doi.org/10.1016/j.enbuild.2004.08.005
Gullbrekken, L., Grynning,S., Gaarder, E., J., 2019. Thermal performance ofinsulated constructions – experimental studies. Buildings, 9 (2). https://doi.org/10.3390/buildings9020049
Hrčka, R., 2010. Variation of thermal properties of beech wood in the radial direction with moisture content and density. Proceedings of the 6th IUFRO Symposium “Wood structure and Properties ´10” held on September 6-9, 2010 in Podbanské, High Tatras, Slovakia and organized jointly by the Faculty of Wood sciences and Technology of the Technical University in Zvolen and the IUFRO Research Groups 5.01. “Wood Quality”. Arbora Publishers, Zvolen, Slovakia. ISBN: 978-80-968868-5-2
Kotoulek, P., Malínek, M., Božiková, M., Hlaváč, P., Bilčík, M., Hlaváčová, Z., Scilag, J., 2018. Basic thermal properties and geometric characteristics of wood and oriented strand board used in low-energy buildings. Journal of Processing and Energy in Agriculture, 22 (2). p. 73 – 75. ISSN:1821-4487
Krišťák, Ľ., Igaz, R., Ružiak, I. 2019. Applying the EDPS Method to the Research into Thermophysical Properties of Solid Wood of Coniferous Trees. Advances in Materials Science and Engineering, vol. 2019. https://doi.org/10.1155/2019/2303720
Platt, L. S., Maskell, D., Shea, A., Walker, P., 2022. Impact of fibre orientation on the hygrothermal properties of straw bale insulation. Construction and building materials 349. ELSEVIER Ltd. https://doi.org/10.1016/j.conbuildmat.2022.128752
Regináč, L., Babiak, M., 1977. Základné tepelnofyzikálne charakteristiky smrekového dreva pri normálnych podmienkach [Basic thermal physical characteristics of spruce wood under normal conditions]. Drevársky výskum, Ročník XXII. Zväzok 3. pp. 165–183.
Robinson, J., Klalib Aoun, H., Davison, M., 2017. Determining moisture levels in straw bale construction. Procedia Engineering, 171. p. 1526-1534. ELSEVIER Ltd. https://doi.org/10.1016/j.proeng.2017.01.390
Shea, A., Wall, K., Walker, P., 2013. Evaluation of the thermal performance of an innovative prefabricated natural plant fibre building system. Build. Serv. Eng. Res. Technol. 34, p. 369–380. https://doi.org/10.1177/0143624412450023
STN 73 0540-2 + Z1 + Z2: 2019 Tepelnotechnické vlastnosti stavebných konštrukcií a budov. Tepelnáochranabudov.Časť2:Funkčnépožiadavky[Thermaltechnicalpropertiesofstructures and buildings. Thermal protection of buildings. Part 2: Requirements].
STN EN 322 Dosky z dreva. Zisťovanie vlhkosti [Wood-based panels. Determination of moisture content].
STN EN ISO 10456 Stavebné materiály a výrobky. Tepelno-vlhkostné vlastnosti. Tabuľkové návrhové (výpočtové) hodnoty a postupy na stanovenie deklarovaných a návrhových hodnôt tepelnotechnických veličín [Building materials and products. Hygrothermal properties. Tabulated design values and procedures for determining declared and design thermal values].
Štompf, P., Jochim, S., Uhrín R., 2022. Prototypový výskumný object Katedry drevených stavieb Technickej university vo Zvolene. Nové trendy akustického spektra: vedecký recenzovaný zborník[Prototyperesearchobject oftheDepartment ofWooden Constructions oftheTechnical University in Zvolen. New Trends of Acoustic Spectrum: a peer-reviewed proceedings] p. 103123. ISBN: 978-80-228-3325-7.
Štompf, P., 2023. Identifikácia a analýza vybraných parametrov drevených stavebných konštrukcií z hľadiska spotreby energie: Dizertačná práca. [Identification and analysis of selected parameters of timber structures in terms of energy consumption: Dissertation]. Zvolen: Technical University in Zvolen. Faculty of Wood Sciences and Technology, Department of Wooden Constructions. p. 48-93
Teslík, J., 2016. Výzkum vlastností drcené slámy využitelné ve stavebnictví. Disertační práce. Ostrava: Vysoká škola báňská – Technická univerzita Ostrava. Stavební fakulta [Research on the properties of crushed straw usable in the construction industry. Dissertation.] p. 92
Volf,M.,Diviš,J.,Havlík,F.,2015.Thermal,moistureandbiological behaviourofnaturalinsulating materials. Energy Procedia, 78. p. 1599-1604. Elsevier Ltd. https://doi.org/10.1016/j.egypro.2015.11.219
Wang,Y., Zhao, Z., Liu, Y., Wang, D., Ma, CH., Liu, J., 2019. Comprehensive correction of thermal conductivity of moist porous building materials with static moisture distribution and moisture transfer. Energy. Elsevier Ltd. p. 103-118. https://doi.org/10.1016/j.energy.2019.03.178
Zhang, J., Wang, J., Guo, S., Wei, B., He, X., Sun, J., Shu, S., 2017. Study on heat transfer characteristics of straw panel wall in solar greenhouse. Energy Build. 139, p. 91–100. https://doi.org/10.1016/j.enbuild.2016.12.061
ACKNOWLEDGMENT
This experimental research was prepared within the grant project: APVV-17-0206 ""Ultra-LowEnergy Green Buildings Based on Renewable Raw Wood Material," conducted by the authors and the considerable support of the APVV agency.
AUTHORS' ADDRESSES
Ing. Patrik Štompf, PhD. Department of Wooden Constructions Technical University in Zvolen
T. G. Masaryka 24
960 01 Zvolen
Slovak Republic xstompf@tuzvo.sk
Mgr. Jaroslava Štefková, PhD. Institute of Foreign Languages Technical University in Zvolen
T. G. Masaryka 24
960 01 Zvolen Slovak Republic stefkova@tuzvo.sk
ACTA FACULTATIS XYLOLOGIAE ZVOLEN, 66(1): 91 103, 2024
Zvolen, Technická univerzita vo Zvolene
DOI: 10.17423/afx.2024.66.1.07
NUMERICAL SIMULATION OF DYNAMIC MOISTURE SPREAD IN COMPACT FLAT ROOFS
Martin Haladej
ABSTRACT
The contribution is focused on the numerical verification of the correct design of compact flat wooden roofs in the external boundary conditions of Central Europe (Vienna –Bratislava); the internal boundary conditions of the analysis met the requirements for human habitation. Using the WUFI 2D software, the compositions of compact flat roofs were analyzed using a vapor barrier and a variable vapor retarder with a low dispersion of diffusion thickness values and a variable vapor retarder with a high dispersion of diffusion thickness values. Each of these three compositions was assessed in versions without shading and with shading of the surface (by graveling the roof covering from the exterior side). The length of the analyzed period was 5 years. The main goal was to verify the accumulation of moisture in layers of the structure and whether critical moisture conditions suitable for the formation of molds and fungi causing rot will be reached in any of the compositions. The measurement results showed the different functioning of compact flat wooden roofs depending on the shading, as well as other conclusions for the design and realization of the composition of compact flat wooden roofs.
Keywords: dynamic evaluation; compact flat roof; moisture content; WUFI 2D software
INTRODUCTION
Whendesigning compact flat woodenroofswith a classicorderof layersof overheated spaces, it is essential to design roof construction in such a way as to prevent excessive transport of moisture from the interior to the roof structure and to prevent moisture accumulation in theroof structure.Theinfluenceofhumidityandtemperatureonthethermal conductivity of building materials was investigated by Wang et al. (2022). Björk and Enochsson (2009) investigated the change in the properties of thermal insulation materials due to changes in the environment; the work published by Kontoleon and Giarma (2016) verified the Dynamic thermal response of layers of building materials in terms of their moisture. The effect of the vapor barrier in an airtight compact flat roof was investigated by Nusser et al. (2010). Langerock et al. (2017) investigated the limited drying potential of a compact flat roof with in-situ measurements and its sensitivity to moisture penetration and verified the real impact of smart vapor barriers and the color of the waterproofing membrane on the hydrothermal properties of the structure under the conditions of the Belgian climate and exterior boundary conditions. The effect of an unventilated air cavity on the cold side of the insulation in unshielded wooden compact flat roofs was verified by Bachinger et al. (2016). The susceptibility of wood and wood-based building materials to attack by molds
and wood-destroying fungi causing rot was verified by Vidholdova et al. (2016). Suitable conditions for the formation of molds and fungi on wood and wood-based materials were investigated by Viitanen and Ritschkoff (1991), Wang and Morris (2010) and Alev and Kalamees (2016).
InthecurrentlyvalidSlovakandEuropeantechnicalstandardsSTN730540-2+Z1+Z2 and EN322, the moisture spread is most often evaluated according to a simplified graphic method – Glaser's method (Glaser, 1959). The method describes the spread of moisture through the structure only as the spread of water vapor through the structure depending on one material characteristic, diffusion resistance factor μ [-]. The spread of moisture in the structure depending on only one material characteristic of the built-in materials is reasonable only if we consider the spread of moisture only as the spread of water vapor through the structure and if the boundary conditions (partial pressures of water vapor on the interior and exterior sides of the structure) are constant. In fact, the spread of moisture is affected by variable boundary conditions, and therefore, moisture accumulation also occurs in constructions. The amount of accumulated moisture is described by a curve called equilibrium moisture or sorption isotherm (Mrlik, 1985). In porous materials, which are the majority of building materials (wood, concrete, various of thermal insulation), liquid moisture also spreads due to capillary forces (Krus, 1996). The variable temperature and relative humidity of the exterior and interior air are not the only factors affecting the spread of moisture in structures. This spread of moisture is influenced by e.g., also precipitation that falls on the outer surface of the structure, but also the influence of solar and long-wave radiation.
Since the 1950s, several physical models of the mutual propagation of heat and moisture in porous materials have appeared worldwide. Hill (2003) compared 45 different calculation programs predicting the spread of heat and moisture through construction structures to select suitable calculation programs that can be used in the design of structures from the point of view of moisture spread. Two computational numerical models, MATCH and WUFI, were recommended to assess of the spread of moisture and heat through packaging structures. WUFI software (Warme und Feuchte instationär) – dynamic evaluation method was created based on the dissertation by Künzel (1995) and is based on the following system of differential equations.
Where: dH/dT heat accumulation in wet materials [J/(m3 K)],
dw/d�� moisture accumulation in materials [kg/m3],
λ coefficient of thermal conductivity of wet material [W/(m K)],
���� moisture capillary transport coeafficient [kg/(m·s)],
���� coefficient of diffusion permeability of the material [kg/(m·s·Pa)],
ℎ�� specific heat of the group [J/kg],
�������� partial pressure of saturated water vapour [Pa],
�� temperature [K],
�� relative humidity [%].
Temperature and relative humidity re the unknowns in the aforementioned Künzel system of differential equations. Individual equations (1) and (2) are interconnected, i.e., the partial pressure of water vapor depends on the instantaneous temperature across the
structure, the coefficient of thermal conductivity depends on the current moisture content of the material, and the thermal mass depends on the amount of moisture present across the structure. Künzel's numerical model provides the possibility to more accurately model transport phenomena (heat, moisture, energy) and, in contrast to the stationary standard calculation procedures specified in the set of technical standards STN 73 0540, allows for the modeling of heat and moisture propagation through the structure to include physical phenomena in the calculation as a dynamic simulation of heat propagation and moisture in the building structure with any time step, rotation of the structure with respect to the cardinal pointsandwithrespectto thehorizontalplane,theinfluenceofsolarandlong-waveradiation on the spread of heat and moisture in the structure, the influence of the color of the outer surface of the building structure on the spread of heat, accumulation of heat and moisture in individual layers structures, the dependence of the coefficient of thermal conductivity of the material on the amount of moisture in the materials, the dependence of the value of the diffusion resistance factor on the amount of moisture in the materials, the spread of liquid moisture in porous materials, the absorption of driven rain on the outer surface of the building structure. Among the most significant influences that Künzel's model does not include are hysteresis (accumulation of moisture depending on time), airflow through the structure, the salinity of the environment or the effect of snow cover.
From the above information, it follows that the procedures according to the mentioned currently valid technical standards for thermal and moisture assessment of building structures are simplified and do not correspond to the latest knowledge from the world of building physics and can thus lead to distorted conclusions. The aim of the theoretical analysis of the dynamic spread of moisture in compact flat roof constructions is to apply a more accurate method for evaluating the spread of moisture in structures and to verify the correctness of the design of compact flat roofs with a wood-based construction and to more comprehensively analyze the effect of using a vapor barrier, or vapor barriers with a variable value of the diffusion thickness Sd and a layer of gravel to spread moisture in the constructions.
Our research focuses on the dynamic spread of moisture in compact flat roofs. We aim to develop a more precise method for evaluating moisture spread in structures. This will help us confirm the accuracy of the design of compact flat roofs with wood-based construction, mainly when using vapor barriers with varying diffusion thickness Sd and a layer of gravel.
MATERIALS AND METHODS
Analyzed constructions of compact flat roof
During the analysis of the moisture properties of compact flat roofs based on wood, six types of structure compositions were created. Different types of a vapor barrier or vapor retarder (vapor barrier with high diffusion thickness (Sd= 300 m), vapor retarder with variable diffusion thickness with an extensive range (Sd = 0.5-30 m), or vapor retarder with variable diffusion thickness with a small range (Sd = 0.3-5m)), while each of these versions were considered in two variants. The first variant is with gravel backfill, and the second is without a layer of gravel backfill. The most crucial step was selecting assemblies commonly used in national conditions for compact flat roofs based on wood. The structural and material design of the individual assemblies S1A-S1C and S2A-S2C used to determine the moisture behavior is shown in Fig. 1 and Fig. 2 (mPVC – a waterproofing film made of softened polyvinyl chloride, EPS – expanded polystyrene, OSB – oriented strand board, SDK –
plasterboard).Forthenumerical analysis in theWUFIprogram, a modelof thosementioned above compact flat roofs with a length of 1500 mm was modeled in the "Geometry" section.

Fig. 1 Structure composition of wood-based compact flat roof with gravel backfill, versions S1A-C (version A – vapour barier Sd=300m; version B – vapour retarder Sd=0 3-5m; version C – vapour retarder Sd=0.5-30m)(author).

Fig. 2 Structure composition of wood-based compact flat roof without gravel backfill, versions S2A-C (version A – vapour barier Sd=300m; version B – vapour retarder Sd=0.3-5m; version C – vapour retarder Sd=0.5-30m)(author).
Internal boundary conditions
For internal boundary conditions, the sinusoid shown in Fig 3 was used for temperature and relative humidity to oscillate between 20°C (winter) and 22°C (summer), the average internal temperature is 21°C. The relative humidity varies between 40% (winter) and 60% (summer), the average relative humidity is 50%. These internal boundary conditions are anchored in technical standard EN 15026 and WTA Guideline 6-2 and are recommended for hygrothermal simulations (Künzel, 2014).
3 Boundary conditions on the interior side of the structure during year
External boundary conditions
For the external boundary conditions, the Vienna area was chosen because it is the closest location that contains hourly data collection for temperature, relative humidity and solar radiation Fig. 4. For the external boundary conditions, the measured hourly values of the following quantities were used: temperature, relative humidity, amount of precipitation, direction and wind power, shortwave and longwave radiation.
Fig. 4 Boundary conditions on the exterior side of the structure during year.
Setting up numerical analysis in the WUFI program
After modeling the geometry of fragments of compact flat roofs and determining the individual materials in their compositions, the data for the computational network was entered into the calculation. The modeled fragment was divided into 20 elements along the width (axis X) and 30 elements along the height (axis Y), with the fact that each layer of the composition, even the thinnest one (vapor barrier or vapor retarder), consists of at least two units. Data from the WUFI database were determined as initial conditions for individual materials. Table 1 contains data on temperature (°C), water content in materials (kg/m3) and relative humidity (%).
In the calculation parameters, 43,800-time steps (hours) were entered corresponding to five years with a start date of October 1. The calculation was intentionally started before the winter season given the more demanding external boundary conditions exposed to the fragment during the winter period. Subsequently, the numerical analysis began.
Requirements for compact flat roof constructions from the point of view of moisture diffusion
In the numerical analysis, other requirements were chosen for evaluating the moisture spread in the roof sheathing than the current requirements stated in the standard STN 73 0540-2+Z1+Z2. The author evaluates the following requirements because he considers them sufficient for determining the long-term life of the roof sheathing from the point of view of moisture and its spread
1. There must be no accumulation of moisture in the entire roof covering during the mentioned period
2. There must be no accumulation of moisture in any layer of the roof covering during the mentioned period.
3. In wood-based layers, the critical moisture content of the material exceeding 20% will not be reached from the point of view of the risk of biodegradation by molds and wood-destroying fungi causing rot.
RESULTS AND DISCUSSION
Before evaluating the numerical analysis, the following hypotheses are considered:
1. In the compositions of compact flat roof structures using vapor barrier S1A, S2A, there will be the slightest moisture change in the structures during the annual cycles, and OSB and Zell will have the least moisture compared to the vapor retarder structure compositions S1B; S2B; S1C and S2C.
2. In compositions using a vapor retarder with a variable value of Sd, without gravel backfill S2B and S2C, sufficient overheating of the structure will occur during summer days. The moisture in the individual layers will rise slightly in the constructions during the colder months (October – April) but decrease significantly during the warmer months (May –September) and thus, there will be no accumulation of moisture in the constructions.
3. In compositions using a vapor barrier with a variable value of Sd and with gravel backfill S1B and S1C, there will not be sufficient overheating of the structure. The moisture in the individual layers will increase in the construction during the colder months (October – April) and decrease slightly during the warmer months (May – September). In structures with vapor retarder foils and gravel, sufficient overheating may not occur during the warmer months, which may result in the accumulation of moisture in these structures during the observed annual cycles.
The values of the outdoor air temperature and relative air humidity were entered into the numerical calculation as shown in Fig. 4. The indoor air temperature was 21 ± 1 °C and the relative air humidity was 50 ± 10%; the conditions corresponded to human occupancy in accordance with the European standards and WTA Guidelines, as shown in Fig. 3.
The analyzed structures of compact flat roofs were assessed from the point of view of the requirements determined by the author for the correct functionality of the structures. According to Fig. 5, it can be seen that the first requirement determined by the author, namely that moisture must not accumulate in the entire roof shell, is met by all assessed compositions of flat compact roof structures. There is no accumulation of moisture in any of
the evaluated construction compositions. With repeating annual cycles, the compositions dry out over time. Compositions of constructions with gravel backfill (S1A; S1B and S1C) will reach the state of humidity after only two years. Compositions without graveling and with a vapor retarder film of variable diffusion thickness dry out significantly in the first years Still, even afterfiveyears,these compositions donot reachastateofmoisturebalance, and the volume of moisture decreases further every year. The most significant amount of moisture and thus the risk with the greatest probability of biodegradation is concentrated in the oriented strand board – OSB and wood fiber thermal insulation Steico Zell, which can be seen in Table 2. Therefore, the results will deal with the analysis of moisture in these layers (oriented strand board – OSB and wood fiber insulation) in more detail. In Fig 8 and Fig. 9, we can observe the course of moisture volume in individual compositions in the thermal insulation Zell and in the OSB board – the materials most stressed by moisture in the analyzed structure.

6 Diffusion flux direction S2C in November – from ZELL to OSB (WUFI2DMotion).

7 Diffusion flux direction S2C in May – from OSB to ZELL (WUFI2DMotion).
Tab. 3 Average moisture content in OSB in the observed time period [M -%].
4
5
Tab. 4 Average moisture content in ZELL in the observed time period [M -%].
1
2
3
4
Fig. 9 The moisture content of the OSB – oriented strand board.
From these images, it is evident that the influence of roofing on the moisture behavior of the structure is comparable to the effect of shading on moisture properties (Nusser et al. 2010, Bachinger et al. 2016). Tracks with gravel backfill S1A, S1B, and S1C reached moisture balance during the first year of the calculation, and the moisture content of the most stressed materials varies in annual intervals without much change. In the compositions without gravel backfill S2A, S2B and S2C there is more overheating of the structure during the summer months. The consequence of this overheating of the structure is the rotation of the diffusion flow of moisture in the structure in the area of the OSB and the vapor barrier or vapor retarder shown in Fig. 6, Fig. 7. In the case of using a vapor retarder (S2B, S2C), compared to the use of a vapor barrier (S2A), there is a reduction in the moisture of wood fiber insulation Zell – drying. The drying in the thermal insulation layer is most pronounced in the case of S2B constructions, where a vapor retarder film with a variable diffusion thickness is used with a low dispersion of the values (0.3 – 3m). The differences can be compared with "on-site measurements" (Langerock et al. 2017).
In Table 3, we can see that the average moisture of OSB decreases over time in all compositions. Table 4 shows a significant decrease in the average moisture of wood fibre insulation Zell. After five modeled years, the highest moisture is in the compositions with the use of a vapor barrier S1A and S2A.
From the results of the modeling and analysis of moisture in wood fiber thermal insulation Zell in Fig 9 and OSB in Fig 8, it is possible to evaluate the author's second and third requirements for moisture propagation in a compact flat roof. No moisture is accumulated in any version of the construction tracks or in any layer of these tracks. At the same time, in any layer of a compact flat roof, the moisture will not reach a critical value exceeding 20%. This did not meet any requirements for the risk of biodegradation by molds and wood-decay fungi (Viitanen and Ritschkoff 1991, Venäläinen et al. 2003, Wang and Morris 2010, Alev and Kalamees 2016).
The first hypothesis that in the composition of constructions with the use of vapor barrier S1A and S2A, there will be the smallest change in moisture and the layers of OSB
and Zell will be the driest compared to other analyzed compositions, is partially refuted by the analysis. We can completely refute it in Fig 9, where we can see that wood fiber insulation Zell has the highest moisture in constructions with the use of a vapor barrier S1A, S2A. This is due to the fact that during the summer period, when, according to Fig. 7, the diffuse flow of moisture is reversed from the OSB through Zell to the vapor barrier, the moisture stops on the vapor barriers and accumulates there. When using a vapor retarder, this moisture is released to a certain extent. When evaluating OSB moisture, the first hypothesis is partially disproved. In the composition with gravel backfill S1A, OSB has the highest moisture content of the analyzed compositions, but in versions without gravel backfill S2A, OSB has the lowest moisture content.
The second hypothesis suggested that in compositions using a vapor retarder with a variable value of Sd (diffuse thickness) without gravel backfill S2B and S2C, the moisture in the individual layers of the structures would increase more during the colder months (October – April) than in a structure with a vapor barrier, but decrease more significantly during the warmer months (May – September), thereby preventing moisture accumulation, is confirmed by our analysis. Fig. 9 and Fig. 8 provide strong evidence that there is no moisture accumulation in annual cycles during the analyzed period of five years. However, the variance of moisture between summer and winter is the highest, a key finding that supports our second hypothesis.
The third hypothesis, which anticipated that in compositions using a vapor retarder with a variable value of Sd and with gravel backfill S1B and S1C, there would not be sufficient overheating of the structure, the moisture in the individual layers would increase during the colder months (October – April), and decrease slightly during the warmer months (May – September ), is partially confirmed by our analysis. In structures with vapor retarders and gravel backfill S1B and S1C, sufficient overheating may not occur during the warmer months, potentially leading to moisture accumulation in these structures during the observed annual cycles. It is important to note that sufficient overheating was not the focus of this analysis. However, according to Fig. 9 and Fig. 8, we can confirm that moisture accumulation does not occur in structures S1B and S1C during the observed five annual cycles, a significant finding that supports our third hypothesis.
CONCLUSION
Based on the objective of the contribution to compare functionality when using different types of vapor barriers and shadowing compact flat roofs the following results can be presented:
• The built-in moisture in the structures during construction is decisive for the roof's moisture functioning. If the structure gets wet during construction, the risk of mold formation and its spores and fungi causing rotting increases significantly
• With the correct implementation of the vapor barrier in the compositions S1A and S2A and the vapor retarder in the compositions S1B, S1C, S2B and S2C, the analyzed compositions of compact flat roofs are safe from the point of view of moisture. The choice of materials and the arrangement of layers in the analyzed compositions do not show an increased risk from the point of view of thermal moisture properties. When using a vapor barrier, the importance of the correct vapor barrier layer is the most important, since the ability of the structure to dry with the use of a feather barrier is the lowest
• It has been shown that in the case of using vapor retarder foils with a variable Sd value, compact flat roofs without graveling can dry out more significantly during the summer season and thus prevent the formation of molds and fungi.
• The WUFI analysis showed that the effect of graveling a compact flat roof, or its shading is significant from the point of view of the flow of moisture in the structures. Versions without gravel backfill show, after five annual cycles, lower moisture in the most moisture-exposed insulation materials Zell and OSB compared to the same construction compositions that were gravelled.
• Numerical analysis of selected compositions of compact flat roof constructions showed the fact that in the analyzed compositions the graveling of the roof or other shading of the exterior surface of the roof (green roof, photovoltaic panels, solar system, air-conditioning technology, etc.) affects the moisture regime of a compact flat roof more than the choice of vapor barrier layer (foil), whether vapor barrier or vapor retarder with variable diffusion thickness, and therefore it is necessary to in the proposals, focus on the fact whether the roof will be gravelled, or whether it will be shaded in another way mentioned above.
REFERENCES
Alev, Ü., Kalamees, T., 2016. Avoiding mould growth in an interiorly insulated log wall. Building and Environment, 105: 104-115.
Bachinger, J., Nusser, B., Bednar, J., Teibinger, M., 2016. Influence of an unvented air cavity at the cold side of the insulation in sun exposed wooden flat roofs, World Conference on Timber Engineering Vienna - Austria, August 22.-25.2016.
Björk, F., Enochsson, T., 2009. Properties of thermal insulation materials during extreme environment changes. Construction and Building Materials, 2009, 23.6: 2189-2195.
EN 15026. Hygrothermal performance of building components and building elements – Assessment of moisture transfer by numerical simulation, 2007.
EN322. Wood-Based Panels-Determination of Moisture Content; Slovak Office of Standards, Metrology and Testing: Bratislava, Slovakia, 1995.
Geving, S., Lunde, E., Holme, J., 2015. Laboratory investigations of moisture conditions in wood frame walls with wood fiber insulation. Energy Procedia, 78: 1455-1460.
Glaser, H., 1959.Grapisches Verfuhren zur Untersuchung von Diffusionsvorgangen. Kaltetechnik, 11, 1959, 345-355.
Hill, D., 2003. Review of hygrothermal models for building envelope retrofit analysis. Research Highlights, Canada Mortgage and Housing Corporation, November, 1-4.
Kontoleon, K. J., Giarma, C., 2016. Dynamic thermal response of building material layers in aspect of their moisture content. Applied Energy, 170: 76-91.
Krus, M., 1996. Moisture transport and storage coefficients of porous mineral building materials. Theoretical Principles and New Test Methods. IRB-Verlag Stuttgart
Künzel, H M., 1995. Simultaneous heat and moisture transport in building components. One-and two-dimensional calculation using simple parameters. IRB-Verlag Stuttgart, 65.
Künzel, H M., 2014. Accounting for unintended moisture sources in hygrothermal building analysis. Proceedings of the 10th Nordic Symposyum of Building Physics. Lund, Sweden, 1519 June 2014, pp. 947-953.
Langerock, CH., Tilmans,A., De Mets, T., Lancour, X., Nguyen, E., Charron, S.,Michaux, B., 2017 Hygrothermal behaviour of compact roofs in wood frame constructions through on-site measurements. Energy Procedia, 132: 813-818
Mrlík, F., 1985. Vlhkostné problémy stavebných materiálov a konštrukcií [Moisture problems of building materials and constructions]. Vydavateľstvo ALFA Praha
Nusser, B., Teibinger, M., Bednar, T., 2010. Messtechnische Analyse flachgeneigter hölzerner Dachkonstruktionen mit Sparrenvolldämmung Teil 1: Nicht belüftete Nacktdächer mit
Folienabdichtung -Metrological analysis of flat-sloping wooden roof structures with full rafter insulation Part 1: Non-ventilated bare roofs with foil sealing. Bauphysik, 32.3: 132-143.
STN 73 0540-2+Z1+Z2., 2019. Thermal Protection of Buildings-Thermal Performance of Buildings and Components-Part 2: Functional Requirements; Slovak Office of Standards, Metrology and Testing: Bratislava, Slovakia.
Vidholdova,Z.,Reinprecht,L.,Krokošová,J.,2016.Náchylnosťdrevanamikrobiálnukontamináciu baktériami a plesňami [Susceptibility of wood to microbial contamination by bacteria and fungi]. Proceedings of the International Conference CSTI 2015 Conservation Science, Technology and Industry, Bratislava, Slovakia, 7-9 October 2016; pp. 307-314.
Viitanen, H., Ritschkoff, Anne-Ch., 1991. Mould growth in pine and spruce sapwood in relation to air humidity and temperature. Swedish University of Agricultural Sciences.
Venäläinen, M., Harju, A.M., Kainulainen, P., Viitanen, H., Nikulainen, H., 2003. Variation in the decay resistance and its relationship with other wood characteristics in old Scots pines. Annals of forest science, 60.5: 409-417.
Wang, J.Y., Morris, P.I., 2010. A review on conditions for decay initiation and progression. In: 41st Annual Meeting of the International Research Group on Wood Protection, Biarritz, France, 913 May 2010. IRG Secretariat
Wang, Y , et al. 2022. The impact of temperature and relative humidity dependent thermal conductivity of insulation materials on heat transfer through the building envelope. Journal of Building Engineering, 46: 103700.
Wta-Guideline 6-2. Simulation wärme- und feuchtetechnischer Prozesse. Draft Oct. 2013.
AUTHORS’ ADDRESSES
Ing. Martin Haladej
Technical University in Zvolen Faculty of Wood Sciences and Technology Department of Wooden Constructions
T. G. Masaryka 24 960 01 Zvolen
Slovakia xhaladejm@is.tuzvo.sk haladej.martin20@gmail.com
M-House, s.r.o. Hranicna 18 825 05 Bratislava Slovakia haladej@mhouse.sk
ACTA FACULTATIS XYLOLOGIAE ZVOLEN, 66(1): 105 113, 2024
Zvolen, Technická univerzita vo Zvolene
DOI: 10.17423/afx.2024.66.1.08
RHEOLOGICALSTUDY OF INDUSTRIALVARNISHESAT VARIOUS TEMPERATURES
Milena Henke – Barbara Lis – Tomasz Krystofiak
ABSTRACT
Superior surface finishing in furniture manufacturing requires an understanding of varnish product rheology. The rheological properties of acrylic primer, basecoat and topcoat, intended for roller varnishing and UV curing are examined in the study. Two methods were used to measure viscosity: Brookfield rheoviscometer and Ford cup. The results discuss the effect of increasing temperature on a decrease in viscosity. Rheological modeling using the Ostwald de Waele power law model explained the non-Newtonian, shear-thinning, rheostablebehavior ofliquid. It was shownthat the flowindexofsomevarnishproducts in Standard Conditions for Temperature was close to the Newtonian fluid However increasing consistencyindexparameterindicatesthepseudoplasticbehaviorofthefluid.Thefindingshighlight the importance of controlling viscosity and temperature during varnish product application processes to ensure optimal coating quality. This research provides valuable insight into the rheological properties of industrial coatings, facilitating advances in coating technology and quality control practices.
Keywords: acrylic varnish; conventional viscosity; apparent viscosity; Ostwald de Waele rheological model
INTRODUCTION
Dueto thedevelopment ofthefurnitureindustry,manufacturersmust providethehighest quality furniture to meet customer expectations. Raising the standards of surface finishing directly affects the development of customers' first aesthetic impressions when choosing furniture. Understanding the rheological characteristics of varnish products is essential to raising the quality and efficiency of coating production (Bekhta et al., 2018; Henke et al., 2022)
Rheological tests are necessary to develop the recipe for a varnish product, design paint installations and control the quality of the product and the technological process. The basic value characterizing rheological properties is viscosity. Liquids whose viscosity under isothermal conditions is constant and does not depend on the shear rate or the time of shear stress are called Newtonian fluids. All other liquids with a variable viscosity determined by the value of these parameters, tested using rheometers, are classified as non-Newtonian materials. They include rheostable materials with viscosity depending only on the shear rate, rheologically unstable materials with properties that change over time, and viscoelastic materials revealing the cumulative properties of solids and liquids. In industrial practice, viscosity is determined using the Ford viscosity cup.This method is very popular in contacts
between the manufacturer of varnish products and their recipients - production companies (Wiśniewski, 1988) An advanced method of determining apparent viscosity is the Brookfield rheoviscometer. Varnish products experience different shear rates during application (Proszyk et al., 1995)
Low viscosity varnishes are easier to spread, ensuring seamless coating, and are ideal for spray application. The lower the viscosity of the product, the thinner the layer. However, the coatings may have poor adhesion. The high viscosity of the products provides greater control over the process, but their application is more demanding. If the product’s viscosity is too high, the adhesion of the formed coatings may be incorrect due to the difficult distribution of the varnish. The condition for achieving good quality coatings is also proper preparation of varnishes by mixing them thoroughly. Insufficient mixing of the products results in uneven viscosity of the products. This results in the appearance of streaks, air bubbles and unevenness (Butt, 2022; Ozdemİr et al., 2013; Proszyk, 1999; Saranjam et al., 2016)
Proszyk (1999) indicated the importance of the effect of temperature on viscosity. The annual temperature range in the production hall forces manufacturers to look for solutions thatensureconstant conditionsfortheappliedvarnish (Schramm,1998) Makarewicz(1991) observed that the components and their interactions have a significant impact on the shear behavior of liquids. Unstable viscosity in the process can affect the color and gloss of coatings due to uneven pigment dispersion as well as the orientation and distribution of matting agents (Makarewicz, 1991; Zheng and Chen, 2023).
The aim of this work is to analyze the viscosity of industrially produced varnishes using two methods, with emphasis on its dependence on temperature. The results of the conducted research will be of significant importance for the manufacturing industry, indicating the need to control the application processes of paint products and improving the quality of final products. They will also contribute to understanding the mechanisms influencing the properties and performance of coating systems, which is crucial for the further development of technologies in this field.
MATERIALSAND METHODS
Materials
The tests included acrylic varnishes: primer, basecoat and topcoat intended for UV curing in industrial conditions (Table 1). The manufacturer’s specified varnish composition is as follows:
• Primer: calcium carbonate ≥ 40–<60%; ethoxylated propylidynotrimethanol, esters with acrylic acid ≥ 20–<40%; 4,4’-Isopropylidenediphenol, oligomeric reaction products with 1-chloro-2,3-epoxypropane, esters with acrylic acid ≥ 5–<10%; and 1-metoksypropan-2-ol ≤ 0.5%.
• Basecoat: titanium dioxide ≥ 40–<60%, propylidinetrimethanol ≥ 10–<20%; 4,4’Isopropylidenediphenol, oligomeric reaction products with 1-chloro-2,3epoxypropane, esters with acrylic acid ≥ 5–<10%; alkoxylated pentaerythritol tetraacrylate ≥ 5–<10%; diacrylic dipropylene glycol ≥ 3–<5%; polymer based on polyoles and modified acrylic acid esters ≥ 2.5–<5%; phenyl-bis(2,4,6trimethylbenzoyl-)phosphine oxide ≥ 0.1–<1%; and 2-propenoic acid, 1,1’- [(1methyl-1,2-ethanediyl) bis[oxy(methyl-2,1-ethanediyl)]]ester, reaction products with di-ethylamine ≥ 0.1–≤0.5%.
• Topcoat: propylidinetrimethanol, ethoxylated, esters with acrylic acid 20–40%; 4,4’-Isopropylidenediphenol, oligomeric reaction products with 1-chloro-2,3epoxypropane, esters with acrylic acid 10–20%; titanium dioxide (1-methyl ethane1,2- diyl)-bis[oxy(methyl ethyl-2,1-diyl)] diacrylate 10–20%; diacrylate (1-methyl ethane-1,2- diyl)-bis[oxy(methyl ethyl-2,1-diyl)] 5–10%; 2,2bis(acryloxymethyl)butyl acrylate 2.5–5%; methyl benzoylformate 2.5–5%; amorphous silica (silica gel, precipitated silica) 1–2.5%; tetrabutylammonium bromide 1–2.5%; 2-propenoic acid, 1,1’-[(1-methyl-1,2-ethanediyl) bis[oxy(methyl-2,1-ethanediyl)]]ester,reaction products with diethylamine≤ 0.5%; and photoinitiator ≤ 0.1%.
Tab. 1 Basic properties of varnish products. Parameter
Solids content [%] acc. to the PN-EN ISO
Viscosity measurement
The varnishes were taken from the production warehouse and tested in the production laboratory. Apparent viscosity was determined using a Brookfield rheoviscosimeter model DVII+EXTRAusing atemperaturemanual controller.Thetest was performedusing spindle no. 27 at temperatures of 25 and 40°C.The spindle speed was increased in ten-time intervals every 2 minutes from 15 to 60 RPM (revolutions per minute) for primer and from 100 RPM to 145 RPM for basecoat and topcoat. Spindle speeds were selected experimentally according to the manufacturer's recommendations to ensure that the spindle operated above 10 percent of the device scale.
Ford cup No. 4 was used to determine the conventional viscosity. Four different test temperatures were selected: 15, 25, 40, 55°C, which represent both extreme and typical temperatures of varnish products occurring in a transitional temperate climate characterized by four seasons (Schramm, 1998). The temperature was measured using a pyrometer. Six measurements were performed for each variant (Dziubiński et al., 2014)
Determination of the rheological model
Based on the obtained test results, it was decided to use the power Ostwald de Waele rheological model. The data from the experiments were approximated with an appropriate rheological model, and then the parameter values of this model were determined based on the formula below (Proszyk et al., 1995).
Where: τ – shear stresses
k – consistency index
γ– shear rate
n1 – flow index
RESULTSAND DISCUSSION
Viscosity measured using rheoviscometer
Table 2 shows the results of the rheological parameter of varnish products at various temperatures and presents them in Figures 1-6.
Table 2. Rheological parameters of the Ostwald de Waele model as a function of temperature.
Fig. 1 Dependence of viscosity (ɳ) on RPM at two various temperatures for the primer.
Fig. 2 The influence of temperature on the flow curves of the primer approximated using the Ostwald de Waele rheological model.
Fig. 3 Dependence of viscosity (ɳ) on RPM at two various temperatures for the basecoat.

Fig. 4 The influence of temperature on the flow curves of the basecoat approximated using the Ostwald de Waele rheological model.
Based on the presented analyzes of flow curves determined graphically and data from thedetermined Ostwald deWaelerheological model,thedatatestedin theaboveranges were classified into the category of non-Newtonian, shear-thinning, rheostable fluids. In the literature, these liquids are also called pseudoplastic liquids (Proszyk et al., 1995; Zorll, 1980).

Fig. 6 The influence of temperature on the flow curves of the topcoat approximated using the Ostwald de Waele rheological model.
Based on the figures, it was found that the viscosity η of the varnish product decreases with an increase in the γ value. The highest viscosity is represented by the primer, then the basecoat, and the topcoat. An increase in temperature caused a decrease in viscosity by 4045%. Table No. 2 presents the values of the rheological parameters of the Ostwald de Waele power model. High values of the correlation coefficient R2 at the level of 0.993 – 0.999 confirm the good fit of the model to the data and prove its suitability for rheological descriptions of the tested products. According to the evaluation criteria of Kembłowski and Wiśniewski, the tested varnish products in the tested area of γ values meet the following relationship: η’= τ / γ ≠ const (Kembłowski, 1973; Wiśniewski, 1988). In rheological modeling, the power exponent n1 is a measure of the fluid's deviation from a Newtonian fluid; n1<1 determines whether the fluid is classified as a non-Newtonian fluid.As the value of n1 decreases, the fluid shows a more and more clearly non-Newtonian character (Krystofiak, 2023). In the conducted analyses, n1 was at the level of 0.824-0.996
Primer and topcoat at a temperature of 25°C exhibit rheological properties at the boundary of non-Newtonian and Newtonian liquids. This assessment was made on the basis of thehighn1levelandthealmostrectilineararrangementofpointsontheviscosity ɳ[mPas] – spindle speed (RPM) graph. However, the flow index decreases for a temperature of 40°C, indicating pseudoplastic properties. In the case of primer, this decrease was 8.9%, and in the case of basecoat 7.9%. The greatest decrease in the n1 index was recorded for the topcoat, it amounted to 17.3%. This is an important indication for some parameters in production practice. Especially when the main goal is to obtain defect-free coatings (Dziubiński et al., 2014; Krystofiak, 2023)
Based on the results obtained, it can be concluded that the rheological parameter of the Ostwald de Waele model, which distinguishes the tested fluids, is consistency index k. The higher the k value is, the faster the material responds to changes in shear stress is. The
highest k coefficient was recorded for primer.Also, for this product, the highest decrease in this parameter was recorded with an increase in temperature, which amounted to 40%. In the case of basecoat, a reduction of 26% was observed. Different rheological behavior in terms of consistency index k1 is represented by the topcoat, for which a 10% increase with increasing temperature was recorded.
Viscosity measured using the Ford Cup method
Fig 7 The impact of temperature on varnish products viscosity
Based on the data presented (Figure 7), it can be concluded that the viscosity decreases with increasing temperature. The most significant decrease (43% - 49%) in this parameter was recorded for varnishes when the temperature changed from 15 to 25°C, which indicates the need to condition varnish products for a sufficiently long time, especially in the winter season, in order to ensure the appropriate temperature during their application. The differences between 25 and 40°C were 48% for primer and 39-40% for topcoat and basecoat. Subsequent temperature increases to 40 and 55° resulted in a smaller decrease in viscosity. The obtained results correspond to literature data on the influence of temperature on the viscosity of fluids (Klazly and Bognár, 2022). Research on coatings system based acrylic resin with UV absorber confirms a decrease in coating thickness with decreasing viscosity (Ozgenc, 2019) Due to the layer being too thick, an orange-peel effect may appear after the solvents are removed (Saranjam et al., 2016).The viscosity of the products is adjusted based on the intended application method to prevent possible defects (Jakubíková et al., 2023) Researchers also indicate that viscosity affects pumping efficiency. Ensuring a constant supply of the right amount of varnish to the applicator is a very important issue in engineering applications (Klazly and Bognár, 2022) To achieve high quality and effectiveness of products, it is necessary to comply with certain conditions in technological processes. Viscosity is an important analytical parameter that is monitored both during productionandwhenassessingtheuseofproductsinvarioussectorsofthechemicalindustry (Gosselin, 2024; Ruśkowska, 2010).
CONCLUSION
The findings mentioned above, along with the results of the analysis of flow curves determined graphically, allow for the tested acrylic products, i.e., primer, as well as both the
base coat and the top coat, to be classified as non-Newtonian, shear-thinning, rheostable fluids, also known as pseudo-plastic liquids.
Understanding the influence of temperature on viscosity and the rheological model is not just theoretical knowledge. It allows for precisely adjusting the varnish product to the desired coating quality, underscoring the practical relevance of controlling this parameter. What is more, both testing the viscosity using a Ford cup method and using the Brookfield viscometer, have provided significant information on how varnishes behave.The analysis of the rheological model allows for a better understanding of the properties of varnishes, whereas viscosity tests using the Ford cup method provide practical information that can be directly used during the application processes.
REFERENCES
Bekhta, P., Krystofiak, T., Proszyk, S., Lis, B., 2018. Surface gloss of lacquered medium density fibreboard panels veneered with thermally compressed birch wood. Progress in Organic Coatings, 117, 10–19. https://doi.org/10.1016/j.porgcoat.2017.12.020
Butt, M.A., 2022. Thin-Film Coating Methods:ASuccessful Marriage of High-Quality and Cost-Effectiveness A Brief Exploration. Coatings, 12(8). https://doi.org/10.3390/coatings12081115
Dziubiński, M., Kiljański, T., Sęk, J., 2014. Podstawy Teoretyczne i Metody Pomiarowe Reologii. Monografie Politechniki Łódzkiej
Gosselin, C.A., 2024.ASTM Standards for Measuring Viscosity. CoatingsTech, 21(3).
Henke, M., Lis, B., Krystofiak, T., 2022. Gloss Level of HDF Finished with Different Numbers of Layers and Hardened with UV Hg-Ga Lamps of Selected Power. Coatings, 12(4). https://doi.org/10.3390/coatings12040533
Jakubíková, K. H., Hodul, J., Hermann, R., Drochytka, R., 2023. Development of a Hydrophobic Polymer Coating in Polyurethane Organic–Mineral Base Containing Waste from Fibreglass Production. Coatings, 13(11), 1934. https://doi.org/10.3390/coatings13111934
Kembłowski, Z., 1973. Reometria płynów nienewtonowskich. Wydawnictwo Naukowo Techniczne.
Klazly, M., Bognár, G., 2022. A novel empirical equation for the effective viscosity of nanofluids based on theoretical and empirical results. International Communications in Heat and Mass Transfer, 135, 106054. https://doi.org/10.1016/j.icheatmasstransfer.2022.106054
Krystofiak, T., 2023. Wood Industry - Past, Present and Future Outlook (G. Du & X. Zhou, Eds.). IntechOpen. https://doi.org/10.5772/intechopen.100751Makarewicz, E. (1991). Struktury tiksotropowej organodyspersji polichlorku winylu na podstawie analizy modeli płynięcia Crossa i Carreau. Przemysł Chemiczny, 70(11), 468–471.
Ozdemİr, T., Bozdoğan, Ö., Mengeloglu, F., 2013. Effects of varnish viscosity and film thickness on adhesion strength of coated wood. Pro Lingo, 9(4), 164–168.
Ozgenc, O., 2019. Determination of some technological properties on coating systems based acrylic resin with UV absorber. IF6C 2016 International Furniture Congress 13-15 October 2016, 283–285.
Proszyk, S.,1999. Technologia tworzyw drzewnych wykończenie powierzchni. WSiP.
Proszyk, S., Władyka-Przybylak, M., Kystofiak, T., 1995. Badania właściwości reologicznych ogniochronnej żywicy AFF podczas składowania. Roczniki Akademii Rolniczej w Poznaniu – CCLXXIX, Chem. Technol. Drew., 27(28), 147–155.
Ruśkowska, P., 2010. Wiskozymetryczne materiały odniesienia i wzorcowanie kubków wypływowych In Biuletyn Głównego Urzędu Miar Nr (Vol. 1, Issue 16).
Saranjam,N., Chandra, S.,Mostaghimi, J., Fan,H.,Simmer,J.,2016. Orangepeel formation due to surface tension-driven flows within drying paint films. Journal of Coatings Technology and Research, 13(3), 413–426. https://doi.org/10.1007/s11998-015-9752-6
Schramm,G.,1998.Reologia.Podstawyizastosowania.OśrodekWydawnictwNaukowych, Poznań.
Wiśniewski, R., 1988. Problemy badań reologicznych w przemyśle tworzyw i farb. Polimery: Tworzywa Wielkocząsteczkowe , 33(4), 133–136.
Zheng, S. X., Chen, H. S., 2023. Correlations of rheological methods to coatings’ performance. Progress in Organic Coatings, 177, 107403. https://doi.org/10.1016/j.porgcoat.2022.107403
Zorll, U., 1980. Viskosiätsmeßgrößen und ihre polymeren Einflußfaktoren. Adhäsion, 5, 128–131.
AUTHORS’ADDRESSES
MSc. Milena Henke
Dr. Barbara Lis
Dr hab. Tomasz Krystofiak
Department of Wood Science and Thermal Techniques Faculty of Forestry and Wood Technology
Poznan University of Life Sciences
Wojska Polskiego 28 60-627 Poznan, Poland milena.henke@up.poznan.pl barbara.lis@up.poznan.pl tomasz.krystofiak@up.poznan.pl
ACTA FACULTATIS XYLOLOGIAE ZVOLEN, 66(1): 115 123, 2024
Zvolen, Technická univerzita vo Zvolene
DOI: 10.17423/afx.2024.66.1.09
THE EFFECT OF SELECTED FACTORS ON THE MECHANICAL PROPERTIES OF THE SEAMS FOR UPHOLSTERY COVERS MADE OF SYNTHETIC LEATHER
Anna Vilhanová – Nadežda Langová
ABSTRACT
Thequality andstructure ofthecoveringmaterial oftheupholsteredfurnitureis animportant factor affecting the properties of the stitched and, thus, the quality and durability of the upholstered furniture. The stitches of the cover layers are considered a critical place of the upholstery, in which deformations and possible damages are most visible. The paper is focused on synthetic leather, which is considered a composite, ecological and sustainable material. The bearer of the mechanical properties is the reverse side formed by the underlying textile. The focus is put on the influence of stitch length (4, 5, 6 mm) in the weft and warp direction of the underlying fabric of the synthetic leather. The stitched joint has higher strength and stiffness in the warp direction, but its efficiency is lower compared to the load in the weft direction. It means that the stitched material carries a greater load than the thread-connecting material. Joints with longer stitches hold the fabric together with less tension. The sewing thread carries higher loads with a longer stitch length. The results of joint strength and failure show that when creating cutting plans, it is advisable to orient the parts of the covering material so that the joint is stressed in the direction of the warp due to the user's load.
Keywords: furniture; upholstery seams; synthetic leather; sewing thread; seam length; seam quality.
INTRODUCTION
Fabric quality, as the most important element of upholstery or garment appearance, is determined by its mechanical properties. It is evident that these properties directly impact fabric processing properties. It can be seen through various forms of fabric behaviour under the loads that occur in sewing. Investigations of the correlations between stress and fabric behaviour are aimed at constructing a system to predict fabric behaviour in garment manufacturing processes, as well as to predict the appearance of the garment to be manufactured (Pavlinić et al., 2006; Geršak, 2003; Zavec and Geršak, 2000). The role of fabric properties in sewing performance and seam quality is essential. Therefore, it is crucial to understand the effect of different parameters on upholstery fabrics sewability properties. Thequality oftheeco-friendly fabricwas investigated bytheauthorsEsi andBaykal. (2020). In this study, recycled polyester yarns obtained by recycling waste polyethylene terephthalate bottles and standard polyester yarns were used in staple forms, 16 different chenille yarns were produced at different production parameters. As a result of the tensile
strength tests and statistical analyses, it is concluded that the weft-breaking strength of all types of woven fabrics, which have 100% recycled polyester in the structures of chenille yarns as weft, is slightly decreased compared to other types, but this decrease is not statistically significant.
Upholstery seams, for example, serve two purposes, both form and function. They have a practical function that allows them to hold the fabric together better or ensure a more profound sense of security, but they can also add visual interest to a piece otherwise lacking.
The quality of seam is assessed by means of its efficiency, elongation, bending, stiffness, abrasion resistance, seam slippage strength, puckering, tightness, boldness and seam damage. A good seam has various functional and aesthetic requirements. The functional performance of the seam is evaluated by efficiency, elongation, density, slippage, bending stiffness and abrasion resistance of the seam. The basic material of garmenting is fabric and sewing thread (Bhaves et al., 2018), which also applies in the case of creating a high-quality upholstered cover (Lange et al., 2022). Sewing threads are used in garments, upholstery, air-supported fabric structures and geotextiles to join different components by forming a seam. The primary function of a seam is to provide uniform stress transfer from one piece of fabric to another, thus preserving the overall integrity of the fabric assembly. Industrial sewing techniques make specific and often very exacting demands on the threads involved in the sewing process. The sewability of sewing threads is of major importance, having a very profound effect on seam quality and production costs. The sewing and the seam performance of a sewing thread are largely influenced by the material to be sewn, the sewing technique and the end-use for which the sewn material is intended. According to Dobilaite and Juciene (2006), sewing thread has a significant influence on the mechanical properties and quality of the sewn joint. In the work, the influence of mechanical properties of sewing threads on the seam pucker is evaluated Regarding seam pucker, the best results were established sewing with polyester threads, the reversible strain of which was the least. It was noticed that by increasing the number of layers in sewing, the influence of threads on seam pucker decreases. Polyester sewing thread is made of polyester filament or staple fiber, with high strength, good elasticity, wear resistance, low shrinkage, and good chemical stability. After different tests of extracted sewing thread from treated fabrics, it is clear that according to the properties wanted (softness, stiffness, non-wrinkling) the finishing products used affect the sewing thread’s behavior differently. So stiffening, waterproofing and antiwrinkling treatments increase the fabric resistance to needle penetration because of resins used when making film on the surface (Mansouri et al., 2014; Mansouri et al., 2022). Fireproofing of fabrics changes the seam strength, this may be due to fabric stiffening, resulting in less fabric flexibility. Under tension, the fabric will have a little stretch. To increase the seam strength, it is necessary to choose a thread with very high strength and low elongation at break. This solution will minimize the risk of broken threads in case of deviation of material features and technological parameters, which can be variable in the long duration of large-scale production (Skorupińska et al., 2021). Synthetic leather is a material that consists of two layers, a base fabric covered with a plastic material. Synthetic leatherettes are characterized by high durability, health safety, high abrasion resistance and their production and application are environmentally friendly. The surface layer may have an open-pored or compact construction consisting of PVC, although the modern types are made from PU and are embossed or textured to produce different leather looks. Nonwoven, woven and increasingly warp-knitted textiles, as well as combinations of these materials, are used as the textile materials. While faux leather has many of the same desirable attributes of genuine leather, it is not necessary to harm animals to create this substance. Also, the processing of genuine leather has rather inconvenient properties from an ecological point of
view, with parameters such as consumption of energy, water and the intensive content of chemical processes in the production process (Birkocak, 2022). Woven and nonwoven fabrics, and occasionally weft-knitted fabrics, are usually used when producing synthetic leather, but warp-knitted fabrics are now being used more and more. Based on the results of the work by Rahimi and Ahmadi (2020), woven fabric-reinforced leathers show the highest tensile and bursting strength, followed by knitted and nonwoven fabrics-reinforced ones, respectively. The highest tear strength value is observed in the nonwoven reinforced samples. Meyer et al., (2021) compared leather, synthetic leather and other alternative materials. The technical performance of the materials was compared, which allows an estimation of possible application areas. Structure and composition were characterized by microscopy and FTIR spectroscopy, the surface properties, mechanical performance, water vapor permeability, and water absorption by standardized physical tests. None of the leather alternatives showed the universal performance of leather. Woven and nonwoven fabrics, and occasionally weft-knitted fabrics, are usually used when producing synthetic leather, but warp-knitted fabrics are now being used more and more. The aim of the work is to determine the influence of the stitch length and the structure of leatherette with warp knitted fabrics underlying layer on the mechanical properties of sewn joints.
MATERIALS AND METHODS
Test samples are made of two-layer synthetic leather (Fig. 1). The underlying layer is a polyester knit, the top layer is made of a combination of Polyvinyl Chloride (PVC) with a content of 56% and Polyurethane (PU) with a content of 11%. The thickness of the two-layer synthetic leather is 1.04 mm, the density is 650g/m2. The yarns of the underlying layer are the same, the same in the warp and weft directions.

Two types of 100% polyester threads were used to create the stitches. The first thread is amultifilament thread SYNTONfineness 30, composedofa bundleofvery thin,infinitely long polyester fibres. The second thread is staple sewing thread BELFIL fineness 30, made of short length polyester fibres. The parameters of sewn joints for three stitch lengths of 4 mm, 5 mm and 6 mm were tested. Stitch length is a distance between two consecutive needle punches in one step sewn by a sewing machine. A reverse twist point LR 100 sewing needle was used to create the stitches (Fig. 2). Using LR needles the stitches have a slight diagonal inclination. With this cutting point you achieve a lenticular incision. This is done at a 45° angle to the seam direction. The result is a decorative seam inclined slightly towards the left.

2 LR sewing machine needle with cutting point.
The seams were loaded in the warp direction and also in the weft direction of the underlying layer of synthetic leather. In each direction, 8 test samples were tested. The stitches were made on a Juki 185 industrial sewing machine, with a tying stitch at a sewing speed of 4000 stitches/min. To determine the maximum force to rupture the seam, the Strip method, according to ISO 13935-1: 2014, was used. The tests were performed using the universal numerically controlled testing machine LabTEST 4.05 (Labor Tech). During the tensile test, the clamping length was set to 200 mm 1 mm, and the loading speed was 100 mm/min. The maximum force was recorded, and the type of damage of the sample was evaluated during the test. Two groups of samples were prepared to be stressed in the weft and in the warp direction of the synthetic leather underlying layer. The joints were loaded with a tensile force perpendicular to the seam line. The maximum force to rupture the seam wasdetermined.Theloadingschemeofthesampleandtheperformanceofthetestareshown in Figure 3.


One of the parameters that characterizes the quality of a seam is its efficiency. Seam efficiency is defined as the capacity of the material itself to carry a seam. Seam efficiency is the ratio of seam strength to fabric strength. Equation (1) was used to calculate the seam efficiency:
Where: FSmax - seamed fabric strength (N), FFLmax - unseamed fabric strength (N).
The seams of the covering materials are characterized as joints with a mechanical fastener, therefore, the methodology according to EN 26891 was used to determine the size ofthedisplacementinthejoint.Accordingtothismethodology,themodulusofdisplacement
ks (N/ mm) is determined in the interval from 10% to 40% of the maximum load. The slip magnitude is used as the basis for calculating the joint stiffness. The slip modulus a joint expresses force that is required to achieve a unit length deformation of the joint (Vilhanová, 2018). Joint stiffness is expressed in slip modulus ks which is calculated by the eq. 2:
Where: FSmax – maximum force to rupture the seam (N), ν04 – slip at 40% FSmax (mm), ν01– slip at 10% FSmax (mm)
Statistical analyses were carried out by using STATISTICA 12 software. All test results were assessed at significant levels of 0.05. The Univariate and Independent-samples t-tests were applied to examine the interaction as well as individual effects of each parameter on the seam strength and seam efficiency. Post-hoc analysis were also performed by using Duncan test in order to determine which means of groups differ significantly.
RESULTS AND DISCUSSION
The average force achieved when breaking the reference, unstitched sample stressed in the direction of the warp is 432.00 N (coefficient of variation CV = 4.29%) with a corresponding deformation of 101.58 mm. When stressed in the weft direction, the average breaking force is 307.22 N (CV = 2.33%) with a deformation of 221.33 mm. In the direction of the warp, synthetic leather with a knitted underlying layer shows higher stiffness and less elasticity (Fig. 4). The tensile behavior of synthetic leather is non-linear mainly because of the nature of knitted fabrics of underlying layers. In the weft direction the non-linear behavior is more pronounced than in the warp direction, because these yarns are submitted to more interlacements, which is due to the higher number of warp yarns per unit length.

Fig. 4 Load – displacement curves unstitched sample of the in warp and weft directions.
Whencomparing theresults with otherscientificworks (Ujevič et al.,2009; Vilhanová et al., 2022), the assumption that the samples of the synthetic leather with base layer from woven fabrics have a higher bursting strength and a smaller elongation at break than the samples of the artificial leather with base layer from knitted fabric was confirmed.
Table 1 shows the average tested mechanical properties of the seams synthetic leather in both direction, warp, and weft of the underlying layer.
Tab. 1 The average tested mechanical properties of the seams synthetic leather.
Seams generally achieved higher rupture forces in the warp direction. The highest average values of the force at seam rupture were achieved with BELFIL staple thread, with a stitch length of 4mm (357.98N) and with SYNTON multifil thread and a stitch length of 4mm (350.97N). This difference represents only 2%. Higher seam strength in the direction of the warp of synthetic leather was also confirmed in the research of Lange et al., 2022 and Vilhanová et al., 2022.
Based on Duncan's test, the influence of the studied factors on the strength of the seam was determined. Table 2 shows that the influence of factors acting independently, namely load direction, stitch length and thread type, is statistically significant at the 5% significance level (p=0.000). However, the influence of all three factors acting simultaneously is statistically insignificant at the 5% significance level.
Tab. 2 Table of three-factor analysis of variance.
Univariate Results Significance for FSmax and ks Sigma-restricted parameterization Effective hypothesis decomposition
Effect DOF
As shown in Figure 4, the unstitched reference sample has a higher stiffness in the warp direction, where the displacement modulus ks = 4.80 N/mm, which is 80% more than in the weft direction (ks = 1.01 N/mm). This is also visible in stitched samples, where the stiffness of the seam loaded in the direction of the warp of the underlying fabric of the synthetic leather is greater. In the case of BELFIL staple thread, the average value of the slip modulus in the warp direction is 4.68 N/mm, in the case of SYNTON multifil thread 4.606N/mm. The load direction factor is significant for the slip modulus (p = 0.000). Other factories as well as their concurrent effects are statistically insignificant.
According to (Gurarda, 2019), deam efficiencies of 60 – 80% are common but efficiencies between 80 and 90% are more difficult obtaining from seams. Low seam efficiency values indicate that the sewn fabric is damaged during sewing. Our measurements show a relatively high average seam efficiency (84%) for both types of threads,with a higher efficiency in the weft direction. Taking into consideration numerous parameters influencing the seam quality (type of material, type and thread count, seam type, stitch type, stitch denstiy), there are many possibilities for combining them with different final characteristics of seams. The main purpose of these combinations is defining the appropriate technicaltechnological parameters of sewing process to improve productivity and seam quality (Barbulov et al., 2012)
Evaluation of seam damage
Mechanical damages affect the aesthetics and performance of the upholstery cover During stitching, a sewing needle may damage the fabric mechanically, breaking or fragmenting the yarns. Such damages may be apparent immediately after stitching but frequently will not appear until the product is used when seams are subjected to some form of tension, stress, strain, or deformation.
Damage at the joint in warp direction is characterized by tearing of the joined material and the sewing thread in the 4 mm stitch remains undamaged. Damage to the underlying knitted layer in the direction of the warp is visible on the reverse side of the fabric (Fig. 5 a) Damage at stitches of length 5 and 6 mm in the direction of the warp was expressed by damage to the covering material and to the connecting material, thread (Fig. 5 b).




At all stitch lengths 4; 5 and 6 mm in the weft direction, the material to be joined is broken, while the structure of the underlying layer around the joint is not damaged. Also,
there was no breakage of the sewing thread. This is due to the lower strength of the joined material stressed in the weft direction, which is also reflected in the reference samples. It means that the failure will occur before the sewing thread itself starts to carry the load.
CONCLUSION
When sewing synthetic leather and covering materials in general, stitch factors such as thread type, stitch length, but also needle type, must be selected in such a way that the joint efficiency is not less than 70%. From this point of view, both staple sewing thread BELFIL and multifilament thread SYNTON staple threads are suitable for stitching synthetic leathers with stitch lengths of 4mm, 5mm and 6mm.
Based on the achieved strengths and the observed violation of the sewn joints, it is practical to orient the individual parts of the covering material in the creation of stitch plans. This ensures that the joint is stressed in the direction of the warp, aligning with the user's load. This practical approach is also supported by the slip modulus value, which is on average 4.5 times higher in the direction of the warp than in the direction of the weft.
When using a needle with an LR tip, both staple and endless filament sewing threads can be used. In future research, we recommend verifying the effect of thread fineness on the strength of upholstery stitched joints.
REFERENCES
Bhavesh, R , Madhuri, K , Sujit, G , Sudhir, M , Raichurkar, P., 2018. Effect of Sewing Parameters on Seam Strength and Seam Efficiency. Trends Textile Eng Fashion Technol. 4(1). TTEFT.000577.2018. https://doi.org/10.31031/TTEFT.2018.04.000577
Barbulov–Popov, D., Cirkovic, N., Stepanović, J., 2012. The influence of stitch density and of the type of sewing thread on seam strength. Tem Journal, 1(2), 104-110.
Birkocak, T. D., 2022. Effects of Needle Size and Sewing Thread on Seam Quality of Traditional Fabrics. TEKSTİL VE KONFEKSİYON. Tekstil Ve Konfeksiyon. https://doi.org/10.32710/tekstilvekonfeksiyon.1088043
Dobilaite, V., Juciene, M., 2006 The influence of mechanical properties of sewing threads on seam pucker, International Journal of Clothing Science and Technology, Vol. 18 No. 5, pp. 335-345. https://doi.org/10.1108/09556220610685276
Esi, B., Baykal, P. D., 2020. Investigation of tensile strength and elongation properties of chenille upholsteryfabrics includingrecycling polyester yarns. Journal of Engineered Fibersand Fabrics (Vol. 15, p. 155892502091604). SAGE Publications. https://doi.org/10.1177/1558925020916040
Gersak,J.,2003.Investigationsoftheimpactoffabricmechanical propertiesongarment appearance. Tekstil, 52(8), 368-379.
Gurarda, A., 2019. Seam Performance of Garments. Textile Manufacturing Processes. IntechOpen. https://doi.org/10.5772/intechopen.86436
Lange,J., Ciura, A.,Majewski,A., Wojnowska,M.,2022. Study ontheInfluenceof SelectedFabrics and Stitching on the Strength of Upholstery Covers. Materials 15, no. 11: 3854. https://doi.org/10.3390/ma15113854
Mansouri, S., Chaabouni, Y., Cheikhrouhou, M., 2014. Influence of finishing products on sewing needle penetration force. International Journal of Applied Research on Textile, 2(2), 33-41.
Mansouri, S., Yassin, C., Morched, C., 2022. Effect of Finishing Products on the Mechanical Properties of Sewing Thread. Msahli, S., Debbabi, F. (eds) Advances in Applied Research on Textile and Materials - IX. CIRATM 2020. Springer Proceedings in Materials, vol 17. Springer, Cham. https://doi.org/10.1007/978-3-031-08842-1_16
Meyer, M., Dietrich, S., Schulz, H., Mondschein, A., 2021. Comparison of the Technical Performance of Leather, Artificial Leather, and Trendy Alternatives. Coatings, 11, 226. https://doi.org/10.3390/coatings11020226
Pavlinić, DZ., Geršak, J., Demšar, J., Bratko, I., 2006. Predicting Seam Appearance Quality. Textile Research Journal. 76(3):235-242. https://doi.org/10.1177/0040517506061533
Rahimi, S., Ahmadi, MS., 2020. Mechanical properties of synthetic leather reinforced with woven, knitted and nonwoven fabrics. Indian J Fibre Text Res; 45: 312–318.
Skorupińska, E., Wiaderek, K., Sydor M., 2021. Influence of technological parameters on the upholstery seams in furniture. Annals of Warsaw University of Life Sciences SGGW Forestry and Wood Technology, 114(null), 110-115. https://doi.org/10.5604/01.3001.0015.2389.
Ujevič, D., Kovačevič, S., Wadsworth, L. C., Schwarz, I., Brlobašič, B., 2009. Analysis of artificial leather with textile fabric on the backside. Journal of Textile and Apparel, Technology and Management, 6(2).
Vilhanová, A., 2018. Mechanické vlastnosti šitých spojov poťahových textílií. [Mechanical properties of sewn joints of upholstery fabrics, in Slovak] 1. vyd. Zvolen: Technická univerzita vo Zvolene, 2018. 60 p. ISBN 978-80-228-3126-0
Vilhanová, A., Langová, N., Kłos, R., Máchová, E., 2022. The Effect of Selected Factors on the Strength of Stitches of Upholstery Faux Leather. Materials, 15, 6585. https://doi.org/10.3390/ma15196585
Zavec, D., Geršak, J., 2000. Influence of Mechanical and Physical Properties of Fabrics on their Behaviour in Garment Manufacturing Processes 3rd International Conference, Innovation and Modelling of Clothing Engineering Processess–IMCEP. October 11, 13, 115-119.
ACKNOWLEDGMENT
This work was supported by the Scientific Grant Agency of the Ministry of Education, Science, Research, and Sport of the Slovak Republic Grant No. 1/0264/22.
AUTHORS’ ADDRESSES
Ing. Anna Vilhanová, PhD. doc. Ing. Nadežda Langová, PhD. Technical University in Zvolen Faculty of Wood Sciences and Technology, Department of Furniture and Wood Products
T.G. Masaryka 24 960 01 Zvolen Slovak Republic vilhanova@tuzvo.sk langova@tuzvo.sk
ACTA FACULTATIS XYLOLOGIAE ZVOLEN, 66(1): 125 138, 2024
Zvolen, Technická univerzita vo Zvolene
DOI: 10.17423/afx.2024.66.1.10
TECHNOLOGICAL GOODNESS INDEX FOR FURNITURE DESIGN
Anna Jasińska – Maciej Sydor – Grażyna Niedziela – Laura Slebioda
ABSTRACT
Managing an ever-growing number of components is technologically challenging for furniture manufacturers; therefore, minimizing produced components' "dimensional entropy" is necessary. A novel method to assess how dimensional decisions made during furniture design influence the growth of the components' dimensional entropy is proposed in the article The dimensions of each newly designed element were compared to a specific set of preferred dimensions. This approach facilitates furniture design using dimensionally unified components. The Jaccard coefficient for fuzzy sets was employed to achieve it. The obtained similarity score was called the "technological goodness index" (TGI) of furniture.This index can be calculated at three levels: for a group of furniture items, a single piece, and the furniture components. Using the TGI in the CAD, manufacturers gain insight into theirnewlydesignedproducts' "technological" quality. Byanalyzingthisdata,designers can create furniture that boosts production efficiency, promotes productivity, and cost savings.
Keywords: technological quality assessment; standardization; dimensional optimization; technological indexes in the furniture industry; Product Data Management system
INTRODUCTION
Furniture manufacturers tackle the market challenges by offering many sizes for optimal functionality and spatial room fit. Designers consider trends in design, new materials, scientific discoveries in ergonomics and production technology, and (most importantly) customers' requirements expecting unique, non-series furniture (Suandi et al., 2022;Hitka et al., 2024).Theconstantdevelopmentoftechnologycreatestheneedtoexpand existing research activities to optimize the production structure (Grzegorzewska et al., 2020). Computerization in design and production has increased the variety of furniture dimensions available, with shorter production runs for each variation. A typical furniture factory has documented millions or even tens of millions of furniture components from which finished products are made (Gómez et al., 2021).
People have been standardizing the dimensions of artifacts for a long time, as exemplified by ancient and modern canons of the human body and numerous attempts to determine ideal proportions in architecture, sculpture, and painting (Jasińska et al., 2024) Industrial product standardization also comes in many forms (Lu et al., 2020), such as the preferred sizes in a series of products. In 1952, the International Electrotechnical CommissionintroducedtheRenardseries throughRecommendationR3(IEC)to standardize
the ratings of electrical voltages and currents (ISO 3 1973). A similar recommendation also applies to the preferred metric dimensions of products and their components (ISO 17 1973, ISO 497).
Preferred metric product sizes are described by international standards that simplify the use of the metric system in engineering. Examples of standards include the 1-2-5 series, arithmetic sequence, convenient numbers, and many others used in technology (Milton, 1978) In gastronomy, Gastronorm is used (PN-EN 631 1996) in industry Euro container (VDA 4500 standard) and Euro-pallet (set of standards, e.g., (ISO 445 2013) (Rubert et al., 2023). Other standards define the size of preferred metric parts, for example, machine screw sizes, pulley sizes, ventilation pipe diameters, etc.; all are based on Renard's series. The furniture industry uses a non-standardized "system 32" and the standardized basic size module (ISO 2848 1984) for cabinet furniture. All these systems have two beneficial features: they reduce the variety of product dimensions and cause other items to cooperate with standardized products with a reduced variety of sizes.
The problem of material storage costs and production complexity is greater when the production runs are shorter. With large-scale production and frequent changes in produced collections, the issue of the multiplicity of diverse elements is significant. Considering this, reducing the dimensional diversity of products offers several benefits: lower inventory costs, smooth production processes, leverage economies of scale in material ordering, enhanced quality control, improved lead times, and enhanced productivity. However, there are also potential drawbacks to consider. Offering fewer size options might limit the manufacturer's ability to cater to a broader range of customer needs. Standardization can lead to a more homogeneous market, where competition focuses on price rather than unique features. Therefore, it seems that the optimal solution is the dimensional diversification of products, but involving the introduction of dimensionally ordered products.
A limited set of cardinal dimensions can be defined for furniture elements, ensuring consistency with established sizing systems. These systems may include arithmetic sequences, the Renard series, sequences of preferred numbers, the Fibonacci sequence, or any system outlined in technical standards or relevant to the specific technology field. Designing new furniture elements consistently with a chosen "cardinal dimensions" system minimizes the variety of component sizes (dimensional entropy). This, in turn, simplifies productionplanning.Inthisapproach,a"technologicallygood"pieceoffurnitureisdesigned consistently according to a selected design rule. Regardless of the chosen "cardinal dimensions" system, the degree of consistency of its application is essential. "Technological goodness" should be understood as the degree of integrity of a particular piece of furniture or family. The work aims to propose how to define the set of cardinal dimensions of a furniture element and to propose an analytical method for comparing the similarity of this set to the newly designed furniture.
MATERIALS AND METHODS
Interviews conducted with wood technologists and furniture designers show that companies have a problem with too many furniture collections, varieties of furniture piece variants, and produced furniture components. Based on this, it is stated that "technological goodness" can be determined at three levels: a group of furniture items, a single piece, and the furniture components. As a result, the indicator is tripartite, as shown in Figure 1.

Industrial enterprise resource planning software (ERP) assigns unique identifiers (part numbers, or codes) to each component. In this approach, "technological goodness" is understood as striving for the maximum reduction of newly created codes during new furniture design.
Evaluating a furniture item's technological efficiency involves a four-step process: preparing alist ofthecardinaldimensions, selectingtheprincipleofdimensional unification, applying an appropriate mathematical method, and comparing the values of the cardinal dimensions of the furniture with the desired values (Fig. 2).

The first step in the path presented is the selection of cardinal dimensions of the piece of furniture. Cardinal dimensions subject to evaluation, and those not subject to evaluation can be distinguished when determining the technological goodness index. This comparison is depicted in Figure 3.

Fig. 3 Proposal for dividing cardinal dimensions into those not subject to assessment and those subject to evaluation depending on the group of furniture (own work).
In the classical sense, cardinal dimensions fundamentally impact the furniture's functionality and comfort; therefore, they are concerned with the position and dimensions of the user's body when using the furniture. These include, for example, the height and depth of the seat and the height of the backrest or armrests (in the case of chairs, sofas, armchairs, and other seating furniture), the height of the countertop (in tables, desks, kitchen countertops and other furniture with a work surface), the height of the shelves and drawers (in the case of shelves, wardrobes, hanging and standing cabinets, chests of drawers), overall dimensions (width, height, and depth) in the context of the furniture's location in space. The indicated dimensions are somewhat standardized, and knowledge about them is also widely available to furniture customers, i.e., nonspecialist designers (Tilley and Dreyfuss 2001).
Reliable information about them can be found, for example, in anthropometric atlases showing the measurements of the human body and its ranges. The selection of these dimensions should not be assessed due to the adopted ergonomic schemes. Dimensions that are more difficult to choose are those not determined by laws consistent with human anatomy. Such dimensions include, for example, the width of furniture doors, internal divisions, and, therefore, the location of partition walls (in box and frame furniture), the width of the worktop, width, and depth (especially in box furniture), and the thickness of the sections of elements that are not load-bearing elements.
After completing a series of technologically preferred cardinal dimensions suitable forthetechnologyofthe assessedpieceoffurniture,thenextstepistostatethesetofcardinal dimensions of the analyzed piece of furniture. The similarity of the series of technologically preferred cardinal dimensions can be compared with the set of preferred dimensions. This allows for determining the "technological goodness index of the furniture".
There are many methods for comparing the similarity of two data sets and the choice of the appropriate one depends on the specificity of the data whose similarity needs to be compared and the purpose of this analysis. Each method has its uses and limitations. Commonly used methods for assessing the similarity of sets are the Jaccard Index (Costa, 2021), Hamming Distance (Norouzi et al., 2012), Levenshtein Distance (Behara et al., 2020), Dice Index (Ye & Ye 2014), Tanimoto Index (Bajusz et al., 2015), Mahalanobis distance (Durak, 2011), Russell and Rao coefficient (Boyce & Ellison, 2001) and Cosine Similarity Index (Ye, 2011). The entropy of sets is also determined as a measure of diversity, the determination of which is preceded by the segmentation of the set into groups or regions (Jakulin & Bratko, 2004) The Jaccard index is widely used in various types of problems. Its modifications have been created, allowing, for example, to consider the level of relative internality between two compared entities, adding multiple sets, densities, and general scalar fields, and determining the joint interdependence between two random variables (Costa, 2021).
Two sets (classified into fuzzy sets) can be compared based on the Jaccard coefficient. Based on this, an analysis can compare the universe of selected dimensions of the analyzed furniture and the universe of preferred dimensions.
A fuzzy set �� in the universe �� is defined using the equation: ��={(��,��(��)):�� ∈ ��, ����(��)∈[0;1]}, where ����(��):�� →[0;1] is the membership function of the fuzzy set ��, representing the degree of membership of elements in the set �� to the fuzzy set �� (Zadeh 1965). The essence of the fuzzy set concept is to determine the degree of belonging of elements to it. Each element �� ∈�� can fully belong to the fuzzy set ��, not belong to it at all, or belong to it to a certain degree. Accurately assigning degrees of membership to objects in the universe �� ∈�� is often challenging. This operation is typically subjective and contextdependent. The evaluation of the degree of membership of an element in the universe �� ∈�� to the fuzzy set �� depends on the membership function.
Two fuzzy sets �� and �� defined on a specific universe �� are identical if and only if each element of this universebelongs to both sets �� and �� to thesameextent (Łachwa2008) The similarity between two distinct sets, like A and B, can be quantified using a similarity measure. This measure assigns a value between 0 and 1, with 0 indicating no overlap and 1 indicatingidenticalsets. Thesevaluesdescribethedegreeofsimilarity,rangingfromidentity (complete similarity): 1 to complete dissimilarity: 0.
Themost commonly used measureofsimilarity is theJaccard coefficient. Its extension to fuzzy sets is given by (Lin & Lee, 1992): ����,�� = ��(��∩��) ��(��∪��), ��(��∪��)≠0, (1)
Where: �� is any function satisfying the conditions:
1) ��(∅)=0, 2) ��(��)=1, 3) if ��⊂��, then ��(��)≤��(��), where ∅ – represents the empty set, �� – universe.
RESULTS AND DISCUSSION
Two fuzzy sets (A and B) are created to determine a unit's technological goodness index. The sets were created to analyze a kitchen cabinet Polimeb (Fig. 4).

Fig. 4 The analyzed Polimeb kitchen furniture "Furniture with adjustable widths and a variable number of sections", patent application PL439195A1 (own work).
The calculations were performed using a spreadsheet editor (Microsoft Excel, Redmond, WA, USA). The charts were created using R (version 4.3.0*, R Core Team 2023) with the R ggplot2 package (version 3.4.2).
It was assumed that fuzzy sets �� and �� are of the form: ��={(��,����(��)):�� ∈��, ����(��)∈[0;1]}, �� ={(��,����(��)):�� ∈��, ����(��)∈[0;1]},
Where: �� represents the universe, a set of natural numbers from 1 to 143, ����(��) – represents the degree of membership of elements �� ∈�� in fuzzy set ��, Where: �� ∈{��,��}.
For any fuzzy set ��, a membership function is proposed ����(��)=��(����),
Where: ���� - represents the cardinal dimensions of the analyzed Polimeb piece of furniture (listed in Table 2),
��(��) – a function described by the formula: ��(��)=
|�� (����+50)|<∆�� , (2)
Where: �� ∈��+ – the smallest standard dimension, any positive real number, ������+, where ���� denotes the multiple of the standard dimension, ∆�� – specifies the acceptable deviation of a dimension from the standard dimension.
For any fuzzy set ��, a membership function is proposed ����(��)=��(����), where ���� – the dimensions recognized as a standard. It can be observed that ����(��)=1 for every �� ∈��. Thus, the equality holds: �� ={(��,1):�� ∈��,}
The graph of the function ��(��) described by formula (1) is presented in Figure 5.

Fig. 5 The graph of the function ��(��) described by formula (1).
Assuming that the standard dimensions are multiples of the number 100 (�� =100), the function ��(��) takes the form:
1 for |�� 100��|<∆��
50 2∆��(�� 100�� ∆��)+1 for 100��+∆�� ≤�� ≤100��+50 ∆��
50 2∆��(�� 100��+50 ∆��) for 100�� 50+∆�� ≤�� ≤100�� ∆��
for |�� (100��+50)|<∆�� (3)
Additionally, if ∆�� =0 mm. the form of the function ��(��) is as follows:
50(�� 100��)+1 for 100�� ≤�� <100��+50
50(�� 100��+50) for 100�� 50≤�� <100�� ; (4)
if ∆�� =1 mm, function ��(��) takes the form:
for |�� 100��|<1
48(�� 100�� 1)+1 for 100��+1≤�� ≤100��+49
48(�� 100��+49) for 100�� 49≤�� ≤100�� 1
for |�� (100��+50)|<1 ; (5) if ∆�� =10 mm, function ��(��) is as follows:
for |�� 100��|<10
30(�� 100�� 10)+1 for 100��+10≤�� ≤100��+40
30(�� 100��+40) for 100�� 40≤�� ≤100�� 10
for |�� (100��+50)|<10 . (6)
Figure 6 shows the graphs of the functions f described by formulas (3), (4), (5) and (6).

Fig. 6 Plots of the functions �� described by formulas (3), (4), (5), and (6), assuming that the standard dimensions are multiples of the number 100 and that the acceptable dimension deviation from the standard dimension is respectively at levels: a) ∆��, b) ∆��=�� mm, c) ∆��=�� mm, d) ∆��=���� mm.
The similarity measure was determined based on the extended Jaccard coefficient for fuzzy sets.
It was assumed that the function �� takes the form: ��(��)=∑ ����(����) �� ��=1 |��| for���� ∈��, (7)
Where: |��| – denotes the cardinality of the universe.
It can be noticed that the function in the form of (7) satisfies all the conditions required for any function �� contained in formula (1).
The calculated similarity measure values for the considered sets �� and ��, depending on the acceptable deviation of a dimension from the standard dimension, are presented in Tab. 1
Tab. 1 Similarity measure values for the considered sets A and B, depending on the acceptable deviation of a dimension from the standard dimension.
Based on the results of the similarity measure, it can be seen that for the analyzed Polimeb furniture, with the increase in the acceptable deviation of the dimension from the standard dimension, the similarity of fuzzy sets A and B increases.
Assuming that the dimensions of the furniture under consideration are in the range [100�� 25,100��+25], meaning it is ±25 of the standard dimension, the values of the function ��(��) and the values of the membership function ����(��) increase with the increasing value of the acceptable dimension deviation from the standard dimension ∆��
On the other hand, when the dimension of the analyzed furniture falls within the range [100��+25,100(��+1) 25], meaning it is more than 25 away from the standard
dimension, the values of the function ��(��) and the values of the membership function ����(��) decrease with the increase in the value of the acceptable deviation of the dimension from the reference dimension ∆�� (Tab. 2)
Tab. 2 Cardinal dimensions of the analyzed Polimeb piece of furniture (����), standard dimensions (����) and results obtained by applying functions �� described by formulas (4), (5), and (6).
,28}
����{29,30,31,32}
����{106,107,...,123}
����{124,125}
����{126,127,128,129}
����{140,141}
����{142,143}
Thetechnological goodness indexforagroupofproducts canbedetermined similarly to the individual one, with the appropriate designation of universes It is suggested that dimensions from set A, which show low similarity to dimensions from set B, should be corrected at the early stages of the design process. The acceptable minimum degree of similarity can be determined individually, and the number of designed dimensions below the acceptable level relative to all evaluated dimensions indicates the degree of integration with preferred dimensions.
Determining the third type of technological goodness index supports assessing the functionality of created databases and production management systems. For the database to be helpful, it is crucial to establish uniform data standards, specifying the appearance of product codes, units of measurement, and data formats. The developed database is integrated withtheexistingEnterpriseResourcePlanning(ERP)internalsystem This ensures asmooth exchange of information between various sectors of the company. Additionally, it has to specify who has access to particular parts of the database and how changes are made. The critical steps in creating a central database in the furniture industry are shown in Figure 7.

Each technological operation, component, and finished product receives an alphanumeric code. They are created according to a pattern but not necessarily unified. The unification aims to facilitate identifying, managing, and exchanging information about furniture products between various entities, such as manufacturers, suppliers, furniture stores, and e-commerce platforms. Unified codes in the context of data management systems such as databases provide easier identification and tracking. These tools facilitate quick record location, making them invaluable for large datasets. Unified codes facilitate interoperability and information exchange between different platforms or applications in cases where data is shared across various systems. Conflicts and redundancies are avoided with unified, non-duplicate codes. Ensuring the consistency and transparency of the system, in turn, affects the quality of data. The search time is reduced, which speeds up access to the necessary information.
Figure 8 on the left shows an illustrative design made in Top Solid, using libraries of connectors and components; on the right is the same piece of furniture with assigned color attributes of individual elements following the recommended methodology. The final color versions are combined under one code as a variant. When importing a file from Top Solid, an app window allows users to review the codes selected by the system, identify those to be created as new ones, and understand how the design considers color configuration
characteristics and their subsequent propagation. Users can reconsider the import, correct the design in Top Solid, and start the import process again.

Fig. 8 Illustrative design made in Top Solid, using libraries of connectors and components and a view of the furniture with assigned color attributes of individual elements (Fide materials).
The technological goodness index for codes (Ic) can be determined by calculating the ratio of the number of newly created codes (c) to the total number of codes presented in the product list (C):
Ic = �� �� where: c– the number of newly created codes C– the total number of codes.
The lower the index score is, the lower the variety of codes and the reduction of their excessive number in the system is.
As mentioned, increasing components' commonality through standardization programs reduces manufacturing costs (Kota & Miller, 2000). The degree of commonality index provides a way to directly relate the degree of component commonality to various dependent variables such as total cost, work center load, and delivery performance (Collier, 1981). Thorsten andAbdelkafi (Blecker& Abdelkafi,2007)reviewthecommonalityindices developed and identify their limitations in evaluating component commonality for mass customization. The authors propose a new commonality index called the Total Commonality Index (TCI) that considers generic bills-of-materials for mass customization. The TCI considers common components, must-generic items, and options to evaluate the overall commonality of a product family. It shows that an increase in common components and must-generic items leads to a significant improvement in commonality. However, product options have a minor contribution to commonality. The method proposed in this article has an advantage over previous indexes thanks to its universality. It can be used at the level of furniture sets, individual pieces of furniture, and their components. Its fundamental advantage is that it supports the design of technologically similar components.
CONCLUSION
Furniture manufacturer constantly add new furniture variants to their offer, which has the disadvantage of using an extensive and continuously increasing number of dimensional variants of furniture components. These variants exist as digital mock-ups of the products (Model-Based Definition) in the ERP production system and could be successfully used in newly designed furniture. However, designers constantly generate new parts in practice, sometimes duplicating previously produced ones. It is better not to increase the number of these elements excessively.
No indexes were found to determine the rationality of the dimensional decisions made Some of the dimensional choices are permanent and unchangeable because of the current anthropometric characteristics of humans. Humans make other decisions that may be non-fully technological without an appropriate selection path. Recognizing this problem was the determinant for creating the tripartite index of technological goodness. The created index of technological goodness determines the degree of consistency in applying the selected design rule (selection of dimensional values from a specified numerical sequence or its multiples). Technological goodness can, therefore, be assessed at three levels: dimensional integrity within the universe of preferred dimensions for a single furniture unit or group of furniture, mutual similarity of furniture groups, and similarity of furniture codes
The"technological goodness index"proposedhas contributions acrosstheory,science, and practice in furniture design.
1. In the field of theory, the index bridges the gap between aesthetics (pleasing dimensions) and technological efficiency (reduced production complexity). This contributes to a more unified theory of furniture design that considers both user experience and production realities.
2. In science, the index offers a new quantifiable metric to evaluate furniture design based on production efficiency and part optimization (a novel metric for Design Evaluation). This can be used in research to study the relationship between design choices and their manufacturing implications.
3. In practice, by incorporating the index into the design process, furniture manufacturers can create designs that are both aesthetically pleasing and productionfriendly. This can lead to cost savings, reduced waste, and potentially faster production times. Using the index in employee incentive systems could motivate designers to consider both aesthetics and production efficiency in their work. Integrating the index with online furniture self-design platforms could guide customers towards dimensionally efficient choices, potentially streamlining the design and ordering process.
Overall, the "technological goodness index" appears to be a valuable tool that can improve the theory, science, and practice of furniture design by promoting designs that are both aesthetically pleasing and technologically efficient.
Further research aims:
Validation the effectiveness of the index in achieving its goals. This could involve testing it with designers and manufacturers to see how it impacts design decisions and production outcomes.
Integration with existing design software to provide real-time feedback on the technological goodness of a design.
Finding the right balance between aesthetics and efficiency. The index should not solely dictate design choices but rather be a tool to inform the design process.
Addressing these considerations can further develop and refine the "technological goodness index" to contribute to furniture design.
REFERENCES
Bajusz, D., Rácz, A., Héberger, K., 2015. Why is Tanimoto index an appropriate choice for fingerprint-based similarity calculations?.J Cheminform 7(20). https://doi.org/10.1186/s13321-015-0069-3
Behara, K. N. S., Bhaskar, A., Chung, E., 2020. A novel approach for the structural comparison of origin-destination matrices: Levenshtein distance. Transportation Research Part C: Emerging Technologies 111: 513-530. https://doi.org/10.1016/j.trc.2020.01.005
Blecker, T. and Nizar A., 2007. The Development of a Component Commonality Metric for Mass Customization. IEEE Transactions on Engineering Management 54(1):70–85. https://doi.org/10.1109/TEM.2006.889068
Boyce, R. L. and Ellison P. C., 2001. Choosing the best similarity index when performing fuzzy set ordination on binary data. Journal of Vegetation Science 12(5): 711-720. https://doi.org/10.2307/3236912
Collier, D. A., 1981. The Measurement and Operating Benefits of Component Part Commonality.. Decision Sciences 12(1):85–96. https://doi.org/10.1111/j.1540-5915.1981.tb00063.x
Costa, L., 2021. Further Generalizations of the Jaccard Index. arXiv preprint. https://doi.org/10.48550/ARXIV.2110.09619
Durak, B., 2011. A classification algorithm using Mahalanobis distance clustering of data with applications on biomedical data sets. M.S. - Master of Science, Middle East Technical University.
Gómez, R., José, E., Hernández, E,, Rivera-Gómez, H., Pamucar, D., 2021. Production Planning of a Furniture Manufacturing Company with Random Demand and Production Capacity Using Stochastic Programming. PLOS One 16(6):e0252801. https://doi.org/10.1371/journal.pone.0252801
Grzegorzewska, E., Sedliačiková, M., Behún, M., Drábek, J., 2020. Evaluating the international competitiveness of Polish furniture manufacturing industry in comparison to the selected EU countries. Acta Facultatis Xylologiae Zvolen (62(2)). https://doi.org/10.17423/afx.2020.62.2.14
Hitka, M.,Miklošík, A., Gejdoš, M., Starchoň, P., 2024. Insights into Consumer Preferences and Purchasing Behaviour for Wooden Bed Furniture in Slovakia. Journal of Retailing and Consumer Services 76:103613. https://doi.org/10.1016/j.jretconser.2023.103613
ISO 3. 1973. Preferred Numbers, Series of Preferred Numbers. Geneva, Switzerland.
ISO 17. 1973. Guide to the Use of Preferred Numbers and of Series of Preferred Numbers. Geneva, Switzerland. Geneva, Switzerland.
ISO 445. 2013. Pallets for materials handling. Vocabulary. Geneva, Switzerland.
ISO 497. 2002. Guide to the choice of series of preferred numbers and of series containing more rounded values of preferred numbers. Geneva, Switzerland.
ISO 2848. 1984. Building construction. Modular coordination. Principles and rules. Geneva, Switzerland.
Jakulin, A., Ivan B., 2004. Testing the Significance of Attribute Interactions. P. 52 in Twenty-first international conference on Machine learning - ICML '04. Banff, Alberta, Canada: ACM Press.
Jasińska, A., Sydor, M., 2021. Mebel z regulowanymi szerokościami i zmienną liczbą sekcji / Furniture with adjustable widths and variable number of sections Patent application PL439195A1 Patent Office of the Republic of Poland. https://lens.org/092-608-650-936-226
Jasińska, A., Sydor, M., Hitka, M., 2024 Optimizing Dimensions in Furniture Design: A Literature Review. BioResources 19(3): 4727–48. https://doi.org/10.15376/biores.19.3.4727-4748.
Kota, S.,Sethuraman, K., Miller, R., 2000. A Metric for Evaluating Design Commonality in Product Families. Journal of Mechanical Design 122(4):403–10. https://doi.org/10.1115/1.1320820
Łachwa, A., 2008. ‘Podobieństwo zbiorów’ / ’Similarity of Sets’. OficynaWydawniczaim.AFM. Kraków, Poland.
Lin, C. T. and Lee, C. S. G., 1992. Real-Time Supervised Structure/Parameter Learning for Fuzzy Neural Network. Pp. 1283–91 in [1992 Proceedings] IEEE International Conference on Fuzzy Systems. San Diego, CA, USA.
Lu, Y., Xu, X., Wang, L., 2020. Smart manufacturing process and system automation – A critical review of the standards and envisioned scenarios. Journal of Manufacturing Systems 56, 312325. https://doi.org/10.1016/j.jmsy.2020.06.010
Milton,H., 1978. The SelectionofPreferredMetric Valuesfor Designand Construction. Department of Commerce, National Bureau of Standards: United States. National Bureau of Standards, National Engineering Laboratory, Building Economics and Regulatory Technology Division, Naval Facilities Engineering Command. Washington, United States.
Norouzi, M., Fleet, D. J., Salakhutdinov, R., 2012. Hamming Distance Metric Learning. Advances in Neural Information Processing Systems 2.
PN-EN 631. 1996. Materiały i Przedmioty Stykające Się z Żywnością. Pojemniki Na Żywność. Wymiary Pojemników/ 'Materials and articles in contact with foodstuffs; catering containers; part 1: dimensions of containers'. Polish Standard. Warsaw. R Core Team., 2023. R: A Language and Environment for Statistical Computing. Vienna. https://www.R-project.org/ accesed 25 March 2024.
Rubert, C. K., Cleginaldo, P. De C., Maria, Da G. D. De A., José, G. M. De B., Nilo, A. De S. S., 2023. Development of Automotive Packaging by Applying the QFD Method. Revista de Gestão e Secretariado (Management and Administrative Professional Review) 14(6):10527–48. https://doi.org/10.7769/gesec.v14i6.2391.
Suandi, M. E., Amlus, M. H., Hemdi, A. R., Abd Rahim, S. Z., Ghazali, M. F., Rahim, N. L., 2022. A review on sustainability characteristics development for wooden furniture design. Sustainability 14(14), article 8748. https://doi.org/10.3390/su14148748
Ye, J., 2011. Cosine similarity measures for intuitionistic fuzzy sets and their applications Mathematical and Computer Modelling, 53(1-2): 91-97. https://doi.org/10.1016/j.mcm.2010.07.022
Ye, S., Ye, J., 2014. Dice Similarity Measure between Single Valued Neutrosophic Multisets and Its Application in Medical Diagnosis. Neutrosophic Sets and Systems 6(1).
Tilley, A., Dreyfuss, H. (Eds.)., 2001. The Measure of Man and Woman: Human Factors in Design (Rev. ed) Wiley. New York, USA. Zadeh, L. A., 1965. Fuzzy Sets. Information and Control (8(3)):338–53.
ACKNOWLEDGMENT
The authors thank Professor Krzysztof Moliński for his valuable mathematical guidance while performing this study
AUTHORS' ADDRESSES
MSc. Ing. Anna Jasińska†
Prof. Ing Maciej Sydor, PhD
PoznańUniversityofLife Sciences, Faculty of Forestry and Wood Technology, Department of Woodworking and Fundamentals of Machine Design ul. Wojska Polskiego 28, 60-637 Poznań, Poland anna.jasinska@up.poznan.pl maciej.sydor@up.poznan.pl
MSc. Ing. Grażyna Niedziela
MSc. Laura Slebioda
Poznań University of Life Sciences, Faculty of Agriculture, Horticulture and Bioengineering, Department of Mathematical and Statistical Methods ul. Wojska Polskiego 28, 60-637 Poznań, Poland grazyna.niedziela@up.poznan.pl laura.slebioda@up.poznan.pl
ACTA FACULTATIS XYLOLOGIAE ZVOLEN, 66(1): 139 149, 2024
Zvolen, Technická univerzita vo Zvolene
DOI: 10.17423/afx.2024.66.1.11
SIMULATION OF A COMPARTMENT FIRE EFFECT ON A LOADBEARING WALL MADE OF STRAW
Ľudmila Tereňová – Dominik Špilák – Katarína Dúbravská –Jaroslava Štefková
ABSTRACT
Natural materials, including straw, are increasingly becoming more popular in the construction industry. Load-bearing external walls made of straw bales demonstrated remarkable fire resistance results according to tests carried out abroad. The aim of the paper was to determine the ability of a representative sample of a load-bearing external wall made of straw to withstand the effects of a compartment fully developed fire by simulation using the ANSYS modeling program. The program primarily uses mathematical modeling methods for a virtually created model. The simulation results showed that under the stress of a compartment fully developed fire, a charred layer is gradually formed on the surface of a straw structure, which protects the remaining construction for an expected fire resistance of 120 minutes. The ANSYS program simulation results were comparable to the test performed in an authorized test laboratory.
Keywords: load-bearing wall made of straw; compartment fully developed fire; simulation; fire resistance
INTRODUCTION
Current lifestyle trends, especially in housing, indicate a preferred return to natural housing (Loučanová et al., 2023). Straw as a building material deserves considerable attention in the modern era of building sustainable creation as a natural, energetically, and environmentally sustainable material. (Džidic and Milíčić, 2017). By insulating houses with straw bales, passive house standards can be achieved. Straw walls are generally made of straw bales with subsequent treatment that may include clay, cement, and hardwood as an additional thermal insulation layer (Tlaiji et al., 2022). The requirements for mechanical and physical properties are determined by the density of the materials (Konečný et al., 2013) The density of straw bales has an influence on the thermal insulation properties of the external walls. This means that as the density increases, the coefficient of thermal conductivity also increases, which has the effect of reducing the thermal insulation properties of the structure. The same relationship exists between humidity and thermal insulation properties, which change over the course of the year.
The density of straw bales used as building material depends on the function they perform. There are two different construction systems for straw bale walls. The first system is presented by a load-bearing wall made of straw bales, which directly transfers the roof's
weight through the straw bales to the foundations. Such a wall is also called a load-bearing straw wall. If the structure is made of bales that perform a load-bearing function, the recommended bulk density is 90-120 kg.m-3 (Konečný et al., 2013). King (2006) gives a more specific value of 130 kg.m-3. The second construction system is a skeleton construction, usually made of wood, filled with straw bales, or made with an extended shell made of straw bales. If straw bales are used as filling material, i.e., they do not perform a load-bearing function, their volume density is around 70 kg.m-3 (King, 2006).
Straw bales are used to construct self-standing straw houses or as the main insulating and filling material of wooden constructions. Like all other buildings, buildings made of straw bales must also meet the fire safety requirement. Research in the field of straw construction shows that straw bale walls can meet the required fire resistance requirements.
Fire resistance is an unexpected property of straw bales because straw is highly flammable, whereas straw bales can provide fire resistance comparable to traditional building materials (Cascone et al., 2019).
This fact is also confirmed by Teslík (2021), who describes fire tests performed on non-plastered straw bales with a density of 90 kg m-3 to 150 kg/m-3. It was concluded that the bale of straw would be classified in fire reaction class E according to STN EN 135011:2019.
However, if the structure made of straw bales is plastered, it achieves more favorable results compared with non-plastered construction. Such a construction was tested in an authorized PAVUS testing laboratory and, as stated by Růžička (2021), based on the tests performed, the construction reached a fire resistance of REI 120 min.
Cascone et al. (2019) claim thattheincreased fireresistanceofstrawbales is attributed to the plaster applied to the structure, as it provides an insulating barrier against the heat source and oxygen access to the straw. As the reason for the thermal stability of straw bales, Marković and Milić (2018) point out the lack of oxygen in the bale, which prevents the straw from ignition. The amount of oxygen can also be reduced by suitable compression of the stalks. Themore thestalks are compressedin a bale,thelessspaceis leftforair(Theis, 2003; and Džidic and Milíčić, 2017).
The aim of the contribution is to point out the temperature behavior in different layers of the building construction made of load-bearing straw when loaded with the effects of an internal fire. Temperature curves are obtained from the simulation in the ANSYS program (ANSYS, Inc., Canonsburg, Pennsylvania, U.S.). The validity of the simulation results will be confirmed by comparison with those obtained in the authorized PAVUS test room.
MATERIAL AND METHODS
Modelling methodology
Thesubject oftheinvestigationis theassessmentoftherequirements forfire resistance of a structural element of the external wall made of load-bearing straw. The structural element is made of straw bales, on which clay plaster is applied. The time during which the sample can withstand a compartment fully developed fire following STN EN 13 501-2:2023 is assessed. The sample is loaded with temperature according to the standard temperature curve, representing the conditions of a fully developed fire inside a building. The course of this curve is determined according to the equation: �� =345log10(8��+1)+20 (1)
Where: t is the time from the start of the test, which is expressed in minutes (STN EN 13 501-2, 2023).
Simulation in the program ANSYS (ANSYS, Inc., Canonsburg, Pennsylvania, U.S.) can help us verify the behavior of a real or imaginary object The ANSYS program primarily uses mathematical modeling methods for a virtually created model.
The subject of the test is a load-bearing wall sample made of wheat straw bales laid flat. The sample has dimensions of 1600 mm x 1200 mm x 600 mm (width x height x thickness) and has the following composition:
• multi-layer clay plaster with a total thickness of approximately 50 mm,
• A load-bearing layer of straw bales with a thickness of 500 mm is placed on top of each other in three layers. The bales are placed on the lower bond beam and mounted on four guiding rods with a thickness of 40 mm. After the third layer, the upper bond beam is installed, and the wall is tightened with tightening belts. In the upper bond beam, there are four holes for inserting rods with a thickness of 40 mm and a length of 800 mm in the axis of the straw wall.
• external earthen plaster of 50 mm thickness with the addition of horse dung, shredded hay, and sand.
Cross and Longitudinal sections of the examined sample are shown in Fig. 1.

Longitunidal section

Fig. 1 Cross section and Longitudinal section through a straw bale wall. 1 – lower bond beam, 2 – straw bale, 3 – vertical rod in the axis of the wall, 4 – guiding pin, 5 – upper bond beam, 6 – earthen/clay plaster
The data needed for modeling
To verify if fire resistance requirements were met, the input data on the materials forming the construction and their properties are necessary. Tab. 1 shows the properties of materials thatcomposea strawbalewall; theircharacteristics includethickness, specificheat capacity, thermal conductivity, and density.
Tab. 1 Properties of the constituent building materials (Růžička and Pokorný, 2021).
1 Earthen plaster (exterior)
2 Straw bale (flat laid)
Geometry and discrete modeling
The finite element model (FEM) was created in the "SpaceClaim" environment (ANSYS, Inc., Canonsburg, Pennsylvania, U.S.) and was simplified to the straw bale wall model and simple radiation panel without small structures and the environment. Their absence did not affect the simulation results and speeded up the calculations. "Patch Conforming Method" was applied to create the straw bale wall and radiation panel mesh. The hexahedral mesh with an element size of 20 mm was created for the wall, while the hexahedral mesh with an element size of 10 mm was created for the radiation panel. A total number of 62,179 elements and 274,358 nodes for the straw bale wall were generated. The connection area in the model was created manually, representing the thermal connection between the radiation panel and the thermally loaded surface of the straw bale wall. Fig. 2 shows an automatically generated finite element mesh.

Validation of the model
The designed FEM of the load-bearing straw wall plastered with clay plaster was verified using data from the test that took place in the Czech Republic in the fire test room in Veselí nad Lužnicí PAVUS, Plc., which is accredited by the Czech Institute for Accreditation, where a similar fire resistance test of a load-bearing wall made of straw bales (thickness 500 mm) plastered with clay plaster from the inside (thickness 50 mm) and the outside (thickness 30 mm) was performed. The temperature in the furnace increased according to the standard temperature curve, identically to the development in our model.
Fig. 9 compares the temperatures measured in PAVUS and the temperatures recorded during the simulation in the section behind the internal clay plaster.
RESULTS AND DISCUSSION
A simulation of the fire load of a structure was carried out. The temperature of which increased using a standard temperature curve. The temperature curves were evaluated at several layers - on the surface of the clay plaster on the exposed side, in the layer between the clay plaster and the straw bale, and at one-third of the thickness from the clay plaster. The behavior of the materials and load-bearing elements in the structure was observed. Fig. 3 illustrates the temperature profile of the straw wall sample in the ANSYS program from the beginning of the simulation for 150 minutes. The temperature profile of the simulated fire load shows that the temperature on the unexposed side of the sample did not rise.

Results for the clay plaster surface on the exposed side
Thefirstlayerofthestrawwallwas createdby clayplaster,whosetemperaturereached 1078°C in the 150th minute of the test (Fig. 4). We can assume that as the temperature rose, the clay plaster burned and cracked, creating cracks through which air could penetrate under the plaster. This fact is also reported by Janowska-Renkas et al. (2022), who state that firing the clay plaster changes its structure, which creates cracks in it. Garas et al. (2009) observed the behavior of straw samples stressed by fire, plastered with cement, lime, and sand plaster; in the 25th min., they noted the formation of cracks on the exposed side of the sample from which visible smoke was escaping. During the simulation, it was observed that the clay plaster turned into ceramic and formed a non-combustible layer. The plaster represented a certain insulating barrier (Růžička, 2021; Cascon et al., 2019; Theis, 2003; Li et al., 2023) against the heat source and oxygen access to the straw.
(min)
Fig. 4 Temperature development on the clay plaster surface depending on time.
Results for the layer between the clay plaster and the straw bale
The temperature rise between the clay plaster layer and the straw bale is recorded in Fig. 5. After the end of the simulation, the temperature at this point reached a value of 869.96°C.
Fig. 5 Temperature development in the layer between the clay plaster and the straw bale
At the same time, we can state that up to the 20th minute, the structure of the external wall behaved as a structural element of type D2 (the combustible material inside the sample must not reach the ignition temperature). Since the temperature in this layer has reached the flash point of the straw, i.e., more than 310°C, we can consider this composition only as a structural element of type D3. If burning occurs, the straw undergoes pyrolysis or combustion reactions. The pyrolysis of wood materials is equivalent to the sum of the pyrolysis reactions of each component in the order of hemicellulose, celluloses, and lignin (Aleń et al., 1996). The main reaction temperatures are 210–320 °C, 310–390 °C, and 480–510 °C (Greenhal et al., 2012; Wu et al., 2009). The reaction sequence of straw combustion is the same as that of wood pyrolysis (Li, 2023).
Figure 6 shows the temperature profile between the clay plaster and the straw bale.

Fig. 6 Temperature profile between the clay plaster and the straw bale.
Results for the 1/3 of thickness from the clay plaster
In one-third of the thickness of the straw bale from the clay plaster, the temperature reached 161.51°C in the 150th minute, i.e., approximately half of the ignition temperature of the straw. Fig. 7 shows the temperature profile for a distance of 1/3 of the thickness from the clay plaster.

Fig. 7 Temperature profile for one-third from the clay plaster.
Asmentionedabove,in addition to theplaster as an insulating barrier,the compression of the straw into the bale affects the fire resistance. Compressing the straw into the block significantly reduces the amount of oxygen, thus limiting one of the components of the burning triangle (Theis, 2003). The mentioned aspects are the reasons for the lowtemperature values (Fig. 8) measured in one-third of the thickness of the straw bale from the clay plaster exposed to the fire's effects.
Fig. 8 Temperature development in one-third from the clay plaster.
The difference in temperature behavior in the individual examined layers of the test composition of the load-bearing straw wall is recorded in Fig. 9. The highest temperature on the surface of the plaster reached 1078°C; 870°C in the layer between the plaster and the straw bale, and just under 162°C in one-third of the thickness of the clay plaster.

On the unheated side of the sample, the temperatures were much lower than the temperatures measured in one-third of the thickness from the clay plaster. This means that the examined sample would maintain thermal insulation criterion Iduring the entire duration of the model fire (the average temperature on the unexposed side of the structure must not increase by more than 140 °C according to STN EN 13 501-2:2023).
We assume that the integrity of sample E on the exposed side was violated because, at the 20th minute, the ignition temperature of the straw in the layer between the clay plaster and the straw bale was exceeded (the measured temperature was 350.33°C).
Based on the obtained results, it can be assumed that during the entire duration of the test, the load-bearing and stability criterion R will also be preserved. Therefore, the structure
underinvestigation could beclassifiedas 15REI/D2or120(150)bySTNEN13 501-2:2023 REI/D3.
Thecomparison ofthetemperatures duringthetest in theauthorized PAVUS test room and the output from the simulations is shown in Fig. 10. The temperature curves are compared in the part behind the internal clay plaster, and the temperature rises steadily. The graph in Fig. 10 shows that there is only a negligible difference between the values from PAVUS and the simulation results, and the measured and predicted values largely overlap. Comparing the simulation results and the results from PAVUS suggests that the model is validated and usable for further simulations.

Fig. 10 Comparison of temperatures in validation.
Marković and Milić (2018) describe the results of the experiment by Grelat (2004), which was carried out in France and achieved remarkable results. The experiment was carried out on a wooden structure filled with straw bales with dimensions of 1.85 x 1.9 x 0.4 m. The authors (Marković and Milić, 2018) described the above experiment as follows: The surface of the wall exposed to the fire load is plastered in two layers with lime plaster 2 cm thick over the plaster strip, while the other side is plastered with the addition of chopped hemp as a binder in the lime plaster. The thickness of the straw bale layer in the wall was 36 cm. The model is equipped with thermometers that measure the temperature in the wall and are placed on the surface of the exposed wall and inside the construction. The wall was subjected to a fire load for 85 minutes with a temperature of 800 °C on the fireloaded side. Temperatures measured inside the structure (in the straw layer) did not exceed 200 °C. The construction did not collapse during the test, and its load-bearing capacity was not impaired (Marković and Milić, 2018).
CONCLUSION
A simulation of fire load on a structure made of straw bales was performed. The temperature was set according to a standard temperature curve. The simulation result met expectations as the straw wall resisted the fire for more than 120 (150) minutes. On the unexposed side of the sample, the temperature increased only slightly during this time, and there was no integrity violation. By adhering to the mentioned fire resistance criteria, it can be assumed that the load-bearing and stability criteria of the structure will also be adhered
to. According to STN EN 13 501-2:2023, the investigated structure can be classified as 15 REI/D2 or 120 (150) REI/D3. Based on the comparison of the simulation results and the results from the authorized PAVUS testing laboratory, the model can be considered valid and usable for further simulations.
At the same time, the results of the simulation revealed that the plaster covered the structure from the exposed side for approximately 20 minutes and created an insulating barrier against the heat source and oxygen access to the straw. Then, the plaster starts to crack. After the integrity is broken, straw bales behave like solid wood, meaning the outer surface burns and creates char, protecting the other fibers below the surface from the flames. Such behavior is evidenced by the temperatures measured during the simulation in 1/3 of the thickness of the straw bale from the clay plaster.
REFERENCES
Aleń, R., Kuoppala, E., Oesch, P., 1996 Formation of the main degradation compound groups from wood anditscomponents duringpyrolysis. Journal ofAnalytical andApplied Pyrolysis 36,137148. https://doi.org/10.1016/0165-2370(96)00932-1
Cascone,S.,Rapisarda,R.,Cascone,D.,Physical propertiesofstrawbalesasa constructionmaterial: A review. Sustainability 11, 3388-3407. https://doi:10.3390/su11123388
Department of Applied Mechanics. URL https://www.mm.bme.hu/ (accessed on 20 April 2021)
Džidić, S., Miličić, I. M., 2017 Fire resistance of the straw bale walls, in: 5th International Conference Contemporary Achievements in Civil Engineering. Subotica, pp. 423-432. htttps://doi:10.14415/konferencijaGFS2017.044
Garas, G., Allam, M., Mamdouh, K., 2009. Straw bale fire test on cement plaster mixes. Safety and Security 108, 51-59. https://www.witpress.com/Secure/elibrary/papers/SAFE09/SAFE09006FU1.pdf
Greenhalf, C., Nowakowski, D., Bridgwater, A., Titiloye, J., Yates, N., Riche, A., Shield, I., 2012 Thermochemical characterisation of straws and high yielding perennial grasses. Ind Crops Prod 36, 449–459. https://doi.org/10.1016/j.indcrop.2011.10.025
Grelat, A., 2004. Utilisation de la paille en parois de maisons individuelles a ossature bois; Extraits duRapportfinalteslíkTome2–ExpérimentationsenlaboratoireInstrumentationinsitu.Centre d'expertise du bâtiment et des travaux publics, SaintRémylèsChevreuse,URLhttps://amper.ped.muni.cz/~{}jhollan/letters/straw/pdfBwxFwYWDV G.pdf (accessed on 22 February 2022)
Janowska-Renkas, E., Król, A., Pochwala, S., Palubski, D., Adamska, M., Klementowski, I., 2022. The fire resistance and heat conductivity of natural construction material based on straw and numerical simulation of building energy demand. Energies 15, 1155-1173. https://doi.org/10.3390/en15031155
King, B., 2006. Design of Straw Bale Buildings: The State of the Art. 1st edn. ed. Green Building Press, San Rafael.
Konečný, P., Teslík, J., Hamala, M., 2013. Mechanical and physical properties of straw bales. Advanced Materials Research 649, 250-253.
Li, Y., Zhu, N., Chen, J., 2023. Straw characteristics and mechanical straw building materials: a review. Journal of Material Sciences 58, 2361-2380. https://doi.org/10.1007/s10853-02308153-8
Loučanová, E.,Olšiaková,M.,Nosáľová,M.,Paluš,H.,2023.Perception of selected types of family houses with regard to wood-based structures. Acta Facultatis Xylologiae Zvolen 65, 147-160. https://doi: 10.17423/afx.2023.65.1.13
Marković, V., Milić, M.,2018. Thermal insulation properties and fire resistance of walls with straw bale filling, Contemporary achievements in civil engineering. Subotica, pp. 297-304. https://www.gf.uns.ac.rs/~zbornik/doc/NS2018.29.pdf
Růžička, J., Pokorný, M., 2021. Current Research of Fire Resistance of Straw Bale Structures, CTU in Prague, Praha.
STN EN 13501-1, 2019. Klasifikácia požiarnych charakteristík stavebných výrobkov a prvkov stavieb.Časť1:Klasifikáciavyužívajúcaúdajezoskúšokreakcienaoheň [Classification of fire characteristics of building products and building elements. Part 1: Classification using reactionto-fire test data]
STN EN 13501-2, 2023. Klasifikácia požiarnych charakteristík stavebných výrobkov a prvkov stavieb. Časť 2: Klasifikácia využívajúca údaje zo skúšok požiarnej odolnosti (okrem ventilačných zariadení) [Classification of fire characteristics of building products and building elements. Part 2: Classification using data from fire resistance tests (excluding ventilation equipment)].
Teslík J., 2021. Analysis of the fire properties of blown insulation from crushed straw in the buildings. Materials 14. https://doi.org/10.3390/ma14154336
Theis, B., 2003. Straw bale fire safety. Ecological Building Network.
Tlaiji, G., Biwole, P., Ouldboukhitine, S., Pennec, F., 2022. A Mini-Review on Straw Bale Construction. Energies 15. https://doi.org/10.3390/en15217859
Wu, Y-M., Diao-Cens-Li, Li-Hai_Bin, He-Fang, 2009. Low temperature pyrolysis characteristics of major components of biomass. Journal of Fuel Chemistry and Technology 37, 427-432. https://doi.org/10.1016/S1872-5813(10)60002-3
ACKNOWLEDGMENT
This work was supported by the Slovak Research and Development Agency under the Contract no. APVV-22-0030.
AUTHORS’ ADDRESSES
Ing. Ľudmila Tereňová, PhD.
Ing. Dominik Špilák, PhD.
Ing. Katarína Dúbravská, PhD.
Technical University in Zvolen, Faculty of Wood Sciences and Technology, Department of Fire Protection
T. G. Masaryka 24 960 01 Zvolen ludmila.terenova@tuzvo.sk xspilakd@is.tuzvo.sk katarina.dubravska@tuzvo.sk
Mgr. Jaroslava Štefková, PhD. Institute of Foreign Languages Technical University in Zvolen
T. G. Masaryka 24 960 01 Zvolen stefkova@tuzvo.sk
ACTA FACULTATIS XYLOLOGIAE ZVOLEN, 66(1): 151 159, 2024
Zvolen, Technická univerzita vo Zvolene
DOI: 10.17423/afx.2024.66.1.12
AN ECONOMETRIC MODEL OF TIMBER DEMAND IN THE SLOVAK REPUBLIC
Marek Trenčiansky – Rastislav Šulek
ABSTRACT
Generally, the timber market is affected by several factors that are reflected in the structure of the supplied and demanded quantities of timber assortments. Econometric modelling is widely used to identify and analyse such factors. This paper deals with the development and evaluation of an econometric model of timber demand on the domestic market of the Slovak Republicin themonitoredperiodoftheyears2000 – 2021.Thetimberdemandis determined by two factors: the timber price and GDP. The analysis shows that the raw timber market can be characterized as a regular market with a declining demand curve and a relatively inelastic response concerning price changes. The influence of the GDP factor is more significant, which confirms the theory of the derived demand for wood from the demand for wood products. The results of econometric modelling make it possible to elaborate alternative ex-ante forecasts of timber market development and, as such, they may form the basis for the effective application of different economic and political tools in the forestry and forest-based industry
Keywords: econometric modelling; timber demand; derived demand; quantitative market analysis
INTRODUCTION
The complex of forestry and forest-based industry is one of the important branches of the Slovak economy. Even though the share of forestry in the country's GDP is at the level of 0.7% (Ministry of Agriculture and Rural Development of the Slovak Republic, 2022), forestry forms an important raw material base for the forest-based industry. Based on data from the Green Reports of the Ministry of Agriculture and Rural Development of the Slovak Republic, an average of 8.4 mil. m3 of wood per year was harvested in the years 2020 –2021, which is 1.54 m3 per capita per year. During this period, the average annual export of wood accounted for approximately 25% of wood production, the import of wood accounted for almost 10% of wood production, and the average consumption of wood by forest-based industry represented a volume of almost 7 mil. m3 per year. According to the analysis of wood balance in Slovakia (Parobek et al., 2014), almost 83 % of all resources used in Slovakia originated in forest biomass, 16.1 % were from industry waste, and only 1 % came from used paper. On the other hand, over 84 % of resources were used industrially, while nearly 16 % were used for energy purposes.
Considering the strategies of the forestry and forest-based industries, it is a crucial aspect to know how the timber market would behave depending on the action of numerous
factors and also to harmonize the structure, quantity and quality of the supplied and demanded quantities of timber assortments. To analyse the market and its development as well as to identify and quantify factors influencing such a market, economic and mathematical methods are used. The output of data processing and market analyses are econometric models that provide information for the planning and management process of enterprises running their business within the forestry and forest-based industry.
Modelling timber market in the countries of Western Europe (Koch et al., 2013; Bergen, 2012), of Scandinavia (Brännlund et al., 1983; Toppinen and Kuuluvainen, 2010; Sjølie et al., 2011) and of North America(Adams and Haynes, 1980; Song et al., 2011; Susaeta et al., 2012) is of long-lasting tradition The econometric models of timber demand, compiled using FAO databases on a cumulative basis with subsequent long-term prognoses, are available in the countries of Central and Eastern Europe (e.g., Kangas and Baudin, 2003; Jonsson, 2010) Based on the data of the period of years 1990 – 1995, the timber market equilibrium was analysed for the conditions of the Slovak Republic, while timber supply was determined by the planned volume of timber harvesting and the timber demand was determined by the timber prices and the level of GDP (Smrtník, 1997). Econometric models of the total timber supply and demand constructed following the data from the period of the years1990–2003didnot confirmthetheoreticalhypothesesabouttheeffectoftimberprices – such results being related to the non-standard nature of the market in this period affected by the transformation of the economy, the reliability of the analysed data and the turbulent economic and legislative environment (Trenčiansky, 2005) Models are dominated by nonprice factors that affect demand for timber assortments (Trenčiansky, 2005). Lower impact of price, or even the absence of its impact together with the dominance of non-price factors was also confirmed in the case of models of demand on the wood products market (Hlodák, 2023). Taking into account the econometric models of wood products demand, the theory of derived demand was confirmed (Paluš, 2002), while e.g., the sawn wood demand reflects activity in the construction industry and the economic situation in the country (Paluš et al., 2018). In the broader sense, timber demand is derived from the production parameters of the entire economy Hurmekoski et al., 2015; Borzykowski, 2017). In addition to economic factors, timber demand (resp. timber market) is affected by the (i) tools of forest and other related policies(Hurmekoski and Hetemäki, 2013; Onoja and Idoko, 2012) (ii) demographic changes (O’neill et al., 2010), (iii) customer preferences in the use of wood products, (iv) prices of substitute products (Kangas and Baudin, 2003), and (v) changes in exchange rates (Hurmekoski et al., 2015). The effect of price on demand is determined by calculating price elasticities (Jonsson, 2013). In many cases, price inelasticity of demand on wood and wood products market was confirmed (Trenčiansky, 2005; Simangunsong and Buongiorno, 2011; Michinaka et al., 2011; Hlodák, 2023). The objective of the paper is to build up and evaluate an econometric model of timber demand on the domestic market of the Slovak Republic in the monitored period of the years 2000 – 2021.
Based on the economic theories and the results of the studies from other countries together with the results of previous research in the Slovak Republic, the following hypotheses were defined for the timber market in the Slovak Republic:
H1: The timber demand is a derived demand for wood products,
H2: The timber price is a coordinator in the timber market, thus the timber market in the analysed period is considered to be the standard one,
H3: The timber demand reacts inelastically to changes of the market price and
H4: The effect of non-price factors on the timber demand is more significant than the timber price.
MATERIALS AND METHODS
Each model reflects an abstraction of a real system characterized by its objectives, components, and correlation (Schwarzbauer, 1993). The essence of this paper lies in the estimation of demanded quantities of wood assortments within the analysed time series (2000 – 2021) using linear regression equations. Then, a statistically verified and economically interpretable econometric model of timber demand in the Slovak Republic shall serve as a result of this research.
The constructed econometric model clarified the causal relationships between the variables and, at the same time, the effects of factors on the timber demand in the Slovak Republic were identified and quantified.
Based on the theoretical formulation of the relevant relations, market identification and choice of independent variables together with potential dependent variables, the general notation of the linear equation of the model of timber demand was as follows:
where: Qt - demanded volume of timber within the t-year, f1-k(t) - factors affecting timber demand within the t-year, a - absolute parameter of the model, b - estimated parameters of independent variables, ut - random element of the model within the t-year, k - number of factors affecting timber demand, n - number of observations.
Quantification of the model enabled the calculation of the values of the dependent variables (demanded volume of timber) pursuant to the independent (factors of the demand) To estimate the model parameters, the least-square method was used (Šmelko and Wolf, 1977).
Considering the economic interpretation of the timber demand model, the factors affecting timber demand were evaluated. Moreover, the average relative elasticities of demand were calculated, and the actual and estimated quantities of demanded timber were compared. Finally, the state of timber marked during the analysed period was evaluated. The domestic market volume of demanded timber serves as the econometric model's dependent variable. Considering models of timber demand, the final volume of demanded timber shall be expressed as the domestic timber consumption Q within the t-year (Jonsson, 2010; Paluš et al., 2018)
To identify potential factors that may affect timber demand, the theory of derived demand is taken into account and the following factors are analysed: Gross domestic product (GDP), the value of construction production (VCP), the index of the production of wood and paper products (PWPP), the average domestic price of wood assortments (PD) and export timber prices (PER) as well as the fixed base index of timber prices (ITP). In order to eliminate the effect of inflation, the factors GDP, VCP, ITP were expressed in constant prices. Data on potential factors influencing the timber demand in the Slovak Republic are presented in Tab. 1. When compiling the model, the potential effect of the factors of derived timber demand (GDP, VCP, PWPP) and price factors (PD, PER, ITP) was especially considered. The demand factors were included into the model step-by-step so that the maximum coefficient of determination (and thus the best statistically significant combination of factors) is to be reached, and, at the same time, the conditions of
multicollinearity and autocorrelation of residuals are met. The statistical significance of the estimated equation parameters was tested using the t-test, the coefficient of determination was tested using the F-test, the autocorrelation of the residuals was tested using the DurbinWatson test (DW), and the multicollinearity was tested using the variance inflation factor (VIF). After the quantification and verification of the model of timber demand, the average relative elasticities were calculated in the case of significant factors. The average elasticity of a specific factor was calculated as a relative change in the demanded volume of timber if this factor increases by 1 % within the year t. If such change is higher than 1, reaction is the elastic one. On the contrary, if such change is lower than 1, the impact of such factor is inelastic.
Tab. 1 Potential factors affecting the timber demand in the Slovak Republic (2000 – 2021). Factor
(prices of 2011)
The following sources of input data were used: the Green Reports of the Ministry of Agriculture and Rural Development of the Slovak Republic (Ministry of Agriculture and Rural Development of the Slovak Republic, 2022), the FAOSTAT database (FAOSTAT, 2023) and the Statistical Yearbooks of the Slovak Republic from the years of 2001 – 2022 (Statistical Office of the Slovak Republic, 2023). The final model is the result of an optimal mutual combination of potential factors. When developing the model, also potential independent factorslagged byoneanalysedperiod (t-1)were considered. Statistical analyses were conducted using the STATISTICA software (Statsoft Inc.).
RESULTS AND DISCUSSION
The development of total production, exported as well as imported volume of timber with the domestic timber consumption during the analysed time (2000 – 2021) is shown in Fig. 1. Total timber production during the analysed period varies between 5.7 and 9.6 mil. m3. The total timber supply is determined by the planned volume of harvesting, while it is affected by the accidental felling, especially in the case of coniferous timber assortments. Thetimberexportduringtheanalysedperiodvariesbetween1.1and3.4mil.m3.Thevolume of imported timber has been increasing and in recent years it has reached the level of the volume of timber exports. Domestic wood consumption represents the quantity of demanded timber on the domestic market. The volume of this timber varies during the analysed time series from 4.3 to 8.9 mil. m3. Between the years of 2000 and 2005, a significant growth in domestic consumption can be observed. During the period of years 2005 – 2010, the volume of domestic consumption reached amount between 7 and 7.7 mil. m3. As a result of the recession in the economy in 2008, the domestic timber consumption decreased to the level
of 5.7 mil. m3 by the year of 2013. After this fall, the consumption has started to increase again, and it reached the maximum value at the level of almost 9 mil. m3 during the years of 2018 and 2019. In 2020, drop to the level of 7.1 mil. m3 was recorded, while in 2021, the timber consumption increased once more to the level of 8 mil. m3 .
The econometric model of timber demand identifies and quantifies the factors causing variations in the Slovak Republic domestic timber consumption during the period.
Total timber production
Exported timber Imported timber Domestic timber consumption
Fig. 1 Total timber production, exported and imported volume of timber and domestic consumption of timber in the Slovak Republic (calculation based on the data of the Ministry of Agriculture of the SR during the years 2001 – 2022).
Based on the econometric analysis of the time period of years 2000 – 2021, the equation of timber demand on the domestic market in the Slovak Republic was calculated The resulting parameters of the regression model and the statistical characteristics of the timber demand model and the calculated elasticities of the timber demand model are presented in Tab. 2. The parameters of the econometric model are statistically significant, and they meet the conditions of random component correlation (DW = 1.6) and multicollinearity (VIF = 5.69). The VIF value is slightly over the limit of 5 and one might expect there is a certain level of collinearity. However, it should not negatively affect the accuracy of the model. As it is mentioned by Katz (2006), the values of VIF higher than 10 might significantly affect the model results. The coefficient of determination (R2 = 0.73) proves a high dependence of the demanded amount of timber on the following factors: gross domestic product (GDPt) and average timber prices on the domestic market (PDt).
Tab. 2 Statistical characteristics of timber demand model.
N = 22 R = 0.857 R2 = 0.734 F (2, 19) = 26,27 p<0.00000 DW=1,6 β- Coefficient b STD of b T (1)4 p-value VIF Relative elasticity
As the GDP grows, the consumption of wooden products increases, which causes an increased demand for raw timber. The relatively high value of the β coefficient (0.67) points out the dominant effect of overall economic growth on the timber demand. The rather significant effect of total economic production on the timber demand as well as on the demand for wood products has been observed in several countries (Jonsson, 2010; Bergen, 2012; Hurmekoski et al., 2015; Borzykowski, 2017). Based on the confirmed impact of the GDP, one may confirm the hypothesis H1, that the timber demand is derived from the demand for wood products. The theory of derived demand was confirmed by the studies of many authors (Kangas and Baudin, 2003; Michinaka et al., 2011; Bergen, 2012; Paluš et al., 2018; Hlodák et al., 2022) Taking into account the developed econometric model, an alternative to the factor of GDP is the value of construction production (or production of wood and paper products) The higher construction production, the higher consumption of soft sawnwood particularly – simply, increased construction production causes an increased demand for soft sawnwood. Similarly, as the production of wood and paper products grows, the demand for timber assortments also grows. From a statistical point of view, there is a relatively high dependencebetweenthefactors ofGDP on theonehand andVCP and PWPP, ontheotherhand.Basedonthecomparisonofthecoefficientofdeterminationandfulfilment of the different conditions of the econometric model, the GDP factor was included in the econometric model of timber demand.
The growing average domestic timber prices affect the demanded quantity in a negative way When the price increase by 1 %, the demanded quantity decreases by 0 64 % Based on the mentioned, one may confirm the hypothesis H2 about the price being the coordinator on the timber market. Econometric models built upon the data originating from the 1990s did not confirm the effect of price on the demanded quantity (Trenčiansky, 2005). Most probably, it was caused by the non-standard market associated with the transition to a market economy, land restitution, high inflation and a turbulent economic and legislative environment.
The price factor participates in explaining the variance of the demanded quantity to a lower extent (β = 33%) than the GDP factor. A change in the average timber prices causes an inelastic reaction in the volume of demanded timber on the domestic market. On the contrary, changes of the GDP cause an elastic reaction in the volume of demanded timber (Tab. 2), thus, it seems that the GDP factor has a dominant impact on changes of demanded timber on the domestic market. The results of the analysis confirm the hypothesis H4 about the dominance of the impact of non-price factors (GDP) on the timber demand. At the same time, these results confirm the hypothesis H3 about the inelastic effect of the timber price on the demanded quantity. The actual volume of demanded timber on the domestic market as well as demanded volume calculated according to the econometric model are both presented in the Fig. 2.
Actual volume of demanded timber
Calculated volume of demanded timber
Fig. 2 Actual and calculated volume of demanded timber in the Slovak Republic.
The developed model corresponds to the results of the model built on the basis of the data from the years of 1990 – 1995 (Smrtník, 1997) At that time, the timber demand was a result of the effect of the price as well as the level of GDP. The value of construction production was considered to be an alternative to GDP.
The demand model confirms the hypothesis about the derived demand – the demand in the case of wood processing industries is derived from the total volume of income of economic entities, while, subsequently, the timber demand itself is derived from such demand. In partial markets, e.g. the demand for sawnwood in Slovakia reflected the activity in the construction sector and economic situation in the country (Paluš, 2012). Gross domestic product has an impact on plywood demand and demand for composite materials is dependent on the size of output in the construction industry, the size of housing construction, and output prices in the industry (Hlodák, 2023).
CONCLUSION
The total timber demand is the result of the complex action of a set of price and nonprice factors.
Based on the econometric analysis of the data of time series of the years 2000 – 2021, the model of the overall timber demand on the domestic market in the Slovak Republic was constructed. The dependent variable is the volume of timber demanded in the domestic market Considering the potential factors affecting the change in the demanded quantity, such price factors as the average domestic, export and overall timber prices together with the index of timber prices were analysed Looking at the non-price factors, the following ones were analysed: gross domestic product and the value of construction production. Both are expressed in constant prices for the year of 2015.
Timber demand is derived from the demand for wood products Considering the constructed econometric model, the demanded quantity depends on both, the level of GDP as well as the average timber prices. A change of average timber prices causes an inelastic response, while a change of GDP causes an elastic response of the demanded quantity. The amount of real GDP shall be perceived as the dominant factor. The demand models developed during the 1990s lack the price factor. Based on the results of the econometric analysis, one may conclude that the timber market has been standardized since then.
The compiled econometric model forms the basis for alternative forecasts of market development together with the potential simulation of the behaviour of timber producers and processors, taking into account the impact of the individual supply and demand factors. Based on the knowledge of market factors, market structure, behaviour of market subjects and considering the existence of forecasts of the development of individual economic variables, forestry and forest-based industries may coordinate their strategic goals.
REFERENCES
Adams, D. M., Haynes, R. W., 1980. The 1980 softwood timber assessment market model: structure, projections, and policy simulations. Forest Science, 26(suppl_1), a0001-z0001.
Bergen, V., 2012. Grundlagen der empirischen Marktanalyse, dargestellt am Beispiel eines Rohholzmarktes. Schweizerische Zeitschrift Fur Forstwesen, 163(10). https://doi.org/10.3188/szf.2012.0401
Borzykowski, N., 2017. The Swiss market for construction wood: estimating elasticities with time series simultaneous equations. Genève: Haute École de Gestion de Genève.
Brännlund, R., Johansson, P. O., Löfgren, K. G., 1983. An econometric analysis of timber supply in Sweden.
FAOSTAT., 2023. https://www.fao.org/faostat/en/#data/FO
Hlodák, M., Paluš, H., Rokonalová, A., Glavonjić, B., Slašťanová, K., 2022. Determination of variables for soft sawnwood demand models. Acta Facultatis Xylologiae Zvolen, 64(1). https://doi.org/10.17423/afx.2022.64.1.13
Hlodák, M., 2023. Modelovanie dopytu na trhu s výrobkami z dreva v SR, dizertačná praca, TU vo Zvolene, 184.
Hurmekoski, E., Hetemäki, L., 2013. Studying the future of the forest sector: Review and implications for long-term outlook studies. Forest Policy and Economics, 34, 17–29.
Hurmekoski, E., Hetemäki, L., Linden, M., 2015. Factors affecting sawnwood consumption in Europe. Forest Policy and Economics, 50. https://doi.org/10.1016/j.forpol.2014.07.008
Jonsson, R., 2010. Modelling wood products demand, supply and trade. EUwood-Real Potential for Changes in Growth and Use of EU Forests.
Jonsson, R., 2013. How to cope with changing demand conditions The Swedish forest sector as a case study: an analysis of major drivers of change in the use of wood resources. Canadian Journal of Forest Research, 43(999), 405–418.
Kangas,K.,Baudin,A.,2003.Modellingandprojectionsofforestproductsdemand,supplyandtrade in Europe (Vol. 30). UN.
Katz, M. H., 2006. Assumptions of multiple linear regression, multiple logistic regression, and proportional hazards analysis. Multivariable analysis. A practical guide for clinicians, 2nd edn. Cambridge University Press, 38-67, chapter http://dx.doi.org/10.1017/CBO9780511811692
Koch, S. P., Schwarzbauer, P., Stern, T., 2013. Monthly wood supply behavior of associated forest owners in Austria-Insights from the analysis of a micro-econometric panel. Journal of Forest Economics, 19(3). https://doi.org/10.1016/j.jfe.2013.06.003
Michinaka,T., Tachibana,S., Turner,J.A.,2011.Estimatingpriceandincome elasticitiesof demand for forest products: cluster analysis used as a tool in grouping. Forest Policy and Economics, 13(6), 435–445.
Ministry of Agriculture and rural development of the Slovak Republic. 2001 - 2022. Report on the forest sector of the Slovak Republic. https://www.mpsr.sk/zelena-sprava-2022/123 18463/ O’neill, B. C., Dalton, M., Fuchs, R., Jiang, L., Pachauri, S., Zigova, K., 2010. Global demographic trends and future carbon emissions. Proceedings of the National Academy of Sciences, 107(41), 17521–17526.
Onoja, A. O., Idoko, O., 2012. Econometric analysis of factors influencing fuel wood demand in rural and peri-urban farm households of Kogi state. Consilience, 8, 115–127.
Paluš, H., 2002. Modelovanie dopytu po výrobkoch z dreva na trhu v SR [Modelling of demand for
wood products at the Slovak market]. Technical university in Zvolen. Paluš, H., Parobek, J., Dzian, M., Šupín, M., 2018. Determinants Of Sawnwood Consumption. Slovakia. BioResources, 13(2). https://doi.org/10.15376/BIORES.13.2.3615-3626
Parobek, J., Paluš, H., Kaputa, V., Šupín, M., 2014. Analysis of wood flows in Slovakia. BioResources, 9(4). https://doi.org/10.15376/biores.9.4.6453-6462
Schwarzbauer, P., 1993. Der österreichische Holzmarkt im Modell: EG - WaldsterbenZellstoffmarkt. Eigenverlag des Instituts für forstliche Betriebswirschaft und Forstwirtschaftspolitik. https://books.google.sk/books?id=E2q2AAAAIAAJ
Simangunsong, B. C., Buongiorno, J., 2001. International demand equations for forest products: a comparison of methods. Scandinavian Journal of Forest Research, 16(2), 155-172. https://doi.org/10.1080/028275801300088242
Sjølie, H. K., Latta, G. S., Adams, D. M., Solberg, B., 2011. Impacts of agent information assumptions in forest sector modeling. Journal of Forest Economics, 17(2). https://doi.org/10.1016/j.jfe.2011.02.009
Šmelko, Š., Wolf, J., 1977. Statistical methods in forestry. (Štatistické metódy v lesníctve). Príroda, 330.
Smrtník, J., 1997. Rovnováha na trhu s drevom v SR a faktory trhovej a cenovej rovnováhy. Lesdrevo-životné prostredie [Balance on the timber market in the Slovak Republic and factors of market and price balance] Technical university in Zvolen, 9–13.
Song, N., Chang, S. J., Aguilar, F. X., 2011. U.S. softwood lumber demand and supply estimation using cointegration in dynamic equations. Journal of Forest Economics, 17(1). https://doi.org/10.1016/j.jfe.2010.07.002
Statistical office of the Slovak Republic. 2023. https://datacube.statistics.sk/#!/lang/sk/?utm_source=susr_portalHP&utm_medium=page_data base&utm_campaign=DATAcube_portalHP
Susaeta, A., Lal, P., Carter, D. R., Alavalapati, J., 2012. Modeling nonindustrial private forest landowner behavior in face of woody bioenergy markets. Biomass and Bioenergy, 46. https://doi.org/10.1016/j.biombioe.2012.07.018
Toppinen, A., Kuuluvainen,J., 2010. Forest sectormodellingin Europe-the state of the art and future research directions. Forest Policy and Economics, 12(1). https://doi.org/10.1016/j.forpol.2009.09.017
Trenčiansky, M. 2005. Dynamika trhu so sortimentmi dreva v SR [Dynamics of the wood assortment market in the Slovak Republic] Technical university in Zvolen ISBN 80-2281544-6
ACKNOWLEDGMENT
The authors would like to thank the Scientific Grand Agency of the Ministry of Education, Science, Research and Sport of the Slovak Republic and the Slovak Academy of Science. The paper was elaborated within the framework of Grant project VEGA 1/0376/23 “Economic and legal conditions of management of non-state forests in protected areas in Slovakia”, Grant project 1/0495/22 “Sustainability of Value Supply Chains and its Impact on the Competitiveness of Companies in the Forest and Forest-Based Sectors” and Grant project 1/0306/24 “The quantification and development of Payment for water protection ecosystem services from forest”.
AUTHORS’ ADDRESSES
Ing. Marek Trenčiansky, PhD Assoc. prof. Ing. Rastislav Šulek, PhD. Technical University in Zvolen T.G. Masaryka 24 960 01 Zvolen, Slovakia trenciansky@tuzvo.sk sulek@tuzvo.sk
ACTA FACULTATIS XYLOLOGIAE ZVOLEN, 66(1): 161 172, 2024
Zvolen, Technická univerzita vo Zvolene
DOI: 10.17423/afx.2024.66.1.13
EXTERNAL DETERMINANTS OF FAMILY BUSINESS BEFORE AND DURING CORONACRISIS IN SLOVAKIA
Martin Halász – Mariana Sedliačiková – Andrea Janáková Sujová –Jarmila Schmidtová
ABSTRACT
The aim of this paper is to identify significant differences in barriers in the segment of family-owned woodworking and furniture enterprises in Slovakia before and during the COVID-19 pandemic, based on an assessment of the current state of family-owned enterprises in Slovakia. Our objective was to gain an up-to-date perspective on family businesses concerning external barriers that directly affect family businesses through a questionnaire survey. The established hypotheses were tested using statistical methods: analysis of variance, Interval estimation of relative abundance, and Duncan's post-hoc test. Based on the findings obtained by the questionnaire, it was found that there are significant differences in importance between the barriers of the external micro and macro environment before and during the COVID-19 pandemic. The results contribute to science and practice and open possibilities for further research in the sector of Slovak woodworking and furniture family businesses.
Keywords: woodworking and furniture enterprises; family business; external barriers; pandemic; COVID-19.
INTRODUCTION
Family business is a prevalent way of doing business globally, which has a long tradition and represents an important field of industry in Slovakia with high potential. In the country, family businesses (FBs) account for 30 to 40% of GDP and provide employment to more than 40% of the population (Sharma, 2004). However, looking at family businesses from an EU perspective, we find that RPs provide employment for up to 60% of the population in EU member states (Sharma, 2004). Family businesses have not been anchored legislatively in Slovakia despite their demonstrable importance. A turning point in the development and support of FBs in Slovakia occurred in 2022 when a draft amendment to Act No. 112/2018 Coll. was submitted and adopted on 30 September 2022. No. 112/2018 Coll., 2022). The amendment to the Act entered into force on 01 July 2023, which made it possible to proceed to the address registration of the FB This step will help economic development through targeted support and help the professional and academic community pursue adequate targeted research. Based on the adoption of the amendment above to the Act, an FB is defined as: a company, cooperative or natural person (entrepreneur) where at least two members of the joint family exercise directly or indirectly a majority of voting rights; one member of the joint family is a statutory body or a member of the statutory body;
two members of the joint family benefit economically from the business by a total of more than 50% of the after-tax profit; one member of the joint family is in an employment relationship with the natural person – entrepreneur who manages the business (Act No. 112/2018 Coll., 2022).
FBs bringmanyadvantages as well as disadvantages thatthefamily membersinvolved need to be aware of, heed and be able to work with. The main support in FB is the family itself. Family members can help and support each other to have better and more cohesive relationships, complemented by a fair amount of honesty and discretion in managing their business (Frank et al., 2023). However, the downside can easily become individual ambitions, damage to the reputation of the business, dealing with generational change along with property succession and a host of other things (Fondati et al., 2014). Thus, family businesses can be characterized as complex systems characterized by their interconnectedness between family and business, with a constant balance to be sought between the two (Koráb, 2008; Machek, 2017).
The history of FBs in Slovakia is linked to many traditional crafts. The production of leather products, musical instruments, and woodwork is typical in Slovakia. The woodworking industry, in conjunction with the furniture and pulp and paper industries, represents an important part of industry in Slovakia that has high potential (Antov et al., 2020). It is linked precisely to the fact that the Slovak Republic has wealthy sources of raw wood material, and a well-preserved and maintained nature. In spite of this, Slovak woodworking and furniture companies have faced a relatively long-standing stagnation in terms of innovation and investment. Most of the machinery and equipment used by the companies are outdated or do not meet many modern standards that have long been in place in other countries (Landscheidt, Kans, 2019). In today's dynamic world, innovation has become a driver that businesses must continuously work with, provided they want to move forward and improve their economic performance (Torun, 2007).
However, recent years have brought a new threat to both family and non-family businesses. The advent of a pandemic situation for business has meant enormous economic damage that many businesses have been unable to overcome. The impossibility of production due to the measures introduced and the number of changes to which businesses had to react suddenly caused considerable confusion for entrepreneurs. Family businesses were thus forced to concentrate more than ever on their survival and resist outside pressure. As a result of these changes, it has become essential for FBs to have a thorough understanding of their internal as well as their external environment, which has an impact on their performance, competitiveness and long-term sustainability (Halalisan et al., 2020).
As stated by Maqin et al. (2017), the entrepreneurial environment is influenced by the determinants of the internal environment (management, finance, human resources, marketing, research and development), the external macro-environment (political and legal, economic, demographic, socio-cultural, technological, informational, ecological) and the external micro-environment (customers, suppliers, intermediaries, competitors, public). Every enterprise operating in a market economy is influenced by these groups of determinants (Hernández et al., 2020). Most of the determinants of the external environment are immutable from the point of view of the involved enterprise (e.g. tax burden, legislative norms, etc.) or partially mutable (internal attitude towards competition, competitiveness) (Abdulaali et al., 2019), and the EU member states are trying to eliminate their negative impact with regard to the barriers to the development of the enterprises themselves (Bragaru, 2015, Ionescu et al., 2011).
External barriers represent the most significant threat to the company due to their impact on the company They are not directly controllable, and they are often changed what greatly complicates efforts to regulate, adapt and mitigate them. The economic barriers of a company directly affect its financial situation (Curran, 2007; Kadocsa et al , 2011). In times of crisis, it becomes necessary for the company to perceive the national economy of the country in which it operates, as well as the global economic situation. Pindiche et al. (2013) pointed out that the political situation can very quickly become one of the most significant barriers in business, because it directly affects the company's business activities. Expectations, beliefs, pressures, habits, traditions or desires of society affect the sociocultural side of the company and thus create another new barrier (Papula et al., 2015). Demographic changes in the country affect individual regions, what is subsequently reflected in the offer of goods and services. A company's competitiveness is also determined by its ability to invest and progress further. For this reason, technological and informational barriers are the base with which it is necessary to work, in the form of continuous implementation of new technologies, procedures and methods. Innovation cycles and activities in this sphere are directly related to ecological barriers, which have become more and more apparent in recent years. The company must work with the ecological standards of the state in which it operates and reconsider the implementation of measures that will go beyond the standards (Remišová et al., 2015).
The aim of the present paper is to identify the significant external determinants of the macro- and micro-environment affecting entrepreneurship in the woodworking and furniture family business segment in Slovakia before and during the COVID-19 pandemic.
MATERIALS AND METHODS
The methodological approach of this paper was distributed among several logically organized parts. In the first stage, an analysis of secondary sources was carried out, which focused on the issue of FB in the context of the wood processing sector in Slovakia. In this part, the methods of analysis, synthesis, summarization, description, comparison, deduction and analogy were used. The following hypotheses were formulated based on the findings on family business, the COVID-19 pandemic and the external factors that affect the business of woodworking and furniture RPs in Slovakia (WWAFI):
H1: It is hypothesized that an unfavorable business environment was a key external barrier to the woodworking and furniture family businesses prior to the pandemic in terms of the macro environment.
Since its inception in 1989, family business in Slovakia has been significantly impacted by economic barriers. One of the most notable is the unstable business environment, a challenge that affects the operation of all businesses. Hošták (2011) stresses that the state is often unaware of the consequences of its interventions in entrepreneurship. This often leads to a high administrative burden on businesses, difficult law enforcement and poorly formulated legislation, all of which discourage entrepreneurs and potential entrepreneurs from engaging in business and its development.
H2: The country's unfavorable economic situation is believed to have been a critical external barrier to the macro-environment of woodworking and furniture family businesses during the pandemic.
A well-functioning economy is crucial for sustaining and developing business. However, during the pandemic, the economy sharply stagnated. As Curran (2007) states, when looking at the economic situation as a barrier, we must realize that we cannot only
work with the situation in a given country but also need to consider the influences currently taking place in the global world economy.
H3: It is hypothesized that customers were a key external barrier to the business of woodworking and furniture family businesses prior to the pandemic from a microenvironmental perspective.
Customers are an existentially important part of a business. They generate revenue for the business, which is used to keep them satisfied and provide additional products and services. In the work, the author Remišová et al. (2015) stated that maintaining customer satisfaction is crucial for an enterprise. Thus, it is evident that an enterprise must make sure that it focuses mainly on satisfying its customer's need. In orderto succeedin this, it is forced to knowtheseneeds thoroughly andto beableto adjust thefurtheroperationoftheenterprise according to them.
H4: It is hypothesized that the key external barrier to woodworking and furniture family businesses during the pandemic from a microenvironmental perspective was the public.
Pindiche et al. (2013) define the public as a specific group of people who have any interest or intention to influence a company in a certain way. Thus, the public can directly influence the achievement of corporate objectives. During the pandemic, there was a huge demand for health and hygiene supplies. In practice, however, meeting such a high demand proved impossible. Thus, the public began to directly influence specific brands of hygiene and health products, resulting in increased production (and prices) to meet the needs of their customers.
The next part of the research was mapping the problems in the practice of woodworking and furniture enterprises by questionnaire method, building on the theoretical knowledge obtained so far. The uniform form of the questionnaire contained 16 questions divided into three main sections. The first section of the questionnaire focused on the identification and characteristics of FBs operating in the woodworking industry. Family businesseswereidentifiedusing thenewdefinitionenshrinedin the2018amendment to Law 112. If a respondent representing a particular company confirmed any of the above conditions, his/her business was classified as a family business. The second section was designed to identify significant differences in external barriers in the woodworking FB segment before and during the COVID-19 pandemic. The last section focused on expressing the evaluative position of woodworking FBs regarding the management of the pandemic situation and the use of company resources. The questionnaire was hosted on the Google Questionnaires platform and distributed through emails between February 2023 and May 2023. According to Finstat (2022), 3573 enterprises were active in the woodworking and furniture industry. Our research sample consisted of 2,300 family businesses that were randomly selected and operated in the woodworking and furniture industry based on SK NACE (code C16 and C31). The questionnaire return rate we were able to achieve was 9.43%.
The third phase focused on processing the data collected through the questionnaire survey.MicrosoftExcel wasusedtoprocesstheresults,andthedatawerefurtherstatistically and mathematically tested using Statistica 12. The formulated hypotheses were also tested using statistical methods. The verification of the above hypotheses was preceded by a check of the minimum research sample (n), which serves as the main assumption that allows the generalization of the research results to the entire population. The test was conducted using the following test characteristics:
Where “ z ” is the standard normal deviate appropriate for the desired confidence level, “p” is an estimate of the population proportion, and “c” is the torelable error level. By applying the formula and then performing the calculation, it was found that 384 respondents (FBs) were needed for our research. Kandelová et al. (2010) point out that it is notenoughtoknowonlythesizeofallbusinessesinSlovakia.Still,forthepurposeoffurther research,itisnecessarytocalculateacorrectionrelatedtobusinessesinSlovakia.Toachieve this correction, the following formula was used:
The variable "n" is the sample size without considering the population, the variable "pop" expresses the population size (Kandelová et al., 2010). The internal consistency of the questionnaire was verified using Kronbach's alpha coefficient, which is used as a scientific tool in inquiry methods. The formula (Cronbach, 1951) was used to calculate it:

All Cronbach's alpha values equal to or greater than 0.7 indicate sufficient reliability of the questionnaire. To test hypotheses H1 to H4, Interval Estimation of Relative Abundance Proportion was used. This interval provides a numerical range that tells us whether the estimated parameter falls in our base set with a certain probability. The interval is expressed by the following formula (Ali and Bhaskar 2016):
Where "" represents the significance level, "" is estimation error, "z" is the critical value of standard normal distribution, "��" is the estimated population’s frequency, "n" is the samplesize and "p" is the samplefrequency (Pacáková et al.,2009). Thesecondmethodused to test thehypotheses was theAnalysis ofVariance (ANOVA),which allowedus to compare means when two or more base sets were compared. Therefore, it can be determined whether the null hypothesis can be accepted or rejected (Pacáková et al.,2009). The test characteristic F is expressed by the formula:
MSA represents the mean square model for factor A, MSE represents the mean square error for random factor E, SSA is the sum of between-group variation, SSE is the sum of within-group variation, and the k - 1 and n - k relationships are the individual numbers of degrees of freedom (Pacáková et al., 2009). Duncan's post-hoc test directly followed the Analysis of Variance. Using it allowed us to see specific differences between pairs of means. A statistically significant difference is confirmed provided the following formula:
The parameter Da represents the Duncan test value for a given number of differences, Sr 2 expresses the residual variance, "n" is the ensemble size, and Yi, Yj are the group means
(Kucuk et al., 2016). The detailed results of the questionnaire are described in the next section of the paper.
RESULTS AND DISCUSSION
A total of 443 family businesses operating in the woodworking and furniture industry, according to the SK NACE classification (C16, C31), participated in the questionnaire survey. At the same time, the questionnaire survey managed to involve FBs from all municipalities of the Slovak Republic. The FBs were selected randomly from a pre-acquired database of Slovak family businesses (FINSTAT, 2023) with the condition that they identify themselves as an FB according to the newly adopted definition of the RP in Slovakia valid from 1 January 2023. Most respondents indicated that their family business was classified as either a micro business (35.48%) or a small business (46.65%). Most operate as a limited liability company (57.57%) or as a sole proprietorship (36.48%). Their most common age is 6 – 15 years (43.67%) and 1 - 5 years (27.29%). They are mainly engaged in local business (35.73%) and district business (21.59%), while they mostly come from the Bratislava region (22.30%) and the Banská Bystrica region (19.60%). Their business sector is mainly focused on trade (25.80%) and accommodation and catering services (20.60%). The presented research worked with a margin of error of 5% (e=0.05) along with a confidence level of 95% (z=1.96), while the sample size (N=3573) was known to us. Based on the previous data, the minimum research sample was calculated to be 384 Slovak family businesses operating in the WWAFI sector. A total of 443 respondents participated in the survey, thus, the condition of the minimum research sample was met, and the results can be generalized to the entire base set, i.e., to the entire population of enterprises operating in the woodworking and furniture sector. The high internal consistency of the scale used for the scaled items of the questionnaire is evidenced by the calculation of Cronbach's alpha with a value of 0.98.
Hypothesis H1 hypothesized that the key external barrier to woodworking and furniture family businesses prior to the pandemic in terms of the macro-environment was the existence of an unfavorable business environment, i.e., political-legal barriers. To test this, 95% interval estimates with 95% confidence intervals of the proportion of enterprises in the target population for which each external environment barrier was a key obstacle (Table 1) was calculated
Tab. 1 Interval estimates of barriers to the external macro-environment – pre-pandemic (95% confidence interval).
Economic barriers
Before the pandemic
(9% to 15%)
Political and legal barriers (11% to 18%)
Socio-cultural barriers
(17% to 25%)
Technological and information barriers (15% to 23%)
Demographic barriers
Ecological barriers
(17% to 25%)
(17% to 25%)
In Table 1, it was observed that the intervals with the highest frequencies, i.e., from 17% to 25%, were quantified for socio-cultural, demographic and ecological barriers. These categories represented key barriers for Slovak FBs operating in the woodworking and furniture industry. The assumption from hypothesis H1 that the key problem of FB in the pre-pandemic period in terms of the external macro-environment was the unfavourable business environment could not be confirmed. The results indicate that before the pandemic,
Slovak FBs operating in the woodworking and furniture sector focused more on demographic determinants, building a good communication base for customers in terms of the social aspect and ecology associated with social responsibility.
Hypothesis H2 was related to external macro-environmental barriers during the pandemic. It hypothesized that poor economic conditions, i.e., economic barriers, were a key external barrier to woodworking and furniture FBs during the pandemic period.
Following an interval estimate of the proportion of businesses in the target population with 95% confidence, it was found that political-legal barrier is the most frequent, with estimates ranging from 32% to 41% of businesses, and differing only slightly from the other barriers (Table 2).
Tab. 2 Interval estimates of barriers to the external macro-environment – during the pandemic (95% confidence interval).
During the pandemic
Economic barriers (32% to 41%)
Political and legal barriers (33% to 42%)
Socio-cultural barriers (31% to 40%)
Technological and information barriers (31% to 40%)
Demographic barriers (24% to 33%)
Ecological barriers (25% to 33%)
The estimate was quantified at 32% to 41%. for our expected economic barriers. Socio-cultural and technology-information barriers can also be considered significant, ranging from 31% to 40%. It was confirmed hypothesis H2 based on the above. The phenomenonoffamily business is deeply rootedin moderncountries’economies.Therefore, FB can be considered a driving force of the economy, which should dynamically progress in all circumstances. A glimpse of this progress can be seen in Table 1, where, during the pandemicsituation, businessesshifted theirgazefrom thesocio-cultural aspect, demography and ecology to the most fundamental – survival, symbolised by a focus primarily on the politico-legal and economic barriers that the RPs were forced to overcome.
Hypothesis H3 posits that customers were the key external barrier to woodworking and furniture FBs prior to the pandemic from a microenvironmental perspective. Table 3 presents how people perceived the importance of individual external microenvironment barriers fom the pre-pandemic period.
Tab. 3 Interval estimates of barriers to the external microenvironment – pre-pandemic (95% confidence interval).
Before the pandemic
Customers (11% to 18%)
Suppliers (11% to 18%)
Intermediaries (12% to 19%)
Competitors (12% to 19%)
Public (10% to 17%)
Our assumption worked with a customer barrier (11% to 18%) that differs only marginally from themostnumerous estimates: intermediation andcompetitionbarriers (12% to 19%). Thus, hypothesis H3 was confirmed, woodworking and furniture FBs perceived the customerbarrier as significant beforethepandemic. It canbeprimarily dueto thecontinuous development ofthebusiness, competitivepressures andthedesireto take as strongaposition as possible in the market, with the key in this case being a satisfied customer. Hypothesis H4 was rejected. The public is seen as the key external barrier to the business of woodworking and furniture FBs during a pandemic in terms of the macro environment.
Tab. 4 Interval estimates of barriers to the external microenvironment – during a pandemic (95% confidence interval).
During a pandemic
Customers (31% to 41%)
Suppliers (34% to 44%)
Intermediaries (27% to 36%)
Competitors (30% to 39%)
Public (29% to 38%)
Although 29% to 38% of Slovak FBs perceived this barrier as the most significant, it could not be accepted because the most numerous estimate, in this case, was the barrier of suppliers, i.e., 34% to 44%, together with the barrier of customers, i.e., 31% to 41%, as presented in Table 4.
The above overview of barriers before and during the pandemic period shows their strong influence on the functioning of Slovak woodworking and furniture enterprises, especially during the pandemic period. This increase can again be attributed to the fact that during the pandemic, family-owned enterprises tried to focus primarily on survival, which ensured that they strengthened good business relations with their suppliers and maintained a good reputation and image in the eyes of their customers.
Ifwelookat thequestionnairesurvey results,wecanseethatthepandemic hasbrought significant differences in the perception of barriers to family business (Kraus, 2020). According to the author Ward (2016), family businesses represent a space that is agile enough to withstand any crisis situation, provided the use of proper and controlled management of the FB, the existing stability in the family and the use of the advantage of solid financial security (Azizi et al., 2021) The pandemic brought chaos to businesses, and businesses were unprepared. The results of this research highlighted that family as well as non-family businesses were forced to think differently during the pandemic. Herman and Nistor (2021) argue that during the pandemic, businesses were in a state where they were either able to direct all their resources and efforts towards maximizing the possibility of survival or the businesses failed to cope with the impacts that the pandemic created, which brought them significant damage. The woodworking and furniture sectors were also quite severely constrained. The impossibility of extraction and production, the forced shutdown of machinery and equipment, the high costs of paying employees who could not work and the subsequent lay-offs caused a considerable imbalance. The situation has profoundly shaken supply chains, resulting in disrupted relationships. However, family businesses have gone through many challenges over the years, which they have overcome successfully. In orderto withstandtheadversity, RPs havehadto refocus theirattentionveryquicklyonwhat is important in business. According to Habánik et al. (2016), problems such as: administrative burden on businesses, difficult law enforcement and poorly formulated legislative regulations were significant obstacles to entrepreneurship, which could not be confirmed in our research (hypothesis H1 was rejected). In a relatively calm market environment, businesses can develop in a direction that suits them or they choose. As Pakkanen (2012) stated, a business must constantly work with its internal and external environment. The environment of the enterprise is the most important variable that influences it and determines its survival. An enterprise cannot afford to be idle if there is an unpredictable economic situation. Still, it must monitor external macro-influences in the world economy and its environment (Curran, 2007). In terms of the results of the questionnaire survey, this position was confirmed (hypothesis H2 was accepted as valid). However, as one of the market actors, a business, could not function if it had no one to offer its products and services to. Thus, customers become a significant factor for the enterprise,
enabling it to move forward. According to the author Banuelas (2002), customers are a key component of the enterprise and play a fundamental role in its functioning and success, which it was able to confirm by adopting hypothesis H3. However, from an external microview of the enterprise, it cannot be precisely determined that only one determinant is the most important. Based on the results of our research, all barriers to the external microenvironment are proportionally equally important in the pre-pandemic period. Authors Jasra (2011) and Maqin et al. (2017), state that it is essential to be aware of the barriers in question and their impacts, which have been critical to the long-term sustainability of FB over many generations. This statement is underlined by Neykov et al. (2021), who state that enhancing management practices and investing in research and development activities can lead to greater economic efficiency and long-term sustainability. The sudden change in the situation brought about by the pandemic resulted in significant upheaval in all areas of people's social lives. People began to become more and more vocal, causing businesses to respond very quickly and flexibly to what the public was demanding. However, businesses only vaguely understood all the pitfalls that the pandemic situation would bring. In a short time, they had to secure and strengthen their relationships with suppliers and customers, as our research has shown (hypothesis H4 was rejected). Despite the pandemic, the FBs managed to cope with the situation and thus strengthened their business by finding new strategies. Therefore, by implementing the right strategy in the industry, we can eliminate and mitigate many undesirable influences. Finally, regular monitoring of the international and national macro and microenvironment as well as the company's anticipation of possible market changes are fundamental steps that family businesses should take to avoid the most significant external barriers.
CONCLUSION
A properly set-up enterprise and carefully monitoring its internal and external environment are the keys to ensure the survival of Slovak woodworking and furniture family businesses. The pandemic has brought new challenges to the local, national, and global levels that the enterprise has to face. This period brought many uncertainties, trials, an uncertain future, and many opportunities for adaptation and growth. Businesses had to find new ways to communicate, collaborate, and manage the situation. A capable business can cope with and overcome the crisis through consolidation and a thorough understanding of its external macroandmicroenvironment. Astheresearchresults showed us, thesignificance of individual barriers in the family business changes with the rapid change of the situation. FBs have to consider very wisely what they will and will not give priority to. Complicating matters in this case may be the need to accommodate the family on the one hand, the customers on the other, and the goals set by the business on the third. The agility of the enterprise as a permanent ability to be flexible and prepared for different scenarios that may arise has become more severe than ever. The challenges associated with the pandemic remind us how important it is to have strong values, a culture, and the right strategy in the FB sector to withstand the unexpected. At the same time, family businesses have an opportunity to focus on social responsibility and strengthen their relationships with other businesses and the community, which can create a massive advantage in the future. Thus, family businesses should strive to continuously remove barriers that could burden the business in a crisis.
A limitation (restriction) of the research presented is that the results cannot be generalized to all SMEs (micro, small, and medium enterprises) in the country. Still, the
research is only relevant to family businesses in the woodworking and furniture industry. Another limitation is using a quantitative research method, which makes it possible to identify specific factors and barriers enterprises had to overcome during the Covid crisis. Further research will therefore focus on a qualitative study on the ability of family and nonfamily SMEs to cope with unpredictable changes and the barriers needed to build their agility.
REFERENCES
Abdulaali, A., Alnoor, A., Eneizan, B., 2019. A Multi-Level Study of Influence Knowledge Management inSmallandMedium Enterprises.PolishJournal of Management Studies [online], vol. 19, no. 1, pp. 21-31.
Act No. 112/2018 Coll. on Social Economy and Social Enterprises and on Amendments and Supplements to Certain Acts, as amended by Act No. 374/2019 Coll., Act No. 94/2020 Coll., Act No. 264/2020 Coll. and Act No. 113/2022 Coll.
Ali, Z., Bhaskar, S.B., 2016. Basic statistical tools in research and data analysis. Indian journal of anaesthesia, 60.9: 662.
Antov, P., Savov, V., Neykov, N., 2020. Sustainable bio-based adhesives for eco-friendly wood composites. A review. Wood Research. 65(1), 51-62.
Azizi, M., Bidgoli, M. S., Taheri, A., 2021. The effect of ownership and management structure on family businesses performance. Cogent business & management, 8(1), 1872888.
Bragaru, C., 2015. Small and medium enterprises (SMEs) - determinants for intelligent growth and sustainable development of local communities. Challenges of the Knowledge Society, vol. 1, no. 5. p. 641-651, ISSN 2068-7796
Cronbach, L.J., 1951. Coefficient alpha and the internal structure of tests. Psychometrika 16, 297334.
Curran, M., 2007. Family enterprises as an important factor of the economic development: the case of Slovenia. In Journal of Enterprising Culture, vol. 11, no. 2. p. 111 – 130, ISSN 1793-6330
Finstat., 2022 [WWW Document]. URL https://finstat.sk/databaza-firiem-organizacii
Fondati, M., Kováčová, Z., Pitoňák, D., 2014. Rodinné podnikanie alebo (ne)zostane to v rodine. Bratislava: Európske partnerstvo pre verejné stratégie (EPPP). 20 p.
Frank, H., Kessler, A., Beck, S., Suess-Reyes, J., Fuetsch, E., 2023. The enterpriseness of business families: Conceptualization, scale development and validation. Journal of Family Business Strategy, 14(2), 100522.
Habánik, J., Kordoš, M., Hošták, P., 2016. Competitiveness of Slovak economy and regional development policies. Journal of international studies, 9.1.
Halalisan, A. F., Nicorescu, A. I., Bogdan, P. O. P. A., Neykov, N., Marinescu, V., Abrudan, I. V., 2020. The relationships between forestry sector standardization, market evolution and sustainability approaches in the communist and post-communist economies: The case of Romania. Notulae Botanicae Horti Agrobotanici Cluj-Napoca, 48(3), 1683-1698
Herman, R., Nistor, C., 2021. Problems and survival strategies for companies during the COVID-19 crisis. Manager, 34: 60-68.
Hernández-Trasobares, A., Galve-Górriz, C., 2017. Diversification and family control as determinants of performance: A study of listed business groups. In European Research on Management and Business Economics, vol. 23, no. 1.
Host'ák, M., 2011. Stav a bariéry podnikateľského prostredia a hlavné odporúčania pre jeho ďalší rozvoj. [online]. Available on the Internet: <https://www.slideshare.net/maria_bulkova/martinhostak-20092011>
Ionescu, V.C., Cornescu, V., Druica, E., 2011. Small and medium enterprises in European Union. Journal of Business and Leadership, 2011, no. 1.
Jasra, J.M., 2011. Determinants of business success of small and medium enterprises. International Journal of Business and Social Science, vol. 2, no. 20, p. 274-280. ISSN 2219-1933.
Kadocsa, G., Francsovics, A., 2011. Macro and micro economic factors of small enterprise competitiveness. Acta Polytechnica Hungarica, vol. 8, no. 1, p. 23 – 40.
Koráb, V., 2008. Malé a střední rodinné podniky a perspektivy jejich rozvoje. Brno: Vutium. 25 p.
Kraus, S., Clauss, T., Breier, M., Gast, J., Zardini, A., Tiberius, V., 2020. The economics of COVID19: initial empirical evidence on how family firms in five European countries cope with the corona crisis. International journal of entrepreneurial behavior & research, 26(5), 1067-1092.
Kucuk, U., Eyuboglu, M., Kucuk, H.O., Degirmencioglu, G., 2016. Importance of using proper post hoc test with ANOVA. International journal of cardiology, 209: 346.
Landscheidt, S., Kans, M., 2019. Evaluating factory of the future principles for the wood products industry: Three case studies. Procedia manufacturing, 38: 1394-1401.
Machek, O., 2017. Family business. Prague: C. H. Beck. 160 p. ISBN 978-80-7400- 638-8. Maqin, R.A., Hendri, N., 2017. Comparative analysis: the effect of macro and micro environment on marketing strategy and marketing performance of small medium enterprises. International Review of Management and Marketing, vol. 7, no. 5, p. 70-76.
Neykov, N., Krišťáková, S., Hajdúchová, I., Sedliačiková, M., Antov, P., Giertliová, B., 2021. Economic efficiency of forest enterprises - Empirical study based on data envelopment analysis. Forests, 12(4), 462.
Pacáková, V., Labudová, V., Sipková, Ľ., Šoltés, E., Vojtková, M., 2009. Štatistické metódy pre ekonómov. Bratislava: Iura Edition spol. s. r. o., 411 p. Pakkanen, T M., 2012. Internal and external analysis. [WWW Document]. URL https://www.theseus.fi/bitstream/handle/10024/51954/Pakkanen_Tia-Maria.pdf;sequence=1 Papula, J., Hudáková, H., Papulová, E., Papula, J., 2015. Podnikanie a podnikateľské myslenie I. Bratislava: Wolters Kluwer. 240 p
Pindiche, E., Ionita, R., 2013. The influence of micro and macro environment components on trade companies in Romania. Journal of Knowledge Management, Economics and Information Technology, vol. 24, no. 12.
Remišová, A., Lašáková, A., Rudy, J., Sulíková, R., Kirchmayer, Z., Fratričová, J., 2015. Etické vedenie ľudí v slovenskom podnikateľskom prostredí. Bratislava: Wolters Kluwer. 164 p. Sharma, P., 2004. An Overview of the Field of Family Business Studies: Current Status and Directions for the Future. In Family Business Review 17, 1-36.
Torun, H., Cicekci, C., 2016. Innovation: Is the engine for economic growth. Ege University, 2007. Ward, J.,2016.Keepingthefamilybusiness healthy: How toplan forcontinuedgrowth, profitability, and family leadership. Springer.
ACKNOWLEDGMENT
This researchwassupported by Slovak ResearchandDevelopment Agency, projects number APVV20-0004, APVV-21-0051, APVV-22-0238, APVV-23-0116 and also, the paper is a partial result of the grant scientific projects VEGA no. 1/0011/24, VEGA no. 1/0333/22, IPA - Building agility in wood-processingenterprisesandIPA-Researchonthesustainabilityoffamilybusinessinthewoodprocessing and furniture manufacturing industry in Slovakia.
AUTHORS’ ADDRESSES
Ing. Martin Halász
prof. Ing. Mariana Sedliačiková, PhD. doc. Ing. Andrea Janáková Sujová, PhD. Technical University in Zvolen
Faculty of Wood Sciences and Technology, Department of Business Economics
T. G. Masaryka 24, 960 01 Zvolen, Slovakia
xhalasz@tuzvo.sk
sedliacikova@tuzvo.sk sujova@tuzvo.sk
Mgr. Jarmila Schmidtová, PhD. Technical University in Zvolen Faculty of Wood Science and Technology, Department of Mathematics and Descriptive Geometry
T.G. Masaryka 24, 960 01 Zvolen, Slovakia jarmila.schmidtova@tuzvo.sk